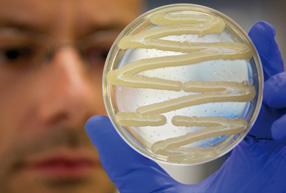

CENTRO RICERCA E INNOVAZIONE FONDAZIONE EDMUND MACH



il nostro mondo: in breve
+ Prefazione
+ La Fondazione Edmund Mach
+ Il Centro Ricerca e Innovazione
+ GMPF & Programmi Internazionali di Dottorato
la nostra ricerca: key subjects
part_1 Plants for the future / Introduzione
+ 1.1 Dalla genomica nuove opportunità nella coltivazione del melo
Autori / M. Troggio | S. Salvi | R. Velasco
+ 1.2 La resistenza sistemica indotta: un meccanismo naturale per la difesa delle piante
Autori / M. Perazzolli | M. C. Palmieri | B. Roatti | I. Pertot
+ 1.3 Lʼiperparassita Ampelomyces quisqualis riconosce la presenza del suo fungo ospite
Autori / L. Tosi | D. Angeli | I. Pertot | M. Maurhofer
+ Highlights
part_2 Food for life / Introduzione
+ 2.1 Nuove conoscenze sulla struttura degli ellagitannini del Rubus
Autore / U. Vrhovsek
+ 2.2 La qualità dellʼuva: quali le basi molecolari?
Autori / C. Moser | F. Emanuelli | S. Pilati | L. Costantini | J. Battilana | M. S. Grando
+ 2.3 I composti volatili del lampone: la chiave per un piacevole aroma ma non solo
Autori / E. Aprea | S. Carlin | F. Biasioli | F. Gasperi
+ 2.4 Nuovo metodo per limitare in cosmesi lʼuso di squalano da squali
Autore / F. Camim
+ 2.5 Grazie alla applicazione di un nuovo metodo di analisi è stata chiarita lʼorigine della nota speziata nei vini
Autore / F. Mattivi
+ Highlights
part_3 A sustainable world / Introduzione
+ 3.1 Il cambiamento climatico influenzerà le colture ma anche i loro patogeni
Autori / A. Caffarra | M. Rinaldi | E. Eccel | I. Pertot
+ 3.2 Flussi di carbonio ed indicatori ecologici degli ecosistemi delle foreste e dei pascoli sottoposti ai cambiamenti climatici
Autori / D. Gianelle | N. La Porta
+ 3.3 Ecosistemi alpini in un ambiente mutevole: sensibilità della biodiversità e potenziale adattativo
Autori / C. Vernesi | E. Eccel | N. Salmaso | R. Rosà | N. La Porta | A. Rizzoli | C. Varotto
+ 3.4 Sfide ed opportunità nello studio e gestione dei cambiamenti negli ecostistemi acquatici
Autori / N. Salmaso | L. Cerasino | M. Tolotti | B. Maiolini | C. Bruno
+ 3.5 Il paradosso delle foreste durante le ondate di calore
Autori / D. Gianelle | M. Sottocornola + Highlights
p. 07
p. 09
p. 10
p. 11
p. 12
p. 13
p. 15
p. 16
p. 18
p. 20
p. 22
p. 25
p. 26
p. 28
p. 30
p. 32
p. 34 p. 36
p. 39
p. 40
p. 42 p. 44
p. 46
p. 48 p.
part_4 Interactions in living systems / Introduzione
+ 4.1 Nella memoria delle api
+
+
+
+
+
Autori / G. Anfora | E. Rigosi | F. Trona
4.2 Vibrazioni al posto degli insetticidi per il controllo delle cicaline della vite
Autori / V. Mazzoni | A. Eriksson | G. Anfora
4.3 Ruolo dei segnali odorosi nei rapporti tra insetti fitofagi e loro piante ospiti
Autori / M. Tasin | C. Sicher | I. Pertot
4.4 Percezione, codifica ed interazione dei fenomeni sessuali e dei volatili delle piante in Cydia pomonella
Autori / F. Trona | J. Bengtsson | M. Tasin | G. Anfora
4.5 Global change e nuove zoonosi emergenti
Autori / A. Rizzoli | H. Hauffe | M. Neteler | R. Rosà | V. Tagliapietra
4.6 Uno sguardo nella vita degli animali: la tecnologia GPS applicata allʼecologia animale
Autore / F. Cagnacci
+ Highlights
la nostra ricerca: facts and figures
part_1 Il nostro Network Internazionale
part_2 Progetti di Ricerca
part_3 Eventi CRI
part_4 Tesi svolte presso FEM
part_5 Premi 09/10
part_6 Presenza in comitati editoriali
part_7 Pubblicazioni CRI
part_8 Organigramma
Sono lieto di presentare il primo rapporto annuale sulle attività condotte dal Centro di Ricerca e Innovazione (CRI) della Fondazione Edmund Mach, costituito il 1°gennaio 2009 attraverso lʼintegrazione delle attività del Centro Sperimentale Iasma e del Centro di Ecologia Alpina delle Viote di Monte Bondone. Il CRI intende rappresentare per la comunità trentina una fonte di conoscenza, idee e proposte innovative finalizzate alla crescita economica ed allo sviluppo sostenibile. Pur mantenendo una mission fortemente orientata al proprio territorio, il CRI intende proiettarsi, confrontarsi e misurarsi a livello internazionale recependo la globalità della dimensione della ricerca e la necessità di inserirsi a pieno titolo nella comunità scientifica internazionale. È per questo che nel primo anno di attività uno degli eventi più significativi ha riguardato lʼattivazione del programma internazionale di dottorato in Genomica e Fisiologia Molecolare delle Piante da Frutto (GMPF), unʼiniziativa caratterizzata dalla compartecipazione di oltre 17 istituzioni internazionali provenienti dai 5 continenti.


Il mio invito è quello di sfogliare le pagine che seguono per approfondire in dettaglio risultati ed attività nei settori strategici Agricoltura, Alimentazione e Ambiente che caratterizzano lʼambizioso e rilevante programma di ricerca del CRI. Un programma reso possibile dallʼinstancabile lavoro di circa 230 collaboratori e dalla disponibilità di 30 ettari di campi sperimentali ed oltre 6.000 m2 tra uffici e laboratori attrezzati con le tecnologie più allʼavanguardia, nonché dalla quotidiana interazione e sinergia con università e centri di ricerca in tutto il mondo.
Sperando che il lettore trovi in questo rapporto una fonte completa ed esaustiva di informazioni, per le quali siamo comunque disponibili a fornire in ogni momento ulteriori approfondimenti a quanti vorranno mettersi in contatto con noi, a nome di tutto il CRI non mi resta che augurare una buona lettura!


Per risollevare le sorti dellʼagricoltura dellʼallora Tirolo meridionale, il 12 gennaio 1874 la Dieta tirolese di Innsbruck deliberò di attivare presso il monastero agostiniano di San Michele allʼAdige una scuola agraria. Lʼattività iniziò quello stesso autunno secondo lʼimpostazione data dal primo direttore, Edmund Mach: capace organizzatore, egli sin dagli albori sostenne con convinzione il progetto di qualificare lʼistituto come una struttura innovativa in cui didattica e ricerca potessero sinergicamente contribuire allo sviluppo agricolo del territorio.

Dopo la Prima Guerra Mondiale lʼIstituto Agrario di San Michele (IASMA) passò sotto lʼegida del governo italiano che a sua volta lo fece rientrare nelle competenze della Provincia autonoma di Trento.
Nel 1990 la Legge Provinciale n. 28 formalizzò la trasformazione di IASMA in ente funzionale della Provincia autonoma di Trento, integrando anche le attività di servizio al territorio nel preesistente impianto basato su formazione e ricerca.
LaDal 1°gennaio 2008 le strutture e le attività dellʼIstituto sono transitate nel nuovo soggetto giuridico rappresentato dalla Fondazione Edmund Mach (FEM): un ente di interesse pubblico con personalità giuridica di diritto privato previsto dalla legge di riordino della ricerca (L.P. 2 agosto 2005, n.14). Nella FEM i 3 centri ereditati da IASMA sono stati caratterizzati da una struttura organizzativa più flessibile e funzionale agli specifici obiettivi di Istruzione e Formazione, di Ricerca e Innovazione e di Trasferimento Tecnologico che, oltre a qualificarne le nuove denominazioni, rappresentano gli aspetti più salienti delle rispettive mission.
Dal 1°gennaio 2009 il Centro Sperimentale FEM si è dotato di una nuova struttura organizzativa ed ha cambiato il proprio nome in Centro Ricerca e Innovazione (CRI). Le attività dei preesistenti Dipartimenti e del Centro di Ecologia Alpina sono conseguentemente confluite in Aree di ricerca specializzate negli ambiti di Area Genomica e Biologia Vegetale, Area Qualità Alimentare e Nutrizione, e Area Ambiente e Risorse Naturali.
Nello specifico lʼArea Genomica e Biologia Vegetale, si prefigge di offrire un contributo al miglioramento genetico delle specie ed alla costituzione di nuove varietà di interesse commerciale, attraverso ricerche che si estendono dalla genomica funzionale alla genetica molecolare applicata ed allo studio delle interazioni pianta/patogeno.
LʼArea Qualità Alimentare e Nutrizione si concentra sulla valorizzazione qualitativa, tecnologica e nutrizionale dei prodotti agroalimentari, attraverso lo studio delle potenzialità inespresse di piante di interesse agrario per la salute umana, lʼapprofondimento dei meccanismi sensoriali di percezione degli alimenti e lo sviluppo di modelli innovativi per la tracciabilità degli alimenti.

Attraverso ricerche di base ed applicazioni pratiche, lʼArea Ambiente e Risorse Naturali affronta questioni di estrema attualità come il cambiamento climatico e il mantenimento della biodiversità, integrando lʼelaborazione di modelli teorici con azioni di monitoraggio territoriale.
Ogni Area al suo interno si articola in Programmi di attività basati su progetti di ricerca e piattaforme tecnologiche innovative nei campi della biologia
computazionale, metabolomica, genomica funzionale, analisi isotopiche, analisi climatiche, GIS e remote sensing.
Strutture allʼavanguardia, un ambiente giovane e dinamico, la presenza di ricercatori di provenienza estera, le collaborazioni con università ed istituti di tutto il mondo, lʼavvio di iniziative di formazione specialistica di alto livello collocano il Centro in un contesto globale, favorendo lo scambio di idee e lo sviluppo di innovazione, con risultati riconosciuti a livello internazionale.
Forte di queste caratteristiche il CRI si pone come un riferimento autorevole nella produzione di conoscenza, nella promozione di innovazione e di concrete ricadute per il territorio. Requisiti, questi, indispensabili per incentivare lo sviluppo di una economia sempre più basata sulla conoscenza e per sostenere una crescita socio-economica duratura e di qualità.
Tra le iniziative promosse dal CRI nel 2009 trova una collocazione di primʼordine il Programma Internazionale di Dottorato in Genomica e Fisiologia delle Piante da Frutto (GMPF), che offre programmi di studio e ricerca di alto livello in un contesto di collaborazione scientifica nazionale ed internazionale tra i dottorandi e le istituzioni aderenti.
Il GMPF è il primo esempio italiano di un programma altamente qualificato per formare addetti di ricerca in grado di sviluppare in Europa una frutticoltura più sostenibile e competitiva. Una struttura allʼavanguardia, che vede accanto al CRI la collaborazione di altre 17 istituzioni collocate in tutto il mondo: dallʼUniversità di Trento alla Washington State University (USA), dal Plant and Food Research Institute di Palmerston North (Nuova Zelanda) allʼUniversità di Bologna, dal Plant Research International di Wageningen (Olanda) alla University of Stellenbosch (Sud Africa) ed alla Hebrew University of Jerusalem (Israele).
Al termine del loro percorso di studio e ricerca gli studenti del GMPF potranno vantare un curriculum dʼeccellenza negli ambiti della genomica, bioinformatica, genomica funzionale, proteomica e metabolomica, genetica, miglioramento genetico e fisiologia molecolare delle specie arboree da frutto. Proprio a questi ambiti il CRI conferisce il valore aggiunto di unʼesperienza decennale e riconosciuta in tutto il mondo, maturata nel tempo attraverso una politica di ricerca attenta alle aspettative del mondo dei consumatori e della produzione.
A partire dal 2010 il CRI ha lanciato unʼaltra iniziativa denominata “International Phd Programme” (IPP). Ogni anno saranno conferite una decina di borse di dottorato su tematiche quali le agro-bioscienze, le scienze dellʼalimentazione, lʼecologia terrestre ed acquatica, le risposte degli organismi ai cambiamenti climatici, lʼagrobiologia e lʼecobiologia.
part_1 Plants for the future
part_2 Food for life
part_3 A sustainable world
part_4 Interactions in living systems
elaboraret ne nec, error omnes pericula ad usu.
Nuove conoscenze e tecnologie per migliorare lʼAgricoltura di domani
1part_
Agricoltura sostenibile, necessità di ottenere una elevata qualità pur mantenendo alta la produttività, redditi minacciati dalle congiunture internazionali e dalla concorrenza globale: questi ed altri temi inquietano il mondo agricolo del nuovo millennio.
Una soluzione, almeno parziale, arriva dalla crescita esponenziale di conoscenza e dal costante miglioramento delle tecnologie applicate alla creazione e alla gestione di tale conoscenza.
Il ventunesimo secolo è iniziato con lʼannuncio del sequenziamento del genoma umano e da allora in pochi anni sono stati identificati i genomi di centinaia di organismi, non solo procarioti ma anche eucarioti. Ad oggi oltre una decina di piante sono state sequenziate con risultati di elevata qualità. Di queste ben 4 sono piante da frutto.
In Trentino abbiamo puntato moltissimo su questi contributi alla conoscenza, dapprima per stimolare interesse e poi per ottenere applicazioni importanti nel miglioramento genetico delle piante di maggior interesse (vite, melo, fragola, lampone). Tra il 2007 ed il 2010, i genomi di vite, melo e fragola sono stati depositati nelle banche dati mondiali, anche con un importante contributo della FEM.
Siamo di fronte ad un nuovo paradigma nella ricerca applicata: la conoscenza di base su queste piante non è più il collo di bottiglia. Ora è possibile pensare a credibili piani di miglioramento genetico e allʼottenimento di nuovi genotipi ad alto valore aggiunto.
Lʼagricoltura ha una grande chance di cambiamento, è il momento di lavorare sulla pianta!
Lʼagronomia continuerà a fornire fondamentali istruzioni su come gestire al meglio le colture, ma la conoscenza di base fondata sui genomi aiuterà nei prossimi anni produttore e consumatore a trovare importanti risposte: piante che tollerano i propri patogeni fino al punto di resistervi, piante che richiedono un intervento minimo dellʼuomo (con risparmio di tempo, denaro e fatiche, impensabili fino a pochi anni fa), piante che garantiscano un reddito grazie allʼinnegabile qualità ed originalità del prodotto ma che al contempo offrano una elevata qualità nutritiva.
Allʼesperienza di campo del coltivatore e del produttore e alle tecniche agronomiche più sofisticate si aggiungeranno nuove opportunità di scelta. Sarà possibile fare una caratterizzazione territoriale e di prodotto, con un limitato intervento dellʼuomo e nel rispetto dellʼambiente, andando ben oltre le più rosee previsioni.
1600
Ilmelo è la pianta da frutto più diffusa nei climi temperati, largamente dominante nella nostra regione. La necessità di conoscere maggiormente la sua biologia e lʼopportunità di capitalizzare le esperienze accumulate con lʼattività svolta nella genomica della vite ha portato alla realizzazione della decodifica del genoma del melo. Ci si è concentrati sulla varietà Golden Delicious, tra le prime tre più coltivate al mondo, in assoluto la più diffusa in Italia ed in Trentino. Il nostro obiettivo primario è stato raggiunto con il sequenziamento completo del genoma di Golden Delicious, realizzato nellʼambito di un consorzio di istituti di ricerca ed università di tre continenti, Europa, Nord America e Oceania.

Lacopertura complessiva di 17 volte il totale del genoma ha consentito la stima delle sue dimensioni (742,3 milioni di basi). Il totale della sequenza è costituito da circa 1.600 scaffolds (frammenti di cromosomi), copre circa 603 milioni di basi e rappresenta oltre lʼ81% del genoma. Lʼancoraggio del 72% del totale è stato ottenuto tramite 1.643 marcatori molecolari (tipo SSR e SNP) distribuiti lungo i 17 cromosomi, lungo circa 1.130 cM. Dalle analisi del genoma emerge in particolare lo straordinario numero
il
Essi coprono circa 603 milioni di basi, oltre lʼ81% del genoma
di geni, oltre 57.000, dove spiccano ad es. i fattori di trascrizione (oltre 4.000) ed i geni correlabili alle resistenze a patogeni (circa 1.000). Oltre il 90% di questi è stato assegnato ai cromosomi ed ordinato. I cromosomi attualmente presenti nel genoma sono il prodotto di una duplicazione relativamente recente (35-50 milioni di anni). Essa ha portato a 17 il numero dei cromosomi delle specie botanicamente classificabili nella tribù delle Pyreae (melo, ma anche pero, cotogno e sorbo) partendo da un numero di cromosomi pari a 7-9 normalmente presenti nelle altre Rosaceae (pesco, 8; fragola, 7; Spireae e Gillenia, 9).
Lʼanalisifilogenetica di tali sequenze ha permesso di chiudere unʼaccesa discussione sulla filogenesi del genoma delle Pyreae, nella quale ci si chiedeva se i 17 cromosomi attuali sono il risultato di un evento allopoliploide (con una fusione tra due genomi di 9, Spi-
reae-like e 8, Prunus-like) oppure di un evento di autopoliploidia (Gillenia-like, 9). I nostri dati supportano questʼultima teoria ed hanno inoltre permesso di identificare il più vicino antenato selvatico del melo coltivato. Porzioni del genoma di 74 diversi genotipi di melo sono stati risequenziati e confrontati a livello nucleotidico. Da queste analisi è emerso in maniera univoca che il contributo di M. sylvestris (europeo) al melo coltivato è quasi nullo e che invece il M. sieversii (centroasiatico) è praticamente indistinguibile da M. x domestica
Diimportanza fondamentale è lʼidentificazione nel genoma della cultivar Golden Delicious di numerosissimi marcatori molecolari, prevalentemente di tipo SNP (polimorfismi a singolo nucleotide).

Tali SNPs (circa 3.000.000) forniranno un arsenale di marcatori molecolari estremamente potente per aiutare i ricercatori a chiarire le
basi genetiche dellʼereditarietà dei caratteri di interesse agronomico e della qualità del frutto, in modo da consentire una più rapida ed efficace attività di miglioramento genetico.
Gliattuali obiettivi del miglioramento genetico riguardano la produzione di varietà resistenti ai patogeni fungini, batterici e da fitoplasmosi e lʼincremento delle caratteristiche nutrizionali e salutistiche del frutto, in combinazione con caratteristiche pomologiche di pregio, come elevata croccantezza e serbevolezza.
Per lʼidentificazione di sorgenti di variabilità genetica utile al miglioramento genetico è inoltre in via di completamento una vasta collezione di germoplasma, consistente in più di 1.200 cultivar di melo.
Lepiante interagiscono con le varie componenti dellʼagro-ecosistema. Di conseguenza sono in grado di percepire segnali di pericolo e/o stress e di reagire mediante lʼattivazione di processi di difesa. Le piante non sono dotate di un vero e proprio sistema immunitario, ma hanno sviluppato nel corso dellʼevoluzione complessi sistemi di difesa per contrastare i patogeni. Un particolare meccanismo è quello della resistenza sistemica indotta (ISR), che consiste in un sistema preventivo di difesa, innescato in seguito al contatto con specifici microrganismi benefici e attivo contro numerosi patogeni.
Ilnostro obiettivo è quello di valutare lʼefficacia dellʼISR nella vite contro il patogeno Plasmopara viticola e di caratterizzarne il meccanismo di attivazione per selezionare in futuro induttori di resistenza più efficienti. Il trattamento della vite con alcune specie del genere Trichoderma o con molecole naturali a base proteica consente di ridurre in maniera significativa i sintomi della peronospora sulle foglie. In condizioni controllate in serra, il
è un metodo a basso costo per il controllo della peronospora della vite

trattamento con T. harzianum T39 possiede unʼefficacia comparabile a quella ottenuta con fungicidi (rame).
di T. harzianum
T39 sulla vite permette di ridurre i sintomi causati dallʼinfezione di P. viticola anche a livello sistemico, cioè sulle foglie che non sono state direttamente a contatto con il microrganismo benefico.
Lʼefficacia sistemica dimostra che la resistenza è mediata da meccanismi di autodifesa della pianta ed è quindi riconducibile ad un processo tipico dellʼISR.
Leanalisi molecolari hanno dimostrato che il trattamento con T. harzianum T39 attiva solo minimamente lʼespressione dei geni di difesa della pianta. Però, in seguito allʼinfezione con il patogeno, si osserva unʼintensa reazione nelle piante con ISR pre-attivata, caratterizzata da una significativa induzione dei marcatori della difesa.
la pianta. La caratterizzazione molecolare mediante uno studio combinato di trascrittomica e proteomica sarà essenziale per comprendere gli effettori e le vie metaboliche del meccanismo di difesa a livello cellulare per potenziare e sfruttare questo metodo naturale per la protezione delle piante.
fogliare di Trichoderma spp. non provoca riduzione della crescita della pianta e nemmeno compromissione dellʼattività fotosintetica. Anche in seguito a numerosi trattamenti con questi induttori di resistenza (Trichoderma spp.) non si rilevano fitotossicità o costi metabolici per la pianta.
della resistenza attivata da molecole chimiche come il benzotiodiazolo (BTH), il T. harzianum T39 non innesca direttamente le difese della pianta, ma genera uno stato di allerta (detto priming) che garantisce una rapida ed efficiente reazione solo caso di infezione del patogeno.
La condizione di allerta consiste nella capacità della pianta di attivare una più intensa risposta di difesa ai patogeni, senza sostanziali modifiche metaboliche e quindi senza costi energetici per

1. 3
Ampelomyces quisqualis riconosce la presenza del suo fungo ospite
Ampelomyces quisqualis è un parassita delle Erysiphales ed è usato come agente di biocontrollo contro diverse specie di oidio. La germinazione di A. quisqualis è specificamente attivata dalla presenza dellʼospite, in particolare da sostanze idrosolubili prodotte dai conidi dellʼoidio.
Dopo la fase di germinazione, A. quisqualis comincia la fase attiva di parassitizzazione e penetra la parete cellulare dellʼospite utilizzando sistemi meccanici ed enzimatici. Le colonie di oidio parassitizzate continuano la loro crescita, ma non appena A. quisqualis penetra nel loro micelio smettono la sporulazione. Nella fase più tardiva del micoparassitismo, dopo una graduale degenerazione, le cellule di oidio parassitizzate muoiono.
Nonostante questa interazione sia stata studiata ampiamente dal punto di vista descrittivo, la mancanza di dati riguardanti la genetica di A. quisqualis e la difficoltà di studiare i meccanismi

molecolari coinvolti nella micoparassitizzazione, ne hanno fino ad ora limitato la comprensione. In questo studio abbiamo generato un vasto catalogo di trascritti di A. quisqualis utilizzando il pirosequenziamento 454.
Ilsequenziamento è stato effettuato partendo dalla posizione 3ʼ dei frammenti di cDNA facenti parte di una libreria normalizzata costruita da campioni di RNA campionato a differenti stadi della micoparassitizzazione dellʼoidio.
Questo catalogo è stato poi usato per costruire un microarray di espressione che ha permesso la caratterizzazione globale dei cambiamenti di trascrizione che avvengono durante la germinazione dei conidi di A. quisqualis in presenza dellʼoidio. Lʼanalisi di espressione ha evidenziato che 1773 trascritti sono regolati durante questa fase. Una particolare caratteristica di questa
riprogrammazione della trascrizione è lʼinduzione di molti geni codificanti proteine coinvolte nella sintesi di glucanasi, chitinasi e proteasi extracellulari.
Questo fatto suggerisce che immediatamente dopo la fase di riconoscimento, A.quisqualis è soggetto ad una modulazione genica avente come fine la degradazione dei costituenti macromolecolari dellʼoidio che fungono da scheletri carboniosi e/o servono per la produzione di energia per la sintesi di proteine ed altri componenti necessari per la sua crescita a sviluppo.
Inparallelo allo studio genetico sono state effettuate prove fenotipiche volte a valutare il livello di aggressività di alcuni ceppi di A. quisqualis nei confronti di differenti specie di oidio. Sono stati isolati trenta ceppi di A. quisqualis provenienti da differenti luoghi geografici, ospiti fungini e piante e sono
stati caratterizzati geneticamente mediante il sequenziamento delle sequenze ITS. In condizioni controllate, tutti i ceppi selezionati riducono la sporulazione dellʼoidio e i livelli di riduzione sono correlati al ceppo.
Infatti, i ceppi possono essere suddivisi in molto o scarsamente aggressivi e tale tendenza è stata osservata con diverse specie di oidio. Le diverse specie di oidio hanno livelli di suscettibilità diversi nei confronti di A. quisqualis I risultati suggeriscono che non ci sono adattamenti di A. quisqualis alle diverse specie di oidio o provenienti da aree geografiche diverse.

La scoperta del meccanismo dʼazione di Ampelomyces quisqualis permetterà di migliorarne lʼefficacia nel controllo dellʼoidio
Nel campo della post-genomica la nostra limitata comprensione delle vie metaboliche alla base della biosintesi dei composti secondari nelle piante limita la possibilità di adottare strategie di miglioramento genetico su base molecolare, che rappresentano un approccio promettente per il miglioramento a breve termine della qualità di vari frutti.
Obiettivo del gruppo MetaFlux è quello di riunire metabolomica e dati genomici al fine di definire vie metaboliche legate a specifici metaboliti delle piante (dal gene al metabolita) direttamente finalizzate a questi programmi di miglioramento genetico. Il flusso metabolico è di grande interesse ed è essenziale per disegnare un modello metabolico teorico confermato mediante analisi enzimatiche. I nostri studi saranno effettuati misurando il flusso delle reazioni (attività enzimatiche) correlate ai geni (e di conseguenza alle corrispondenti proteine) ed i metaboliti identificati in tessuti specifici e/o genotipi.
[Stefan Martens]Il colpo di fuoco, causato da E. amylovora, ha spesso inizio da popolazioni epifite che si moltiplicano sul fiore. Necessita di acido nicotinico (NiAc) o/e nicotinamide (NiNH2) come fattori di crescita essenziali. Recentemente abbiamo messo a punto un agente di biocontrollo che consuma NiAc. Per una sua corretta applicazione è fondamentale conoscere il contenuto di NiAc e NiNH2 sui fiori. La quantità di NiAc è correlata positivamente con lʼaltitudine del frutteto ed inversamente alla sommatoria delle temperature nei 30 giorni precedenti la fioritura. La quantità di NiAc e NiNH2 nellʼipanzio di pero è da 6 a 23 volte superiore alla quantità minima richiesta per la crescita di E. amylovora, mentre nel melo è nettamente inferiore e va da 1,2 a 3,5 volte a seconda della varietà.
[Thomas Paternoster, Urska Vrhovsek, Fulvio Mattivi, Ilaria Pertot]I risultati della nostra ricerca volta a comprendere le differenti percezioni dei vari attori ‒ cittadini, addetti ai lavori e ricercatori ‒ sui rischi associati al trasferimento di geni nelle piante ed agli organismi geneticamente modificati sono riportati nel capitolo “Gene Transfer: Technical Visions and Emotional Perceptions” scritto da Lucia Martinelli.
Il capitolo è pubblicato nel volume Psychology of Risk Perception (2010) a cura di J.G. Lavino & R.B. Neumann, ed. NOVA publisher. Esso presenta una collezione delle più recenti ricerche originali nel campo della percezione del rischio in vari ambiti e discipline.
[Lucia Martinelli]La comprensione dei meccanismi del silenziamento genico in risposta ad infezione virale prospetta lo sviluppo di nuove strategie di lotta alle virosi. Allo scopo, stiamo studiando la resistenza a Grapevine Fanleaf virus (GFLV) e Grape Leafroll virus (GLRV) con un approccio di RNA interference. Vettori specifici per il silenziamento delle 4 proteine Dicer-like di vite ( VvDCL1-4) sono stati introdotti via Agrobatterio in ʻBrachettoʼ. Alla quantificazione dellʼespressione genica di ciascun DCL nelle piante transgeniche rigenerate seguiranno lʼanalisi dei piccoli RNA derivanti da GFLV e GLRV e lo studio della gerarchia tra le VvDCLs nella resistenza e nel processamento dei trascritti virali.
[Marina Cavaiuolo, Lorenza Dalla Costa, Valentino Poletti, Lucia Martinelli, Azeddine Si-Ammour]


Il colpo di fuoco, causato da Erwinia amylovora, è la malattia di origine batterica più distruttiva per le piante della famiglia delle Rosaceae (melo e pero) e negli ultimi anni ha causato seri danni economici in varie parti del mondo. Sebbene il patogeno sia ben caratterizzato, le basi genetiche dei fenomeni di resistenza e suscettibilità nel melo sono ancora relativamente sconosciute. Lo scopo del nostro lavoro è comprendere i meccanismi di interazione tra Erwinia e melo, pero e fragola. Attualmente stiamo analizzando tramite tecniche di sequenziamento di nuova generazione il trascrittoma di piante resistenti e suscettibili, inoculate con ceppi batterici di E.amylovorawild type e mutati.
[Laura Righetti, Mickael Malnoy]Sono stati selezionati 36 genotipi resistenti agli scopazzi del melo derivanti dallʼattività di breeding con la specie selvatica M. sieboldii, donatore di resistenza. Strategie sviluppate ad hoc quali lʼapproccio in vitro, lo sviluppo di marcatori molecolari per il carattere della resistenza e test in serra consentono di accelerare il processo di selezione in campo. I 36 genotipi hanno superato tutti i test e attualmente sono in corso ulteriori prove di infezione con virus latenti per verificare la risposta di queste piante anche alle virosi. Per valutare il valore agronomico di questi genotipi e il loro utilizzo in alternativa ai portinnesti commerciali sono state allestite anche prove di campo.
[Claudia Bisognin]
Ricercatori e curatori di collezioni provenienti da 17 Paesi di Europa, Caucaso e Nord Africa si sono riuniti a San Michele nel Settembre 2009 per lʼincontro annuale del progetto europeo GRAPEGEN 06 sulla caratterizzazione e la gestione delle risorse genetiche di vite. Lʼobiettivo finale del progetto GRAPEGEN 06 è lʼadozione di un protocollo di mantenimento del germoplasma di Vitis, comprendente la conservazione ex-situ, la crioconservazione e la conservazione presso aziende. In questo modo le risorse genetiche potranno essere facilmente accessibili e valutate in appropriati contesti agricoli. Questa rete di risorse viticole fornirà anche materiali vegetali come base per la ricerca biotecnologica e genomica e per il breeding della vite.
[Maria Stella Grando, Flavia Maia Moreira]La voce ʻDNA ricombinanteʼ, curata da Lucia Martinelli, è una delle varie accessioni incluse nel volume “Encyclopedia of Science and Technology Communication” (2010), curato da S. Hornig Priest ed edito da Sage, la prima enciclopedia dedicata ai comunicatori scientifici. Oltre a rigorose spiegazioni scientifiche, ciascuna voce fornisce rilevanti riflessioni, indispensabili a chi scrive di scienza, che trascendono dal significato del puro termine scientifico.
[Lucia Martinelli]
Combattere le malattie e migliorare il cibo per difendere la salute umana
2part_
La Piattaforma Tecnologica “Food for Life” è nata nel 2005 in ambito del 7°Programma Quadro, per rispondere allʼesigenza, avvertita a livello europeo, di sviluppare una bio-economia che si fondi sulla conoscenza. Food for Life è una linea di ricerca dellʼArea Nutrizione e Qualità Alimentare della FEM, che vanta una consolidata competenza nel settore della qualità alimentare e della tracciabilità e che da sempre è consapevole dellʼimportanza che rivestono le produzioni agricole alimentari per lʼeconomia regionale.
Recenti studi hanno dimostrato come una dieta ricca di alimenti vegetali di qualità, in particolare frutta e verdura, può prevenire unʼampia gamma di patologie croniche. In questi alimenti sono presenti delle molecole biologiche attive, responsabili degli effetti benefici sulla salute dellʼuomo. Questi metaboliti attivi sono da sempre oggetto di studio nelle scienze dellʼalimentazione. Riuscire a misurarne un numero elevato in un singolo esperimento risulta quindi importante.
La metabolomica offre uno straordinario aiuto in questo senso, in quanto permette di individuare simultaneamente migliaia di metaboliti, noti o sconosciuti, che possono essere poi ricercati con esperimenti mirati, tarati sui dati appena scoperti. Questa tecnica permette di caratterizzare in modo molto preciso gli effetti di un nutriente, di un cibo o di una particolare dieta ed è quindi destinata a ricoprire un ruolo di punta nelle scienze della nutrizione. Eʼ particolarmente adatta nellʼanalisi delle complesse interrelazioni tra la nutrizione ed il metabolismo e nel-
la comprensione dellʼinfluenza dei componenti della dieta sulla salute e sulla malattia. La metabolomica nutrizionale si focalizza sui metaboliti attivi associati agli effetti che la dieta produce sulla salute umana.
Le prime indicazioni che verranno fornite dalla metabolomica nutrizionale saranno lʼindividuazione di nuovi marcatori adatti ad evidenziare variazioni nello stato di salute o malattia e la misurazione del tasso di assorbimento di specifici nutrienti sia nel breve che nel lungo periodo. I primi risultati hanno evidenziato come quei metaboliti che mutano in risposta agli eventi nutrizionali o agli stati di malattia, derivino sia da processi metabolici complessi che coinvolgono il metabolismo umano e quello della microflora intestinale, che direttamente dalla trasformazione microbica del cibo.
Un obiettivo chiave per le ricerche che verranno condotte in Food for Life è di caratterizzare il destino metabolico delle molecole biologicamente attive presenti in alimenti a valenza salutistica, soprattutto in quelli importanti per lʼeconomia locale, come mele, vino e piccoli frutti.
Food for life si basa sulla forte integrazione tra le diverse aree di eccellenza in chimica degli alimenti e genomica già presenti in FEM e mira a sviluppare nuove competenze nel settore della nutrizione umana e della nutrigenomica, costruendo una piattaforma in grado di misurare i processi metabolici e le proprietà salutistiche dei metaboliti biologicamente attivi presenti nelle produzioni alimentari.
Ipiccoli frutti appartenenti alla famiglia del genere Rubus ‒ more e lamponi ‒ sono considerati una ricca fonte di antiossidanti grazie allʼelevato contenuto di composti di natura fenolica. Nello specifico essi hanno elevate concentrazioni di ellagitannini e coniugati dellʼacido ellagico. La ricerca si è concentrata su questi composti perché appartengono ad una classe piuttosto rara e si trovano solamente in alcuni frutti come fragola, melagrana, uva muscadina, in alcuni tipi di noci, nella mora e nel lampone .
Nella dieta europea, soprattutto negli stati del nord Europa, lampone e mora sono i frutti con contenuto più alto di ellagitannini. Nel corso degli ultimi anni si è scoperto che gli ellagitannini agiscono nei sistemi biologici come antiipertensivi e antiossidanti che proteggono da alcune forme di allergia. Inoltre in letteratura è nota la loro attività antitumorale, specialmente come agenti chemio protettivi per alcune forme di tumore.
Un nuovo protocollo di caratterizzazione di 27 ellagitannini e dei derivati dellʼacido ellagico in Rubus.
More e lamponi ne hanno una concentrazione media di 1.3 g/kg

Gli ellagitannini sono anche i principali costituenti di alcuni rimedi tradizionali preparati con le foglie di queste piante.
Gli ellagitannini contenuti nelle bacche e nelle foglie sono formati da una complessa famiglia di tannini monomerici ed oligomerici.
La loro struttura nativa non è ancora nota ed è oggetto di molti progetti di ricerca, che mirano a capire gli effetti degli ellagitannini sulla salute umana.
Tuttavia la ricerca è resa difficoltosa dalla mancanza di standard di riferimento e di metodi di quantificazione della sostanza nella forma nativa.
Nel 2009 ci si è concentrati su due punti fondamentali: i) lʼisolamento, la purificazione e la caratterizzazione strutturale di due standard (sanguiin H-6 e lambertianin C) da usare come standard esterni e ii) la determinazione della struttu-

ra chimica di 20 nuovi ellagitannini minori e di 4 coniugati dellʼacido ellagico attraverso lʼanalisi degli spettri in Q-TOF-HDMS e DAD.
Il nuovo metodo di analisi permette di comparare la composizione delle diverse cultivar di lampone e mora, sulla base della presenza delle 27 diverse strutture di ellagitannini o coniugati dellʼacido ellagico. Dallo studio si è scoperto che lamponi e more contengono in media
1.3 g/kg di composti di natura ellagica. La maggior parte è costituita da ellagitannini (>1g/kg), mentre la restante da derivati dellʼacido ellagico. Si è inoltre scoperto che lambertianin C e sanguiin H-6, i due principali ellagitannini, rappresentano lʼ81% del totale degli ellagitannini nei lamponi (range 73-86%) ed il 67% nelle more (range 41-83%).
Infine si è dimostrato che il principale composto nelle more è la lambertianin C, mentre nei lamponi è la sanguiin H-6 .
Moree lamponi hanno una composizione di ellagitannini molto simile, essendo due frutti affini appartenenti al genere Rubus
Tuttavia la nostra ricerca ha evidenziato differenze nella loro qualità e quantità. Si è inoltre scoperto che le diverse cultivar di lamponi e more presentano concentrazioni di ellagitannini diverse a seconda del periodo stagionale di maturazione. Questo inciderà sulla futura selezione e sviluppo di nuove varietà.
La maturazione dellʼuva è un processo molto complesso in quanto coinvolge lʼattivazione di numerose vie metaboliche. Per citare le più importanti ricordiamo quella del metabolismo degli zuccheri e degli acidi, del metabolismo secondario e della parete cellulare. Il risultato di questi processi biochimici ha un forte impatto sulla qualità del frutto e di conseguenza anche sul valore economico dellʼuva e dei suoi derivati, il più importante il vino. Per questa ragione, oltre che per motivi di carattere scientifico, da alcuni anni presso il CRI, stiamo studiando il processo di maturazione dellʼuva e la sua regolazione.
il nostro gruppo con altri ricercatori in ambito internazionale, ha dimostrato che i cambiamenti biochimici che avvengono allʼinizio della maturazione (invaiatura, dal francese véraison) sono accompagnati da profonde variazioni nei livelli trascrizionali. Dallʼaltra parte era già noto che anche molti ormoni quali lʼacido abscissico, lʼetilene, le auxine e i brassinosteroidi giocano un ruolo fondamentale nella regolazione di tale processo. Meno noto è invece il ruolo di altre molecole segnale, quali ad esempio le specie reattive dellʼossigeno (ROS), che svolgono unʼazione importante nellʼinterazione fra pianta e patogeno. Il nostro gruppo ha scoperto che probabilmente i ROS sono importanti anche nella maturazione del frutto. Abbiamo infatti osservato un accumulo di acqua ossigenata nella buccia di uve di Pinot Nero a par-

tire dallʼinvaiatura. Ci rimane ora da capire dove questi ROS vengono generati allʼinterno della cellula e quale sia il loro ruolo funzionale. Dal punto di vista genetico, la qualità dellʼuva è un carattere quantitativo, controllato da numerosi fattori ed enormemente influenzato dallʼambiente. Unʼimportante componente della qualità dellʼuva è determinata dalla capacità di accumulo di sostanze monoterpeniche nellʼacino. Questi composti sono responsabili del tipico aroma delle varietà Moscato e di qualche altra cultivar aromatica come il Gewürztraminer. Lʼaroma moscato è infatti particolarmente apprezzato nelle uve da tavola e gioca un ruolo importante anche nella definizione dei prodotti enologici. Lʼidentificazione delle regioni genomiche coinvolte nella determinazione dellʼaroma moscato rappresenta quindi un contributo alla comprensione del controllo genetico di un carattere di principale interesse per il miglioramento genetico dei vitigni.
Gliacini dʼuva contengono centinaia di composti che potenzialmente contribuiscono al profumo e allʼaroma del vino, tuttavia solo i monoterpeni e pochi altri componenti dellʼuva che non subiscono alterazioni durante il processo di vinificazione sono stati finora associati alle sostanze volatili del vino. Per questo i monoterpeni rappresentano un target su cui agire per innalzare le proprietà qualitative dei prodotti enologici.

Ilnostro gruppo ha identificato le varianti dei geni che conferiscono lʼaroma moscato alle uve e che quindi hanno una potenziale applicazione nel miglioramento genetico delle varietà. Inizialmente abbiamo osservato che il gene codificante per lʼenzima 1-deoxy-D-xylulose5-phosphate synthase era posizionato allʼinterno di una regione genomica (QTL) risultata associata alla variazione del contenuto di linalolo, nerolo e geraniolo nelle uve. In un
secondo momento abbiamo stabilito quali erano le mutazioni del gene responsabili dei fenotipi aromatici, sia nei vitigni Moscato che nei cloni aromatici di varietà neutre.
Per questo studio sono state utilizzate popolazioni sperimentali ottenute da incrocio e unʼampia collezione di vitigni aromatici e non.
Questi risultati ci hanno fornito efficaci marcatori molecolari che possono trovare rapida applicazione nei programmi di miglioramento genetico per selezionare precocemente i genotipi desiderati.
Capire come lʼazione di questi geni è influenzata dalle condizioni ambientali potrà aiutare in futuro anche nella definizione di tecniche colturali volte a garantire una produzione stabile di qualità.
Il processo di maturazione dellʼuva e la formazione dei metaboliti secondari che condizionano la qualità del vino sono controllati a livello genetico.
Nuove prospettive per il miglioramento genetico delle varietà.
2. 3
I composti volatili del lampone: la chiave per un piacevole aroma ma non solo
Importanti caratteristiche sensoriali, quali aroma ed odore, sono il risultato della complessa combinazione di centinaia di composti volatili rilasciati dal frutto. Nel lampone ne sono stati identificati circa 200. La maggior parte del prodotto italiano è destinata al mercato fresco, pertanto la qualità dei frutti, ed in particolare il loro aroma, è di fondamentale importanza. Al di là del contributo chiave dei composti volatili per la definizione degli aspetti sensoriali, essi sono coinvolti in alcuni meccanismi di difesa naturale delle piante, come evidenziato anche dalla nostra ricerca.
Nellʼambito del progetto INTERBERRY (Fondo Ricerca PAT), uno studio multidisciplinare per il miglioramento della qualità dei piccoli frutti, sono stati confrontati per due anni consecutivi i profili dei composti volatili di 14 varietà di lampone, selezionate tra quelle in valutazione nei campi sperimentali della FEM. Per tale studio sono state utilizzate due tecniche di spazio di testa: la SPME seguita da gas-cromatografia ed lʼiniezione diretta in PTR-MS. Sono stati analizzati anche

46 composti volatili sono stati monitorati per due anni in 14 cultivar di lampone.
Quelle cultivar con frutti che emettono più terpeni risultano più resistenti a Botrytis cinerea.
varietà commerciali e succhi freschi. Quarantasei sono i composti monitorati: la classe maggiormente rappresentata è la famiglia dei monoterpeni con 12 molecole seguita dalla famiglia dei C13-norisoprenoidi con 10 composti. Queste due classi di composti da sole contribuiscono quantitativamente per il 54 e 65% dello spazio di testa. Dal confronto dei due anni è emerso che i campioni raccolti nel 2007 presentavano una maggiore emissione di composti volatili che può essere spiegata con le temperature più basse registrate in campo in quellʼanno. Nonostante le ampie differenze nella composizione dello spazio di testa, le varietà studiate possono essere divise in due principali gruppi: uno caratterizzato da una maggiore presenza di monoterpeni e lʼaltro di C13-norisoprenoidi ed alcoli terpenici. Attualmente stiamo lavorando nello sviluppo di modelli di classificazione basati su tali dati.
Composti volatili e profili sensoriali delle cinque varietà analizzate (Heritage, Himbotop, Popiel, Polka e Tulameen) sono state valutate anche da un panel addestrato. Lʼanalisi sensoriale ha evidenziato delle differenze nellʼintensità di alcuni odori e aromi che possono in parte essere spiegate dal profilo dei composti volatili. Ad esempio, i lamponi Tulameen, che presentano una maggiore concentrazione di composti volatili a 6 atomi di carbonio associati a note erbacee, sono caratterizzati da intensità maggiori per lʼodore e lʼaroma di erba.
composti contro la botrite, usati sia singolarmente che in combinazione. La selezione di varietà resistenti ai patogeni è di fondamentale importanza per ridurre lʼemissione di prodotti chimici nellʼambiente.

Lanostra ricerca conferma lʼimportanza dello studio dei profili dei composti volatili per i programmi di miglioramento varietale delle colture frutticole per selezione di frutti più attraenti e indica che il ruolo dei composti volatili naturalmente emessi dalle piante come difesa va ulteriormente investigato.
e promettenti evidenze indicano che le varietà che emettono maggiore quantità di determinati composti volatili risultano essere meno suscettibili a Botrytis cinerea, uno dei funghi patogeni più diffusi durante la conservazione. Attualmente sono in corso valutazioni più approfondite per verificare lʼeffettiva efficacia di questi

Lo squalene è un idrocarburo (C30H50) usato principalmente come additivo in vaccini e sotto forma del derivato idrogenato squalano (C30H56), come agente emolliente ed idratante in cosmesi.
Èprodotto principalmente dallʼolio di fegato di squali di profondità, appartenenti a specie a rischio dʼestinzione. Poiché lʼuccisione di migliaia di squali allʼanno risulta poco etica, si sono ricercate delle alternative di tipo vegetale alla produzione di squalene. Esso infatti può essere prodotto anche dai distillati di olio dʼoliva ottenuti per raffinazione fisica o chimica (deacidificazione o deodorizzazione) dellʼolio lampante. Lo squalene da olio dʼoliva viene prodotto però con minor resa e tempi più lunghi ed è quindi venduto a prezzi più alti.
Nel 2006 lʼUnione Europea ha imposto dei limiti alla pesca di squali di profondità nel Nord-Est Atlantico e dal 2008 alcune tra le più importanti ditte cosmetiche hanno dichiarato di non fare più uso di derivati animali quali lo squalano. Non essendoci però metodi analitici in
Lʼanalisi degli isotopi stabili del carbonio presenti nei prodotti di cosmesi consente di capire se lo squalene o lo squalano utilizzati derivano da olio dʼoliva o dallʼolio estratto dal fegato di squali a rischio di estinzione.
grado di identificare lʼorigine (se da squali o da olio dʼoliva) del prodotto, rimane la tentazione di produrre ed usare squalene/squalano da squalo.
Inquesto studio si è verificata lʼapplicabilità dellʼanalisi dei rapporti tra isotopi stabili di C e H (13C /12C e 2H/1H) nel distinguere squalene e squalano da squalo da quello da olio dʼoliva e nellʼidentificare la presenza di derivato da squalo in un prodotto dichiarato di origine vegetale.
Sonostati considerati 13 campioni autentici di squalene o squalano da olio dʼoliva (da Spagna, Italia, Francia e Turchia) e 15 campioni da olio di fegato di squalo (da Spagna, Portogallo, Giappone e Corea), rappresentativi dellʼarea di produzione del prodotto.
I rapporti isotopici di C e H sono stati analizzati utilizzando uno Spettrometro di Massa Isotopica interfac-
ciato ad un analizzatore elementare o ad un gas cromatografo con combustore, a seconda della purezza del campione.
Il rapporto 13C/12C (espresso come δ13C ) è risultato significativamente più basso in squalene e squalano da olio dʼoliva (-28.4‰ ± 0.5‰) rispetto a quelli da squalo (-20.5‰ ± 0.7‰). Il rapporto isotopico 2H/1H non è risultato invece diverso tra le due origini.
per determinare lʼorigine di ogni batch di squalene e squalano al commercio e di squalano presente in prodotti cosmetici.
Ilmetodo sarà in grado di promuovere la produzione di squalene da olio dʼoliva e di limitare la pesca illegale di squali di profondità, contribuendo alla salvaguardia di specie in estinzione.
un valore soglia di δ13C pari a -27.4‰ è stato possibile determinare aggiunte fino al 10% di derivati da squalo in squalene e squalano da olio dʼoliva. Sulla base di questo valore soglia, lʼanalisi di squalano estratto da diversi prodotti cosmetici ha evidenziato unʼorigine da squalo anziché da olio dʼoliva.
Lʼanalisidel δ13C può essere proposta come metodica ufficiale

N el 2008 un team di ricercatori presso lʼAWRI (South Australia) ha identificato il rotundone, un sesquiterpene chetone. Questo composto è essenziale per lʼaroma del pepe bianco e nero, dellʼuva e del vino Syrah e di importanti spezie quali maggiorana e rosmarino.
Èsorprendente che la scoperta del composto che conferisce il carattere distintivo al pepe sia stata fatta investigando lʼaroma del vino!
Un team di ricercatori presso la FEM, in collaborazione con scienziati delle Università di Bologna (prof. Daniele Nanni) e Milano (prof. Leonardo Valenti), è riuscito a mettere a punto un nuovo e conveniente protocollo per la sintesi del rotundone, a partire da un composto disponibile in commercio e in due sole reazioni, ed a validare un metodo rapido ed accurato per il suo dosaggio. Esso prevede separazione gascromatografica (GC) e quantificazione in spettrometria di massa tandem (MS/MS), in modalità multiple reaction monitoring
Un efficace metodo per lʼanalisi del rotundone nei vini mediante microestrazione in fase solida e gascromatografia accoppiata alla spettrometria di massa tandem.

Grazie allʼapplicazione di un nuovo metodo di analisi è stata chiarita lʼorigine della nota speziata nei vini
(MRM) e con d5-rotundone come standard interno.
Il protocollo possiede la sensibilità e selettività desiderata per permettere lʼanalisi routinaria del rotundone nei vini. Si sono studiate alcune varietà apprezzate per un carattere distintivo fortemente speziato da pepe.
LoSchioppettino è una varietà nativa dei Colli Orientali del Friuli, utilizzata per produrre vini con fortissima personalità, caratterizzati da fragranze speziate e da un aroma elegante e raffinato, con uno speciale sentore di pepe bianco.
LaVespolina è una varietà di uva rossa autoctona coltivata nelle province di Novara, Varese e Pavia.
È utilizzata nella produzione di vini rossi di alta qualità (DOC e DOCG), particolarmente “pepati”.
È impiegata sia con altre varietà quali Nebbiolo, Bonarda e Croatina, che da sola per la produzione di vini in-
tensamente colorati e con un aroma speziato di inconfondibile intensità.
Lavarietà Gruener Veltliner è considerata la bandiera della viticoltura austriaca, dove rappresenta il 33% dellʼintera produzione viticola. È coltivata anche in Europa Centrale e nel Nord Italia, in Val dʼIsarco, complessivamente su circa 24.500 ha. Le uve di Gruener Veltliner sono impiegate per produrre rinomati vini bianchi secchi, fruttati e speziati con sentore di pepe.
Sono al momento in corso ulteriori ricerche per chiarire i fattori vitienologici e genetici che controllano la presenza di questo importante composto aromatico nelle uve e nei vini.
vini Schioppettino e Vespolina sono state trovate concentrazioni di rotundone che superano di 17-35 volte la soglia sensoriale, mentre nei vini bianchi Gruener Veltliner il rotundone è presente con concentrazioni tra 4 e 17 volte la soglia di percezione. In conclusione, tutti questi vini hanno elevatissime concentrazioni di rotundone, tali da rendere conto del loro distintivo aroma “pepato”.
Irisultati preliminari di una larga indagine su vini italiani, austriaci e spagnoli supporta lʼidea che il rotundone sia un componente semiubiquitario dellʼaroma del vino, e che un numero consistente di vitigni autoctoni ed antichi, tra i quali il Groppello di Revò in Trentino (Italia) ed il Graciano in Rioja (Spagna), sono caratterizzati dalla presenza di questo aroma a concentrazioni di forte impatto sensoriale.

Nello studio è stato sviluppato e validato un modello statistico capace di discriminare il formaggio DOP Parmigiano Reggiano dai suoi 3 principali competitors commerciali. Il modello è stato sviluppato in base ad una serie di parametri analitici (rapporti isotopici di H, C, N, S e contenuto in Li, P, K, Ca, Fe, Cu, Zn, Se, Rb, Sr, Mo, Cs, Sm, Gd, Dy, Yb, Re, U) analizzati mediante spettrometria di massa isotopica ed al plasma accoppiato induttivamente. Il modello può essere utilizzato per verificare lʼautenticità di campioni in commercio a tutela del produttore onesto e del consumatore. Lo studio è stato condotto in collaborazione con il dr R. Larcher del Centro Trasferimento Tecnologico FEM.
[Federica Camin]
NEGLI ALIMENTI: IL PTR-TOF-MS
Con Proton Transfer Reaction-Mass Spectrometry (PTR-MS) si indica una tecnica per il monitoraggio rapido e ad alta sensibilità dei composti volatili. I limiti dellʼimplementazione originale, che forniva solo la massa nominale degli ioni e quindi unʼinformazione analitica limitata, sono stati superati dallʼintroduzione di una versione basata su uno spettrometro a tempo di volo (PTR-TOF-MS). Presso FEM è da poco operativo un PTR-TOF-MS, lʼunico italiano e uno dei primissimi al mondo, che ha permesso di pubblicare le prime applicazioni agroalimentari di questa tecnica e di verificarne il range di massa più esteso, lʼelevata sensibilità e le buone accuratezza e risoluzione temporale.

[Franco Biasioli]
PICCOLI FRUTTI: TEST SENSORIALI
METODOLOGICI
Un panel di consumatori è stato coinvolto in una serie di test sensoriali finalizzati a sviluppare una nuova linea di succhi a base di piccoli frutti in grado di coniugare la piacevolezza e lʼalto contenuto di antiossidanti naturali di questi frutti con le esigenze dei consumatori, sempre più orientati verso prodotti “ready to eat”. Accanto agli approcci classici di analisi dati, è stato proposto un metodo innovativo per segmentare i consumatori in maniera automatica.

Secondo questo metodo hanno un ruolo attivo nella classificazione sia le informazioni sul consumatore (preferenza, dati demografici ed altre informazioni) che quelle sui prodotti (proprietà fisiche, chimiche e/o sensoriali).
[Isabella
Mappare la distribuzione spaziale dei metaboliti allʼinterno dei tessuti: questʼobiettivo ambizioso verrà reso possibile sfruttando gli strumenti di ultima generazione recentemente installati presso la Piattaforma per il Profiling Metabolico.
Lʼuso di tecniche di imaging basate su Spettrometria di Massa consentirà lʼacquisizione di vere e proprie “immagini molecolari” sfruttando metodi di ionizzazione quali la Laser Desorption Ionization (LDI) e la Desorption Electrospray Ionization (DESI).
LʼImaging Metabolico permetterà di approfondire la nostra comprensione del metabolismo delle piante prospettando avanzamenti significativi nellʼambito della qualità alimentare, della nutrizione e dellʼinterazione pianta-patogeno.

[Pietro Franceschi]

I ricercatori dellʼArea Alimentazione, in collaborazione con il Consorzio dei Caseifici Trentini, sono coinvolti in un progetto di ricerca finanziato dalla Provincia Autonoma di Trento finalizzato allʼottimizzazione della filiera produttiva del Grana Trentino. Lʼattività, che si concluderà nel 2010, persegue due obiettivi. Il primo è lo sviluppo di metodi di analisi innovativi per il controllo qualitativo delle produzioni. Il secondo è la valutazione degli effetti sulla qualità del formaggio delle modalità di conferimento del latte al caseificio più razionali ed economicamente più vantaggiose. Sulla base dei risultati della ricerca, il Consorzio sta mettendo a punto un piano di interventi innovativi finalizzati a migliorare gli standard qualitativi del prodotto nel pieno rispetto della tradizione.
[Flavia Gasperi, Agostino Cavazza]
UNA MOLECOLA DI DIFESA
Studi condotti negli ultimi anni portano a credere che il resveratrolo è una molecola benefica per la salute umana e per la difesa delle piante. Fornisce protezione contro le malattie cardiovascolari e contro il cancro e nello stesso tempo agisce come antifungino nelle piante che lo sintetizzano, tra cui la vite. Recentemente nei laboratori del CRI è stato scoperto che il resveratrolo si accumula nella bacca dʼuva in maturazione anche in assenza di infezioni di patogeni e che la sua concentrazione è strettamente dipendente dalla cultivar. In un progetto parallelo è stata ottenuta una elevata produzione di resveratrolo in colture cellulari di vite tramite aggiunta dellʼelicitore ciclodestrina.
È stato poi osservato che questo zucchero induce una risposta nelle cellule che per molti aspetti è analoga a quella che si verifica in seguito allʼattacco di un microorganismo patogeno.
[Claudio Moser]A sustainable world
Affrontare il cambiamento globale nelle Alpi
I territori montani sono un delicato equilibrio di ecosistemi, culture ed economie. Questi elementi vengono costantemente messi a dura prova dai cambiamenti che stanno avvenendo negli ultimi decenni a scala mondiale.
Lʼambiente montano, generalmente ricco dal punto di vista ambientale, risulta infatti particolarmente sensibile alle modifiche, anche lievi, degli assetti esistenti. Il riscaldamento globale ha già provocato la riduzione dellʼestensione dei ghiacciai. Il comparto turistico si trova a dover fronteggiare la minaccia della diminuzione degli apporti nevosi, con la conseguente perdita di attrattività durante la stagione invernale. Le precipitazioni sono mediamente calate nellʼarea alpina, con una diminuzione importante soprattutto in inverno. In Trentino si calcola che esse siano calate di circa un terzo negli ultimi 50 anni.
Eppure le cifre utilizzate per spiegare il cambiamento climatico tendono a semplificare una realtà che non procede in modo regolare e simmetrico, ma che presenta un andamento irregolare. Infatti lʼarea alpinomediterranea, e più in generale lʼintera area europea, ha subito un incremento di temperatura molto accentuato a partire dal 1980. Buona parte del riscaldamento misurabile rispetto al periodo precedente è attribuibile a questa anomalia. In generale, comunque si sta verificando un aumento a livello globale della frequenza degli eventi estremi, come anche dei periodi siccitosi.
Per quanto inerente la sfera umana il numero di residenti nelle Alpi è cresciuto, raggiungendo quota 13 milioni di abitanti. Tuttavia si registra un effetto di concentrazione, con la popolazione che tende ad ammassarsi in poche aree centrali, abbandonando quelle periferiche. Questo processo causa la scomparsa di aspetti culturali tradizionali e di modalità di gestione delle risorse naturali. Lʼapproccio orientato al contesto urbano porta alla rottura degli equilibri centenari, vanificando i benefici costruiti nel passato. Inoltre il mercato globale, condizionato dalle nazioni emergenti, tende a relegare le produzioni locali (quali legname e prodotti tipici) e il settore turistico ai margini dei maggiori flussi economici.
Lʼunica soluzione per ovviare a questa fragilità è di considerare lʼinsieme degli elementi naturali ed umani delle zone alpine come unʼunica risorsa collettiva, che possa godere di una gestione capace di comprendere i valori delle comunità residenti. Questa posizione è ampiamente condivisa dai vari approcci scientifici ed è stata recentemente premiata con lʼattribuzione del premio Nobel ad Elinor Ostrom.
Anche il CRI impegna le proprie risorse per indagare le dinamiche degli ecosistemi forestali ed acquatici, le risposte della biodiversità quando è sottoposta a nuove fruizioni del territorio, le tematiche emergenti in ambito sanitario ed i flussi dei gas-serra.
Lo sviluppo di malattie delle piante dipende dallʼinterazione tra ospite, patogeno, antagonisti microbici e ambiente. Se uno di questi fattori risulta alterato, lʼinsorgenza di una malattia e la sua progressione possono risultarne alterate di conseguenza. Lʼincremento di temperatura, che ci si aspetta nei prossimi decenni, accelererà lo sviluppo di alcuni insetti incrementando potenzialmente il numero annuale di generazioni.
Dʼaltrondeanche le colture sono influenzate direttamente dal clima e reagiscono al suo cambiamento in tutte le loro fasi (crescita, fioritura, sviluppo del frutto) con ricadute su produttività e qualità. La temperatura è la variabile principale che governa la velocità dello sviluppo fenologico della pianta, la lunghezza del ciclo vegetativo e la suscettibilità alle infezioni dei patogeni.
Per valutare potenziali impatti dei cambiamenti climatici sullʼagricoltura occorre quindi integrare modelli della fenologia delle colture con modelli di sviluppo dei patogeni e considerarne lʼinterazione.

Il cambiamento climatico influenzerà le colture ma anche i loro patogeni
Un sistema GIS integrato in grado di analizzare nelle colture più importanti le interazioni pianta - patogeno sulla base di modelli ecologici , e di simularne lʼevoluzione in risposta ai cambiamenti climatici
Ilprincipale obiettivo del progetto ENVIROCHANGE è fornire strumenti e informazioni per capire la vulnerabilità dellʼambiente agricolo trentino ai cambiamenti climatici e esplorarne le opportunità di adattamento.
Lemodificazioni degli ecosistemi agronomici trentini date dal cambiamento climatico sono studiate attraverso un sistema integrato di modelli ecologici/GIS (ENVIRO) per analizzare lʼinterazione Pianta/Patogeni di colture rilevanti per il Trentino.
Inparticolare, nel 2009 sono stati compiuti estesi monitoraggi in campo per aggiungere maggiore dettaglio ai modelli fenologici per la vite. La maggior parte dei modelli fenologici attualmente utilizzati considerano solo fasi importanti per la pianificazione degli interventi colturali, (come fioritura e maturazione).
Ma per valutare potenziali cambiamenti nella suscettibilità delle colture ai loro patogeni dʼinteresse è necessario considerare anche le fasi fenologiche “vulnerabili”.
Idati, raccolti su cinque varietà dʼuva dʼinteresse per il Trentino tra cui tre bianche (Chardonnay, Pinot grigio e Sauvignon blanc) e due nere (Pinot nero e Merlot), sono stati utilizzati per lʼestensione del modello FENOVITIS, che nella sua versione iniziale simulava solo germogliamento, fioritura e invaiatura.

Questo è avvenuto con la calibrazione di due nuove fasi fenologiche che definiscono la finestra di vulnerabilità della vite a Botrytis cinerea ed Erysiphe necator.
Sono stati inoltre validati con dati raccolti in Trentino i modelli di rischio per B. cinerea,
E. necator e Plasmopara viticola ed il modello di sviluppo di Lobesia botrana.
Iprossimi passi nellʼambito del progetto prevedono lʼintegrazione dei modelli di patogeni con quelli fenologici delle colture e la stima dei potenziali impatti del cambiamento climatico sul rischio di infezione.
Questo avverrà tramite lʼapplicazione dei modelli a scenari di cambiamento climatico, ad alta risoluzione temporale (giornaliera o oraria) e spaziale (200 m) e permetterà lo sviluppo di strategie di adattamento a corto e lungo termine.
Icambiamenti climatici in atto determinano, tra gli altri effetti, lʼaumento della frequenza degli incendi forestali e lʼalterazione della composizione delle specie degli ecosistemi naturali, influenzando il loro bilancio del carbonio. La stima delle capacità di sequestro di carbonio utilizzando diverse tecniche (microclimatiche, inventariali e telerilevamento) è assai importante a causa del legame tra cambiamenti climatici e lʼaccumulo di gas serra nellʼatmosfera.
Relativamente a tali aspetti sono stati pubblicati due importanti lavori da parte dei ricercatori della FEM. Nel primo, lʼuso simultaneo di dati telerilevati e raccolti a terra con stazioni microclimatiche ha permesso di misurare importanti parametri biofisici (PB) in un sito di prateria di montagna. Gli indici di vegetazione, quali NDVI e Green-NDVI, sono in grado di predire i PB.

Imigliori risultati sono stati ottenuti con simulazione delle bande dei sensori MODIS e Hyperion. Il secondo lavoro ha evidenziato il ruolo del telerilevamento per la stima del rischio di incendio.
Le
In Trentino la ricerca si è concentrata sugli effetti che il cambiamento climatico ha sulle foreste.
dinamiche forestali sono un tema di grande attualità.
Sono stati calcolati, utilizzando dati telerilevati, tre importanti parametri (contenuto dʼacqua, indice di area fogliare e rapporto di biomassa verde) coinvolti nella predizione del rischio di incendio.
Lʼuso combinato di tali parametri ha permesso di ottenere una mappa del rischio di incendio per le zone di prato di Bosco della Fontana, in Lombardia. Lʼestrema variabilità spaziale del rischio di incendio ha evidenziato lʼimportanza di ottenere mappe dei parametri biofisici a scala adeguata.
Glieffetti dei cambiamenti climatici nel modificare la composizione e le frequenze delle specie sono stati valutati con analisi polliniche. Importanti progressi con questo indicatore biologico sono stati raggiunti attraverso metodi di rilevamento innovativi, come la spettrometria IR in trasformata di Fourier e procedimenti biomoleco-
lari di PCR Real-Time, che permettono una rapida ed efficace quantificazione ed identificazione specifica dei granelli pollinici, utile anche per applicazioni in studi sulle allergie da polline.
Cupressus sempervirens al margine del suo areale nord di distribuzione, in una situazione di stress dovuto allʼaumento continuo della specie pur nei vincoli imposti dalle basse temperature invernali.
Gli
anelli legnosi degli alberi sono un indicatore biologico con alta potenzialità informativa per il ruolo che svolgono come archivi ambientali. In questo contesto, uno studio è stato eseguito con successo utilizzando Sincrotrone a raggi X per individuare la fissazione dello zolfo negli anelli legnosi di Picea abies e Abies alba del Trentino. Le analisi dimostrano che le concentrazioni di zolfo sono più elevate nella seconda metà del 20°secolo e confermano la simile tendenza osservata con stalagmiti reperite nelle vicinanze.

Ancora, riguardo agli indicatori ecologici, è stato interessante analizzare il comportamento di
Comespecie non indigena, il cipresso si è adattato ai nuovi ambienti e può perciò fornire indicazioni importanti sulla capacità delle foreste di far fronte ai probabili futuri scenari di cambiamento climatico. In questo contesto, il primo studio genetico su larga scala è stato eseguito su questa specie, analizzando le dinamiche e le sue possibili vie di introduzione negli ultimi millenni.
Gli ecosistemi montani sono estremamente interessanti in virtù della loro ricchezza di piante ed animali selvatici e la varietà delle nicchie ecologiche e delle condizioni microambientali. Grazie a queste peculiarità e alla loro complessa topografia, che li ha preservati dallʼalterazione delle attività umane, essi sono un laboratorio a cielo aperto per studiare come le specie naturali, animali e vegetali e le comunità sono capaci di sopravvivere in condizioni climatiche molto variabili.
Gli ecosistemi montani, perciò, forniscono un sistema di studio privilegiato per indagare i processi di adattamento passati, presenti e futuri. Con lʼavvento delle tecniche molecolari, è divenuto possibile identificare i geni responsabili delle strategie adottate dalle piante e dagli animali per fronteggiare gli stress ambientali e per modellare lʼabilità di varie specie a contrastare lʼattuale cambiamento globale, ovvero il cambiamento climatico e quello dellʼuso del suolo. Il primo anno di attività di ACE-SAP (Ecosistemi Alpini in un Ambiente
Mutevole: Sensibilità della Biodiversità e Potenziale Adattativo), un progetto finanziato dalla

Provincia Autonoma di Trento, coordinato dalla FEM e che ha come partner il Museo Civico di Rovereto ed il Museo Tridentino di Scienze Naturali e lʼUniversità di Davis (California, USA), è stato, perciò, dedicato a gettare le basi per capire i meccanismi di adattamento negli ambienti naturali di questa area, isolando e caratterizzando i geni con una presunta rilevanza per lʼadattamento e misurando la variabilità genetica attuale delle specie selezionate.
Iprincipali risultati conseguiti dalla FEM nel primo anno riguardano diverse specie. Studi su ceppi scelti di Planktothrix rubescens isolati da popolazioni naturali che vivono in profondi laghi subalpini meridionali hanno prodotto informazioni rilevanti sul potenziale di questa specie di formare fioriture algali disturbanti e i loro effetti sulla qualità dellʼacqua. Studiando la diversità genetica adattativa in cin-
que conifere alpine sono stati già ottenuti dati utili per la gestione forestale. I pattern di diversità e differenziamento genetico, rilevanti per allestire strategie di gestione, sono stati ottenuti in molte specie rappresentative degli ecosistemi montani come la pernice bianca, la lucertola vivipara e lʼendemita carpione del Garda.
Anche lʼidentificazione, con tecniche di sequenziamento di nuova generazione, di geni sotto selezione per lʼadattamento altitudinale in Brassicaceae promette di creare un modello, in associazione con le variabili ambientali, del potenziale adattativo per le specie orofite.

Nel 2009 unʼattività specifica si è focalizzata sul recupero, controllo ed omogeneizzazione delle serie climatiche in Trentino. La prova di omogeneizzazione ha portato alla selezione di lunghe
serie regolari, con una ristretta dispersione del segnale climatico negli ultimi 50 anni. Ulteriori risultati riguardano la risposta temporale di specie minacciate di galliformi a vari stressori, come il parassitismo e il cambiamento climatico.
Queste analisi suggeriscono che i parassiti elmintici possono costituire un rilevante fattore di stress per le popolazioni di galliformi del Trentino. È stato allestito un modello che include gli effetti della stagionalità sulle dinamiche dellʼinterazione ospite-parassita indagando lʼeffetto del clima sui cicli vitali del parassita e il conseguente impatto sulle dinamiche dellʼospite.
Il progetto ACE-SAP mira a svelare i meccanismi molecolari ed ecologici alla base della creazione e del mantenimento della biodiversità del Trentino per limitare gli effetti del cambiamento globale.
Vitalità, salute e biodiversità delle regioni alpine e subalpine dipendono dallʼampia disponibilità di risorse idriche. Lo stato naturale degli ecosistemi acquatici in queste regioni è stato e continua ad essere fortemente influenzato da una serie di cambiamenti indotti da eutrofizzazione, cambiamenti climatici ed eccessivo sfruttamento delle risorse idriche.
Analisi comparative condotte sul Lago di Garda e in altri laghi profondi del versante alpino meridionale hanno permesso di studiare gli effetti a lungo termine derivanti dai processi di eutrofizzazione e oligotrofizzazione, evidenziando, in particolare, un generale incremento dei cianobatteri e delle fioriture algali a seguito dellʼaumento dei carichi di fosforo. I cianobatteri includono specie che producono composti tossici (cianotossine).

Al fine di affrontare questi fenomeni sono state recentemente attivate nuove linee di ricerca finalizzate a studiare i profili tossici, i meccanismi di controllo ecologico ed il ruolo allʼinterno della rete trofica di popolazioni di cianobatteri raccolte e isolate nel distretto lacustre sudalpino.
Gli scenari climatici sviluppati dallʼIPCC prevedono un aumento della temperature dellʼaria
e modifiche nella distribuzione stagionale delle precipitazioni atmosferiche nelle regioni alpine. Nei laghi profondi ai margini di entrambi i versanti alpini è stato registrato un incremento della temperatura dellʼacqua compreso tra 0,1 e 0,2 °C per decade.
Alfine di comprendere le reciproche relazioni tra fattori climatici e trofici, linee di ricerca specifiche esamineranno i cambiamenti in epoca storica documentati da resti subfossili di organismi planctonici accumulati nei sedimenti lacustri, gli effetti dei cambiamenti climatici sullo sviluppo di fioriture algali tossiche e lʼecofisiologia di specie planctoniche in laghi alpini rappresentativi (Lago di Tovel).
Molti fiumi della regione alpina sono stati regimati allo scopo di contenere le piene e per favorire una numerosa serie di sfruttamenti. Il loro regime termico e idrologico è stato severamente alterato, tanto
che lʼacqua attraversa il territorio molto velocemente scorrendo in stretti canali.
trasformazioni hanno avuto conseguenze particolarmente gravi nelle aree di fondovalle: la biodiversità dei corsi dʼacqua ha subito una forte riduzione, la cui causa principale è stata individuata nella riduzione e degradazione degli habitat. La lunghezza ridotta e lo scorrimento veloce dei corsi dʼacqua, come pure la diminuzione delle zone umide, ha influenzato negativamente gli habitat ipogei, in relazione alla ridotta ricarica delle falde.
affrontati riguarda lo sfruttamento idroelettrico, in particolare lʼhydropeaking che si verifica al termine del processo di produzione a valle delle centrali. La finalità del progetto “Slow Water” è di immettere lʼeccesso di acqua nei tratti a valle degli impianti idroelettrici nel flusso di corsi dʼacqua caratterizzati da forti pulsazioni delle portata, allo scopo di ristabilire zone umide residue e vie dʼacqua artificiali, come il reticolo di fossati delle aree agricole.
importante conseguenza è costituita dalla riduzione dei processi di denitrificazione e ricircolo della sostanza organica operati dal metabolismo microbico. In uno scenario di tale complessità lʼapproccio multidisciplinare è indispensabile. Uno degli aspetti
degli ecosistemi acquatici costituisce un problema aperto per ricercatori, gestori delle risorse idriche e amministratori. Tuttavia, essa rappresenta pure unʼimportante opportunità per conciliare principi ecologici e utilizzo dellʼacqua in un contesto che vede come priorità lo sfruttamento sostenibile delle risorse idriche basato su una gestione consapevole ed avveduta.

Le componenti dei sistemi acquatici analizzate sotto varie prospettive in un ambiente mutevole come quello montano del Trentino
Le foreste hanno inizialmente un effetto di raffreddamento più debole in occasione delle ondate di calore rispetto alle praterie. Gli eventi estremi climatici, in particolare le alte temperature come quelle che hanno causato questʼanno in Russia estesi incendi boschivi o come le caldi estati del 2003 e 2006 nel continente europeo possono essere alleviate mediante lʼevaporazione dagli ecosistemi vegetali. Finora, si riteneva che le foreste portassero ad un raffreddamento maggiore dellʼaria in quanto sono in grado di accedere più facilmente allʼacqua grazie alla loro sistemi di radici profonde. Il nuovo studio, tuttavia, ha ora rivelato che allʼinizio di una ondata di calore sono le praterie a raffreddare più rapidamente lʼatmosfera.
Nellʼarticolo si mira a quantificare quando e in che misura il suolo degli ecosistemi forestali e delle praterie hanno un ruolo nella regolazione della temperatura. Lo studio rivela che allʼinizio di una ondata di caldo, le praterie e i terreni agricoli sono più efficaci delle

paradosso delle foreste durante le ondate di calore
Una estesa rete di misurazioni in Europa dimostra come differenti coperture vegetali rispondano in maniera diversa ai picchi di temperatura durante le ondate di calore.
foreste nel raffreddamento della temperatura dellʼaria attraverso lʼevaporazione dellʼumidità del suolo, a condizione che i livelli di umidità del suolo siano sufficientemente elevati.
Peril loro studio, gli scienziati hanno analizzato i dati delle stazioni della rete mondiale FLUXNET, di cui FEM partecipa con tre siti in prateria (Monte Bondone), foresta (Lavarone) e vigneto (Valle dellʼAdige) che misurano il calore turbolento e i flussi dʼacqua. Lʼobiettivo era di valutare in che misura lʼenergia solare disponibile viene convertita in riscaldamento dellʼatmosfera o in alternativa in evaporazione dellʼacqua durante le ondate di calore.

Lemisurazioni hanno consentito agli scienziati di confrontare il comportamento di praterie, terreni agricoli e foreste in presenza di forti anomalie termiche. I risultati mostrano come nelle giornate più
calde, nelle praterie evapora il doppio di acqua rispetto alle foreste. Il flusso di calore sensibile, che riscalda lʼaria direttamente, è dunque notevolmente più alto sopra le foreste, che negli altri ecosistemi.
in grado di sostenere un livello costante di evapotraspirazione per un periodo di tempo più lungo, grazie anche a radici più profonde, a mostrare una maggiore capacità di raffreddamento dellʼatmosfera.
fase iniziale quindi la foresta riscalda maggiormente lʼatmosfera rispetto alle praterie, che utilizzano più energia per far evaporare lʼacqua dal suolo. Analizzando i dati delle estati 2003 e 2006, caratterizzate da elevate temperature, si è scoperto che le foreste durante queste ondate di calore riscaldavano lʼatmosfera fino a quattro volte più intensamente rispetto alle praterie e ai terreni coltivati.
Tale effetto in realtà è evidente nelle prime fasi delle ondate di calore quando lʼacqua disponibile nel terreno permette alle praterie un raffreddamento significativo dellʼaria. Successivamente, una volta asciugato il suolo, sono le foreste,
scienziati attribuiscono la differenza di comportamento tra foreste e praterie al fatto che la foresta gestisce lʼapprovvigionamento di acqua in modo più prudente. Le piante forestali hanno sviluppato strategie diverse rispetto a quelle erbacee in reazione alle ondate di calore o siccità. Grazie a cellule di protezione attorno agli stomi, presentano comportamenti meno dispendiosi dellʼacqua.
Secondo gli scienziati la foresta gioca comunque un ruolo importante durante i periodi caldi, poiché nel lungo periodo ha un effetto stabilizzante, anche se amplifica il riscaldamento dellʼaria nella fase iniziale.
Lo studio ha considerato i profili pluri-annuali di δ18O di sei laghi (Caldonazzo, Levico, Lavarone, Santo di Cembra, Serraia and Tovel) caratterizzati da diversi regimi idrologici (tempi di rinnovo > o < ad 1 anno) e diversa grandezza (> o < 50 ha). Le differenze riscontrate nei profili isotopici lungo la colonna dʼacqua tra anni e strati hanno permesso di interpretare meglio lʼentità di rinnovo idrico del lago, di mescolamento, stratificazione e di infiltrazione dalla falda. In base ai dati ottenuti, si è proposto uno schema generale del pattern stagionale diδ18O in laghi temperati di diversa dimensione.
[Federica Camin, Giovanna Flaim]

Lo sviluppo di metodi biomolecolari rapidi ed accurati risulta di cruciale importanza per la sorveglianza epidemiologica ed il controllo di malattie trasmesse da artropodi vettori. Lʼavvento di nuove tecnologie high-throughput per sequenziamento del DNA ha reso possibile un approccio innovativo, così definito metagenomico, già sperimentato con successo su campioni ambientali, che mira al recupero di specifiche sequenze bersaglio (es. comunità microbica) allʼinterno di grandi librerie genomiche, evitando lʼisolamento e il clonaggio di specie target. Tale approccio è stato applicato per la prima volta e in collaborazione con il Professor Stephan Schuster (Pennsylvania State University) per lʼidentificazione e la caratterizzazione della comunitá microbica associata a I. ricinus. I risultati ottenuti hanno rilevato unʼinaspettata ed ampia variabilità microbica associata a I. ricinus ed hanno evidenziato lʼefficacia di un approccio metagenomico nellʼidentificare simultaneamente patogeni, artropodi endosimbionti e altri microorganismi non associati in precedenza a tale vettore.
[Giovanna Carpi]
Soil Carbon Dynamics (an integrated methodology) è un libro che sintetizza il lavoro svolto da un gruppo internazionale di ricercatori durante una summer school dellʼEuropean Science Foundation svoltasi nel 2004 allʼex Centro di Ecologia Alpina. Oltre a fornire una panoramica sui maggiori temi legati al ciclo del carbonio nel suolo, il libro introduce nuove metodologie relative alla scelta degli schemi di campionamento, allʼutilizzo degli isotopi stabili e alle tecniche di indagine molecolare. Nel capitolo 4 viene affrontato il problema della determinazione degli stocks e delle variazioni del carbonio del suolo, una tematica di notevole interesse sia in relazione al ciclo globale del carbonio che alle politiche legate ai cambiamenti climatici.
[Mirco Rodeghiero]
VIBURNUM LANTANA L.
II risultati di ricerche sugli effetti fitotossici dellʼozono svolte sia in ambiente controllato sia utilizzando piante O3-sensibili introdotte ad hoc (biomonitoraggio) non sempre sono utili ad interpretare le risposte della vegetazione spontanea in condizioni di campo. Per ovviare a ciò abbiamo considerato la specie spontanea Viburnum lantana, che presenta comprovati sintomi ozono-specifici. I risultati mostrano una maggiore frequenza di piante sintomatiche, precoce insorgenza e sviluppo più rapido dei sintomi nei siti con i livelli di O3 più elevati. Lo studio mira a capire se V. lantana possa essere usata per valutare lʼimpatto dellʼO3 sulla vegetazione spontanea in condizioni reali.
[Elena Gottardini, Fabiana Cristofolini, Antonella Cristofori]
HarvAssist è un sito web creato da Roberto Zorer e Luca Delucchi del CRI e da Roberto Larcher e Giorgio Nicolini del Centro Trasferimento Tecnologico FEM, in collaborazione con Cavit s.c., per assistere i viticoltori nella scelta del momento migliore per la vendemmia e per lo studio della vocazionalità del territorio. Il portale, sviluppato utilizzando software open source, si basa su un geodatabase sviluppato in collaborazione con il CNRIbimet di Firenze e su una semplice interfaccia web per la gestione e la visualizzazione dei dati. Infine una applicazione webGIS permette di visualizzare i vigneti in mappa, recuperare i principali dati chimico-analitici e ricevere le proiezioni del momento ideale per la vendemmia, grazie allʼimplementazione di modelli di maturazione basati su indici bioclimatici.
[Roberto Zorer, Luca Delucchi]http://harvassist.fmach.it
DEI DATI PER UNA SCIENZA
MIGLIORE: LʼESPERIENZA
DELLA PIATTAFORMA
SOFTWARE EURODEER
EURODEER è un progetto di condivisione di dati spaziali di animali marcati (caprioli dotati di collari satellitari GPS o VHF) sviluppato e coordinato da FEM (Dr. Francesca Cagnacci). Dopo la presentazione al Convegno sul Capriolo Europeo ad Edinburgo nel luglio 2009, lʼiniziativa ha riscosso una corale adesione da parte dei gruppi di ricerca europei che studiano lʼecologia spaziale di questo ungulato. Nel 2009, sono stati integrati i dati provenienti da 12 aree di studio di 10 paesi, per un totale di circa 300 individui e 700.000 localizzazioni. Il database spaziale, grazie alla collaborazione del gruppo IT, è localizzato su server FEM.
[Francesca Cagnacci]
http://www.eurodeer.org
Immaginavate che gli ecosistemi del Trentino garantissero a ogni residente un “servizio” pari al valore di circa 6.000 € ogni anno? La funzione di ricarica delle falde, di prevenzione dalle piene, la funzione ricreativa o quella di pollinazione sono solo alcuni dei “servizi ecosistemici” che sono stati stimati. Si tratta di uno studio interdisciplinare il cui obiettivo non è mettere sul mercato ma valorizzare e riconoscere benefici che gli ecosistemi garantiscono alle comunità umane, animali e vegetali. Da questi “servizi” dipendono la qualità di vita e lo sviluppo economico dei nostri territori. Lʼobiettivo finale è quello di renderli comprensibili alla società, attraverso un peso comune come la moneta, per poterli integrare nelle scelte di pianificazione e gestione del territorio e delle sue risorse. In particolare questa iniziativa, lanciata dalla FEM insieme allʼUniversità del Salento e a quella di Urbino, si prefigge di valutare anche le variazioni occorse in Italia dal 1990. [Rocco Scolozzi]

ADATTAMENTO
La comprensione delle interazioni tra sistemi naturali ed umani risulta essere un tema sempre più pressante specialmente alla luce dei cambiamenti che possono colpire un territorio. La conoscenza delle dinamiche del passato che ci hanno permesso di caratterizzare il paesaggio, i valori delle società e le attività economiche sono indicatori di come i sistemi naturali ed umani siano unitamente correlati. Una sfida di assoluto rilievo per le aree montane ed in particolare per quelle Dolomitiche che recentemente sono state individuate come “Bene dellʼUmanità” da parte dellʼUNESCO. Di questo si è discusso il 10 luglio 2009 in un workshop internazionale, realizzato allʼinterno del progetto OPENLOC “Politiche pubbliche e sviluppo locale” finanziato dalla Provincia Autonoma di Trento. [Alessandro Gretter]
http://www.openloc.eu
Monitorare i flussi del carbonio per intervenire sulla riduzione dei gas serra in atmosfera al fine di prevenire gli effetti del surriscaldamento globale: questo lʼobiettivo del nuovo progetto GHG -Europe (GreenHouseGas-Europe) finanziato dallʼUnione Europea. Partendo dallʼanalisi dei quantitativi di anidride carbonica, metano e ossidi di azoto presenti nelle foreste, nei terreni coltivati, nelle praterie, negli arbusteti, nelle torbiere e nei suoli, il progetto GHG-Europe si propone di migliorare le conoscenze e la capacità di predizione degli assorbimenti e delle emissioni di gas serra in Europa, e di proporre migliori forme di gestione degli ecosistemi perché assorbano più anidride carbonica.

[Damiano Gianelle]
→
Il progetto EULAKES è stato selezionato nel 2009, nellʼambito delle attività promosse dal Central Europe Programme della Comunità Europea. Le attività di ricerca, che avranno una durata di tre anni, hanno preso avvio allʼinizio del 2010. Lo scopo generale del progetto è di promuovere un nuovo approccio di gestione integrata e sostenibile dei grandi laghi europei. Le attività saranno coordinate e condotte da diverse istituzioni in Italia, Austria, Ungheria e Polonia.
Il Centro Ricerca e Innovazione avrà il compito di promuovere ricerche sullʼecologia dei cianobatteri, sulla diversità, stagionalità e impatto delle tossine algali, e sulla ricostruzione delle condizioni ecologiche dei corpi lacustri in epoche storiche.
[Nico Salmaso]
Nel maggio 2009 è stato pubblicato il libro ʻPopulation Genetics for Animal Conservationʼ nella collana Biologia della Conservazione della Cambridge University Press, curato da G. Bertorelle (Università di Ferrara, I), M.W. Bruford (University of Cardiff, UK) e tre ricercatori FEM (H.C. Hauffe, A. Rizzoli, C. Vernesi). A partire da un convegno internazionale organizzato da ricercatori FEM, il libro intende rendere accessibili i risultati delle discussioni a studenti, ricercatori e gestori delle risorse naturali. Il volume integra lʼapproccio dei metodi analitici con quello dei problemi pratici di genetica della conservazione. Nei 15 capitoli curati da 30 esperti internazionali vi è un esauriente riassunto dello stato dellʼarte della genetica della conservazione e si evidenziano le potenzialità e lʼutilità della sinergia fra la stessa e la biologia della conservazione.
[Cristiano Vernesi, Heidi C. Hauffe]
Per la prima volta Museo Tridentino di Scienze Naturali, Slow Food Trentino e Fondazione Edmund Mach si sono unite per proporre al pubblico in modo giocoso il tema del cibo, locale e di qualità. Si tratta del progetto ʻDecidePubʼ, una versione adattata del gioco diffuso a livello europeo Decide, che sempre più spesso viene proposto per comunicare tematiche scientifiche. Lo scopo è mescolare lʼapproccio divertito e rilassato degli incontri in ambienti informali, affollati e rumorosi (pub, osterie, caffetterie o mense scolastiche), con gli aspetti riflessivi alla base del formato originale di Decide. Tutto ciò per permettere ai giocatori, mentre assaporano formaggi e vino, di riflettere su temi controversi riguardanti la produzione, la distribuzione e il consumo di cibo, con le loro implicazioni ecologiche, sociali ed economiche. Il progetto, finanziato dalla Commissione Europea nellʼambito del fondi FUND, si propone di favorire la discussione in quei momenti della giornata, come a tavola, in cui le persone sono ben disposte allo scambio informale di idee, alla discussione e aperte a nuovi stimoli.
[Floriana Marin, Alessandro Gretter]http://www.playdecide.eu/play/inspiringstories/1084
Lʼevoluzione e lʼadattamento delle specie e delle popolazioni sono ostacolati in assenza di un adeguato livello di diversità genetica. Eppure i piani di conservazione e gestione spesso non considerano la biodiversità a livello genetico. Per questo un consorzio europeo è stato istituito sfruttando i fondi del programma UE FP7 ConGRESS. Lʼobiettivo è di creare un ponte tra gli scienziati e coloro che sono chiamati ad occuparsi della gestione delle risorse naturali, per sfruttare appieno le potenzialità degli studi genetici. Il progetto avrà durata di tre anni (2010-2013). Il gruppo di Genetica della Conservazione del CRI-FEM guida uno dei più importanti work-packages, quello dedicato allʼorganizzazione di workshop e seminari volti a far incontrare scienziati e decisori.
[Cristiano
Vernesi]Processi di comunicazione e interazione tra specie ed ecosistemi: conoscere per intervenire
Negli ecosistemi, anche in quelli profondamente modificati dagli interventi umani come gli ambienti agrari, esiste una fittissima rete di segnali utilizzati dalle specie che li abitano. Queste diverse forme di linguaggio permettono la comunicazione sia tra individui di una stessa specie sia tra quelli, vegetali o animali, di specie diverse, legate da rapporti trofici di molteplice natura.
Ad esempio molte piante emettono sostanze tossiche o repellenti contro patogeni e fitofagi ma allo stesso tempo diffondono nellʼambiente composti metabolici volatili che attraggono anche gli organismi utili (predatori o parassitoidi) e gli impollinatori. Nella fillosfera e nella rizosfera lʼequilibio tra i diversi microrganismi è garantito da una complessa serie di meccanismi. Dʼaltra parte gli insetti utilizzano, per guidare lʼincontro tra i sessi e lʼaccoppiamento, specifici stimoli olfattivi o meccanici (feromoni, vibrazioni) e nelle società più complesse, come quelle delle api, adottano meccanismi neurofisiologici e forme di comunicazione sorprendentemente simili a quelle degli animali superiori.
Quanto più specifici e complessi sono tali rapporti, tanto più gli input antropici sono in grado di alterarli. É quello che sta avvenendo in questi anni con il declino degli insetti pronubi o lo scoppio di epidemie di nuove malattie delle piante.
Il Trentino e la FEM sono stati pionieri nello studio delle modalità di comunicazione delle specie di interesse agrario e sono attualmente allʼavanguardia internazionale nellʼapplicazione di strategie di controllo che agiscono interferendo con questi codici, come ad esempio la confusione sessuale contro le tignole della vite.
Gli studi in corso, di cui qui presentiamo alcuni aspetti, sono essenziali per ottimizzare i metodi fin qui realizzati, per adattarli ai cambiamenti climatici in corso e per metterne a punto di innovativi contro le avversità emergenti. Un ulteriore obiettivo è comprendere come fattori esterni influenzino i delicati equilibri neurobiologici delle specie oggetto di studio e le interazioni tra micorganismi. Le informazioni disponibili permetteranno di agire più rapidamente contro quegli organismi estranei che, a causa delle mutevoli condizioni ambientali e della globalizzazione degli scambi e del commercio, continuamente invadono i nostri ambienti, e nei confronti dei quali è necessaria una sempre maggiore sorveglianza.
Lo scopo finale è di integrare le conoscenze sulle interazioni tra specie e ambiente con quelle sulla biologia delle piante, che derivano dalla codifca dei genomi che si stanno acquisendo alla FEM, per permettere una gestione economicamente ed ecologicamente sostenibile degli agroecosistemi.
Focus on part_4 Interactions in living systems Introduzione
Le api sono gli insetti più importanti per lʼecosistema terrestre. Esse forniscono un contributo essenziale allʼimpollinazione di circa lʼ80% delle piante. Una consistente diminuzione nelle popolazioni di api potrebbe causare drastiche riduzioni nelle produzioni agricole.

In effetti le popolazioni di api stanno drammaticamente riducendosi in tutto il mondo e gli scienziati non hanno ancora individuato una causa scatenante del declino, che potrebbe essere invece dovuto a numerose concause.
Molti di questi possibili fattori sembrano interagire direttamente con il sistema nervoso olfattivo degli insetti, interferendo con memoria ed abilità cognitiva. Comunque, i meccanismi di queste interazioni sono finora solo ipotetici. Quindi la comprensione dei meccanismi neurofisiologici coinvolti in percezione, trasduzione ed elaborazione degli stimoli olfattivi nelle api è di fondamentale importanza e rappresenta lo scopo del nostro progetto.
In particolare stiamo indagando le asimmetrie nella percezione ed apprendimento olfattivo. Il fenomeno dellʼasimmetria destra-sinistra delle strutture neurali è associato con le abilità cognitive
ed è comune e ben studiato nei vertebrati. Asimmetrie cerebrali negli insetti sembrano essere correlate con la memoria a lungo termine.
Inoltre è stato recentemente dimostrato che lʼesistenza di popolazioni di animali sociali lateralizzate può essere una strategia evolutiva utile a coordinare il loro comportamento con quello di altri organismi asimmetrici.
Perverificare la validità di questa ipotesi anche fra gli insetti stiamo conducendo uno studio comparato su tre differenti specie di api con diverse strutture sociali: lʼape mellifera Apis mellifera, specie eusociale perenne, il bombo, Bombus terrestris, sociale annuale, e lʼosmia Osmia cornuta, specie solitaria.
Talericerca è in collaborazione con il centro Mente/Cervello (CIMeC) ed il Dipartimento di Fisica dellʼUniversità di Trento.
Gli scopi del progetto sono anche perseguiti da una nuova struttura di ricerca in condivisione tra FEM e CIMeC, il Laboratorio di Neurobiologia e Neurofisiologia degli Invertebrati.
Sono state effettuate registrazioni elettroantennografiche (EAG) utilizzando diversi stimoli odorosi e sono stati condotti biosaggi di richiamo della memoria dopo condizionamento ad odori utilizzando il riflesso di estensione della proboscide (PER) con una singola antenna in uso. I risultati mostrano un significativo maggiore successo nel richiamo del PER e risposte EAG più elevate con lʼantenna destra rispetto alla sinistra a livello di popolazione nellʼape ma non nellʼosmia.
Analisi delle antenne tramite microscopio elettronico a scansione supportano le asimmetriche periferiche nellʼape, rivelando significative differenze morfologiche ed un numero maggiore di sensilli
olfattivi sullʼantenna destra rispetto alla sinistra. I bombi invece presentano una significativa asimmetria di popolazione a destra per quanto riguarda i compiti di apprendimento PER e solo una tendenza ad un superiore numero e sensibilità delle strutture olfattive sullʼantenna destra rispetto alla sinistra.
Talestudio è il primo contributo nella comprensione dellʼevoluzione delle asimmetrie di popolazione in relazione alle differenti pressioni selettive collegate allʼorganizzazione sociale negli insetti. Lo scopo ultimo del lavoro è la salvaguardia degli impollinatori.

Decifrare i meccanismi cognitivi degli insetti è fondamentale per la loro gestione: le asimmetrie cerebrali nelle api sono correlate con la memoria a lungo termine
Molti insetti comunicano mediante vibrazioni che viaggiano attraverso il substrato e che, nel caso dei segnali con valenza sessuale, portano essenzialmente due informazioni: chi e dove. Caratteristiche come la frequenza, lʼintensità e il ritmo di emissione della vibrazione costituiscono elementi di elevata specie-specificità con cui un maschio è in grado di identificare una femmina della stessa specie e rintracciarla sulla pianta ospite.
Lo studio dettagliato dei sistemi di comunicazione negli insetti rappresenta la chiave per accedere ai meccanismi base che determinano le dinamiche del relativo modello comportamentale.
Interferire con la comunicazione di una data specie può significare comprometterne il successo riproduttivo. Sebbene finora la confusione sessuale sia stata attuata esclusivamente mediante feromoni, cioè odori, in realtà il principio che le sta alla base è applicabile anche ad altri sistemi comunicativi. Nel caso di insetti comunicanti con vibrazioni si possono immettere nel substrato, cioè nella pianta ospite, dei segnali “mascheranti”

La comunicazione con segnali vibrazionali via-substrato. Immettendo segnali di mascheramento specifici nelle piante è possibile applicare la confusione sessuale contro gli insetti nocivi
in grado di interferire coi segnali sessuali prodotti dagli insetti. Scaphoideus titanus Ball è la cicalina vettore del fitoplasma della flavescenza dorata, pericolosa malattia della vite. Contro questo insetto è in vigore una normativa che prevede la lotta obbligatoria, con conseguente impiego massiccio di insetticidi.
Questo va in parte a vanificare i benefici dovuti ad anni di impiego della confusione sessuale contro le tignole, laddove lʼuso della lotta chimica era stato ridotto drasticamente nel tempo.
In scafoideo lʼaccoppiamento è vincolato ad uno scambio di segnali vibrazionali tra i sessi. La specie si caratterizza anche per una marcata rivalità sessuale in cui un maschio cerca di “mascherare” i segnali comunicativi dellʼaltro attraverso lʼemissione di specifici segnali di disturbo.

Di fatto il rivale interrompe efficacemente la comunicazione in atto tra una coppia allo scopo di sostituirsi allʼaltro maschio nel ruolo di corteggiatore.
Seguendo questo esempio fornitoci dalla natura abbiamo riprodotto il segnale di rivalità tra maschi e per mezzo di trasduttori elettromagnetici collegati ai fili di sostegno delle piante lo abbiamo trasmesso ininterrottamente per 16 ore a viti infestate da coppie di scafoideo.
Dopodiché le femmine sono state raccolte e successivamente dissezionate per controllare il numero di uova negli ovarioli e verificare un eventuale avvenuto accoppiamento. Ne è risultata una notevole efficacia con la quasi totale inibizione degli accoppiamenti, a fronte dellʼalto tasso di accoppiamenti avvenuti tra i soggetti non trattati. Ulteriori
esperimenti di confusione vibrazionale sono in corso e il potenziale di sviluppo appare notevole, soprattutto per quanto riguarda la strumentazione e le strategie applicative.
Lʼapplicazionedi una tecnica di questo tipo, che si basa su principi puramente fisico/meccanici, aprirebbe nuovi scenari nel campo della difesa sostenibile delle colture agrarie con lʼauspicio in futuro di sostituire o almeno implementare le attuali strategie che prevedono lʼintervento chimico.
Lo studio del ruolo delle sostanze volatili nei rapporti tra insetti e loro piante ospiti è di importanza fondamentale. I metaboliti secondari delle piante, tra i quali le sostanze volatili emesse dalle piante stesse, sono segnali utilizzati dagli insetti erbivori per localizzare le piante ed ovideporre.
Abbiamo ipotizzato che queste sostanze siano un segnale che dà allʼinsetto informazioni sulla qualità nutrizionale della pianta.
Èdi conseguenza probabile che la flora microbica presente sulla pianta possa alterare sia tale segnale che la qualità nutrizionale della pianta. Per provare questi concetti, abbiamo utilizzato come insetto modello la tignoletta dellʼuva (Lobesia botrana) e abbiamo misurato la preferenza per lʼovideposizione di questo insetto fitofago verso uva inoculata con diversi microorganismi isolati dallʼuva stessa (patogeni e saprofiti).

Inseguito, abbiamo quantificato il valore nutrizionale del substrato allevando le larve dellʼinsetto sul substrato stesso e misurandone i valori di fitness. La preferenza per lʼovideposizione è risultata correlata con
Gli insetti
in grado di riconoscere la qualità del loro cibo dagli odori
sono
la fitness. In particolare, elevati valori di fitness e di preferenza per lʼovideposizione sono stati osservati nei confronti di lieviti saprofiti, mentre valori di fitness ridotti e repellenza per lʼovideposizione sono stati misurati per un fungo patogeno (Botrytis cinerea).
Ingenerale, attraverso questo studio abbiamo confermato la nostra ipotesi iniziale che le sostanze volatili siano un segnale della qualità del substrato e che i microorganismi presenti sulla pianta possano modificare tale qualità ed il relativo segnale.
Oltre allʼolfatto, gli insetti potrebbero infatti utilizzare altri sensi, quali vista e gusto, per ottenere informazioni sulla qualità delle piante ospiti. Inoltre, la presenza di ulteriori microorganismi potrebbe modificare il rapporto insetto-pianta.

Nonci è inoltre chiaro se la preferenza delle femmine ovideponenti sia interamente imputabile alle prestazioni della progenie oppure sia in parte dovuta ad un incremento della fitness delle femmine stesse.
risultati confermano unʼaltra ipotesi formulata in letteratura, secondo la quale le femmine ovideponenti si siano evolute per deporre le loro uova su substrati che garantiscano lo sviluppo della progenie (preference-performance hypothesis, PPH). La nostra conoscenza su questo argomento rimane comunque non del tutto completa.
Lostudio dei segnali odorosi rilasciati dai siti di ovideposizione consentirà di comprendere i meccanismi che guidano gli insetti durante la fase di ovideposizione. Lʼidentificazione di questi segnali odorosi potrà essere una base per la messa a punto di nuovi sistemi a basso impatto per la gestione degli insetti fitofagi.
Nella moltitudine di odori che li circondano, gli insetti devono essere in grado di percepire e rispondere alle sostanze biologicamente attive: tra queste i feromoni sessuali, che mediano la comunicazione intraspecifica, ed i volatili della pianta, o cairomoni, che guidano lʼinsetto verso le fonti di cibo ed i siti di ovideposizione. I semiochimici, sia feromoni che cairomoni, vengono oggi efficacemente impiegati nel controllo di alcune specie dannose, ed in futuro hanno la potenzialità di trovare applicazione in nuovi metodi di difesa ecosostenibili e rispettosi della salubrità dei prodotto agro-alimentari.
Larecezione degli odori negli insetti è mediata da specifici recettori (ORs) espressi sulla superficie dei neuroni (ORNs) che innervano i sensilli olfattivi dellʼantenna. Dopo aver attivato gli ORNs, gli stimoli odorosi vengono trasmessi, sotto forma di segnali elettrici al primo centro di integrazione cerebrale olfattiva, il lobo antennale, e successivamente ai centri superiori di elaborazione, dove vengono codificati in specifici comportamenti. Sofisticati strumenti di analisi consentono di studiare la trasformazione dei segnali olfattivi dalla periferia, a partire dagli ORs, sino alle varie aree del cervello.
Dallʼantenna al cervello:
elevato livello di interazione tra feromoni e sostanze volatili della pianta ospite a livello dei lobi antennali della carpocapsa.

Lacarpocapsa, Cydia pomonella L, è da sempre indicato come insetto chiave per la melicoltura a livello mondiale, ed è stato a lungo un modello per lo sviluppo di metodi di controllo sostenibili. Scopo del progetto è quello di ampliare le nostre conoscenze sul sistema olfattivo di tale specie, attraverso lo studio dei meccanismi molecolari e neurofisiologici che guidano la percezione e lʼintegrazione degli odori.

Lʼapplicazionedi innovative tecniche di indagine consente oggi di comprendere aspetti della comunicazione olfattiva ancora sconosciuti, con potenziali ricadute pratiche in vista di un progressivo sviluppo dei metodi semiochimici. Punto di partenza per lo studio dei meccanismi molecolari è stata lʼidentificazione delle sequenze geniche dei ORs, attraverso uno screening del trascrittoma antennale di maschi e femmine di carpocapsa. DallʼRNA estratto dalle antenne è
stata costruita una libreria di c-DNA, successivamente sequenziata con la tecnologia 454. Il database BLAST ha consentito lʼidentificazione delle sequenze geniche putative degli ORs mediante comparazione con i geni identificati precedentemente in altre specie. Attualmente stiamo lavorando allʼestensione delle sequenze geniche, mediante RACEPCR, ed allʼanalisi della specificità a livello dei tessuti, mediante qPCR. Lʼespressione spaziale e temporale degli ORs ed il loro ruolo funzionale verranno indagati attraverso le tecniche dellʼibridizzazione in sito e dellʼespressione eterologa. Al fine di comprendere i meccanismi neurofisiologici di codifica degli odori, abbiamo studiato a livello anatomico il lobo antennale (AL) della carpocapsa, come base di partenza per gli studi funzionali. La mappa tridimensionale dellʻAL, costruita mediante scansione al microscopio a fluorescenza, ha evidenziato una specifica
organizzazione di unità funzionali, i glomeruli, responsabili della prima elaborazione olfattiva a livello celebrale. Registrazioni elettrofisiologiche, effettuate mediante la tecnica dellʼIntracellular Recordings, hanno consentito di analizzare la risposta di singoli neuroni a diverse componenti del feromone sessuale e ad alcune sostanze volatili del melo note per essere attrattive per la carpocapsa. I risultati ottenuti combinando i dati morfologici e funzionali mostrano un pattern di attivazione a livello dellʼAL caratterizzato da un elevato grado di interazione tra feromoni e cairomoni. Le indagini attuali si stanno focalizzando su unʼanalisi dettagliata, sia a livello neurofisiologico che comportamentale, dellʼinterazione tra miscele di odori con il fine ultimo di identificare nuove sostanze attrattive per la specie.

Nel
mondo si sta verificando un aumento senza precedenti delle malattie infettive dellʼuomo. Almeno la metà delle malattie infettive fino ad oggi conosciute può essere classificata come “emergente” perché appena scoperta, per il rapido aumento dellʼincidenza o della prevalenza, per lʼespansione geografica o climatica del suo areale o per la trasmissione da popolazioni animali allʼuomo. AIDS, SARS, influenza aviaria, malattie trasmesse da zecche (Malattia di Lyme e lʼencefalite), virus Pox, virus Nipah e virus West Nile sono solo alcuni esempi di malattie infettive emergenti (EID) che si sono trasferite dal ciclo selvatico allʼuomo, causando importanti epidemie in diverse aree del pianeta. I principali fattori che influenzano questo aumento sono i cambiamenti nellʼuso del territorio, i cambiamenti climatici, la perdita di biodiversità e lʼaumento degli spostamenti su scala globale, con conseguente mescolamento di uomini e animali.
fattori hanno aumentato il rischio di emergenza e trasmissione di queste malattie con gravi conseguenze sociali, politiche ed economiche a livello planetario. Le malattie infettive più rilevanti a livello eu-
ropeo negli ambienti alpini sono le malattie trasmesse da artropodi vettori (come zecche e zanzare) e da roditori e uccelli. Il nostro gruppo di ricerca, Ecohealth, studia lʼecologia di queste malattie partecipando a una serie di progetti di ricerca internazionali finanziati dalla Comunità Europea (ad esempio il Progetto EDEN del 6°Framework http://www.eden-fp6project.net).
Alcune delle nostre ricerche hanno evidenziato come si stia verificando un aumento delle zecche negli ambienti naturali e una loro espansione verso altitudini più elevate, principalmente a causa dei cambiamenti climatici, della struttura forestale e dellʼabbondanza di ungulati. Questi mutamenti hanno favorito la creazione di condizioni climatiche e di habitat più favorevoli alle zecche e aumentato il rischio di contatto tra le zecche, i loro ospiti e lʼuomo, spiegando così lʼaumento di alcune malattie quali
lʼencefalite da zecche, nota come TBE. Le analisi genetiche effettuate presso i nostri laboratori hanno mostrato che alcuni ceppi del virus TBE trovati in Trentino sono diversi da quelli europei.
LaTBE viene trasmessa allʼuomo principalmente da zecche che hanno contratto lʼinfezione cibandosi su roditori selvatici, in particolare il topo selvatico dal collo giallo (Apodemus flavicollis).
I roditori degli ambienti agrari e forestali possono trasmettere allʼuomo anche altre malattie.

Recentemente abbiamo trovato che il virus della coriomeningite linfocitaria (LCMV), trasmesso dal topo domestico (Mus musculus domesticus), è diffuso nelle Alpi centrali e orientali, compreso il Trentino, in diverse specie di roditori selvatici (ad esempio A. flavicollis e Myodes glareolus). Inoltre il nostro gruppo ha rinvenuto per la prima volta in Italia il virus Ljungan, recentemente
descritto e associato ad alcune malattie delle donne in gravidanza e al diabete di tipo 1.
stiamo studiando lʼecologia e lʼepidemiologia di queste malattie nella nostra regione. I risultati preliminari indicano chiaramente lʼimportanza di mantenere unʼelevata soglia di attenzione e di proseguire negli studi sulla potenziale evoluzione a scala regionale di queste gravi malattie. I risultati fungono da supporto per il personale medico e sanitario che deve identificare e combattere queste malattie spesso di difficile riconoscimento. Inoltre sono utili a livello decisionale, per far comprendere meglio il ruolo funzionale della biodiversità e indirizzare gli interventi gestionali verso una riduzione dellʼimpatto delle attività economiche sulla biodiversità.
Moderne tecniche di biologia molecolare e di modellistica matematica per prevenire la diffusione di malattie della fauna selvatica trasmissibili allʼuomo in un contesto di rapidi cambiamenti globali.
Nella storia della scienza, i rapidi avanzamenti concettuali sono spesso stati indotti da quelli tecnologici. Una nuova, stimolante sinergia tra lʼecologia animale e la radiotelemetria basata sullʼuso della tecnologia GPS è presentata nel numero tematico di Philosophical Transactions della rivista the Royal Society B, intitolato “Challenges and opportunities of using GPS-based location data in animal ecology”, curato da Francesca Cagnacci, Luigi Boitani, Roger A. Powell e Mark S. Boyce.
In ecologia animale, la realtà è osservata alla stessa scala spazio-temporale dellʼosservatore. Tuttavia, lʼosservazione diretta da parte dellʼuomo non permette di ottenere dati sufficientemente quantitativi e standardizzati, tali da consentire la falsificazione di ipotesi e la soluzione di domande di ricerca. Un approccio intuitivo, ma rivoluzionario è allora di spostare il punto di osservazione dallʼosservatore, allʼosservato, ossia gli animali oggetto di studio. La biotelemetria, ossia la misura remota di variabili di stato di animali allo stato libero, è la controparte tecnologica di tale approccio, che consente di affrontare lo studio dellʼecologia di grandi animali allo stato libero, in

modo meccanicistico. Tra le variabili che possono essere misurate, la posizione degli animali nello spazio è un modo intuitivo e immediato di porli in relazione con lʼambiente che occupano.
Unproblema fondamentale di ricerca è la comprensione di quali fenotipi (o adattamenti) siano richiesti a un animale per sopravvivere o stare in un certo luogo, in un certo momento (quali sono le conseguenze per lʼanimale nello stare in quel luogo? Perché si trova lì?). Le localizzazioni spaziali degli animali sono lʼelemento unitario delle traiettorie di spostamento, e mostrano dove gli animali interagiscono con il resto dellʼecosistema. Di fatto, rappresentano il punto di contatto “live” tra lʼecologia e lʼevoluzione. Le nuove tecnologie biotelemetriche consentono di tracciare in dettaglio gli spostamenti degli animali, assicurando grande quantità e qualità di dati anche per animali estremamente elusivi.

I l Global Positioning System (GPS), in particolare, ha molti vantaggi, tra cui la possibilità di tracciare in modo continuo specie terrestri, avicole o marine durante tutte le fasi cruciali della loro vita, ossia mentre si muovono, disperdono, migrano, selezionano risorse, si nutrono, competono, si riproducono, muoiono.
Èalquantoprobabile che, in un futuro non distante, il campionamento intensivo degli spostamenti animali consentirà di ricostruire la mappa cognitiva del loro habitat, e la relazione intrinseca tra il comportamento, e la fitness Questa promettente sinergia tra scienza e tecnologia sta rapidamente ristrutturando alle fondamenta la disciplina dellʼecologia animale in quanto tale. Il numero tematico di Philosophical Transactions of the Royal Society B presenta lo stato dellʼarte dei metodi analitici e introduce sintesi originali per lʼuso delle
localizzazioni animali. In particolare, gli autori spiegano come questi dati di maggior qualità e quantità rispetto a quanto disponibile in passato, aiutino gli scienziati nella ricerca di una spiegazione meccanicistica dei concetti chiave e delle nuove eccitanti linee di ricerca in ecologia animale.
Ilmessaggio conclusivo è che solo lʼintegrazione di strumenti tecnici e analitici avanzati in un solido e fondante contesto teoretico consentiranno di affrontare lʼintrinseca complessità degli ecosistemi e la loro fragilità in un pianeta che cambia.
animale incontra la radio-telemetria GPS: una sfida stimolante e promettente
Le piante producono metaboliti secondari che giocano un ruolo fondamentale nei meccanismi biologici di difesa costitutiva contro insetti e patogeni. Le piante officinali sono unʼinteressante risorsa di metaboliti ad attività antimicrobica. Abbiamo evidenziato che lʼestratto di Salvia officinalis possiede un elevato potere anticrittogamico nei confronti di Plasmopara viticola e associato questʼattività a due diterpeni: sclareol e manool. La produzione di queste molecole attive mediante colture cellulari in bioreattori ci permetterà di ottenere in modo economico prodotti naturali, rinnovabili, biodegradabili e a basso impatto ambientale che garantiscono allo stesso tempo unʼelevata protezione delle piante.
[Silvia Dagostin, Oscar Giovannini, Silvia Carlin, Ilaria Pertot]I campionamenti condotti dai nostri tecnici hanno permesso di monitorare il processo di espansione della zanzara tigre (Aedes albopictus) in Trentino. Tra i risultati la conferma del trend di crescita nelle Valli dei Laghi e dellʼAdige e lʼindividuazione di primi focolai a Trento. La dinamica stagionale e la distribuzione di questo insetto è condizionata da fattori climatici, tra i quali la temperatura è la più importante. Tramite lʼanalisi GIS di tali dati ricavati dai satelliti è stato possibile individuare le zone più idonee alla diffusione della zanzara nel nord-est Italia e fornire alle amministrazioni locali indicazioni mirate, indispensabili per avviare piani di prevenzione.
 [David Roiz, Markus Neteler]
[David Roiz, Markus Neteler]
Le relazioni stabilite tra i differenti microrganismi del suolo danno vita ad una fitta rete di interazioni multitrofiche che si riflettono sullʼintero ecosistema terrestre. Il risultato di queste interazioni è una componente fondamentale della qualità del suolo.
Le diverse attività dei microrganismi sono state fino ad ora studiate singolarmente, con tutta la complessità che ne consegue.
Le nuove tecniche di biologia molecolare e di sequenziamento ci permettono ora di considerare la comunità microbica del suolo nella sua globalità, cioè al pari di un unico e grande organismo, le cui funzioni sono la sommatoria delle funzioni dei singoli organismi che lo abitano. Questo nuovo approccio permetterà di sviluppare tecniche più affidabili ed economiche per valutare la qualità dei suoli agrari.
La regolazione genica gioca un ruolo fondamentale nella capacità degli esseri viventi di adattarsi allʼambiente. Il silenziamento posttrascrizionale (PTGS) sta emergendo come fondamentale meccanismo alla base delle risposte allo stress in piante ed animali.
Tramite un approccio comparativo in Brassicacee, abbiamo trovato evidenza del fatto che la maturazione a più fasi del microRNA MIR168 rappresenti un meccanismo conservativo dal punto di vista evolutivo.
 Corneo, Alberto Pellegrini, Claudia Longa, Ilaria Pertot]
Corneo, Alberto Pellegrini, Claudia Longa, Ilaria Pertot]
[Paola
Questo meccanismo probabilmente è coinvolto nella regolazione fine del PTGS anche di altri microRNA associati a stress in piante.
[Claudio Varotto]Il virus Ljungan (LV) è stato rinvenuto 10 anni fa per la prima volta in Svezia, nelle arvicole selvatiche. Solo di recente si è scoperto che esso è in grado di indurre nellʼuomo alcune patologie, tra le quali alcune malattie durante la gravidanza e il diabete di tipo 1. In Italia questo virus è stato segnalato per la prima volta dal gruppo di ricerca di Hauffe, che lo ha rinvenuto sia nellʼarvicola rossastra (Myodes glareolus) che nel topo selvatico dal collo giallo (Apodemus flavicollis). La segnalazione è stata pubblicata nel 2010 sulla rivista scientifica Journal of Wildlife Diseases. Questo ritrovamento ha ampliato di molto lʼareale di diffusione di questo patogeno. Ora la diffusione di questo virus viene monitorata sia a livello locale che europeo. Per rilevare la sua presenza tra i mammiferi selvatici e domestici si utilizza la tecnica della PCR. Studi di laboratorio vengono condotti per riuscire a valutare la sua potenziale importanza come patogeno umano, per identificare le possibili fonti animali del virus e porre così le basi per lo sviluppo di un eventuale vaccino.
[Heidi C. Hauffe]
UNA PROCEDURA AUTOMATICA PER MIGLIORARE LʼACCURATEZZA DEI DATI NELLE ANALISI FILOGENETICHE
È stata sviluppata una nuova tecnica che permette di aumentare lʼaccuratezza negli studi di filogenesi. Essa permette di risolvere i problemi legati alla saturazione sostitutiva dei dati. Questo metodo permette di ricostruire le relazioni tra le diverse specie attraverso percorsi di approfondita analisi del DNA. Il test proposto ha permesso di porre fine ai dibattiti in merito alla diversificazione dei mammiferi placentati. I risultati hanno infatti avvalorato lʼipotesi già ampiamente riconosciuta che la classe dei Glires, ossia dei roditori e dei lagomorfi (lepri e conigli), sia un gruppo evolutivo fratello di quello dei primati, da cui discende lʼuomo. Il lavoro ha ottenuto la copertina della prestigiosa rivista scientifica Journal of Molecolar Evolution.

[Vadim Goremykin, Svetlana Nikiforova]


Negli ultimi decenni in Europa si sta assistendo ad un aumento del diffondersi di malattie trasmesse da vettori. Questo ha indotto la Comunità Europea ad aumentare lo stato di allerta e a stanziare fondi per la ricerca in ambito della “Salute” allʼinterno del VII Programma Quadro.

Eurowestnile è un progetto a piccola scala che coinvolge 14 partner di 7 paesi, che ha lʼobiettivo di sviluppare una rete integrata di ricercatori che si occupino specificatamente del virus West Nile in Europa. I partecipanti devono lavorare per creare nuove conoscenze e prodotti innovativi in grado di controllare e prevenire il diffondersi di questa malattia e che quindi risultino di interesse per i cittadini europei.
EDENext (Biology and control of vector borne infections in Europe) è invece un progetto a grande scala, che coinvolge 46 partner di 22 paesi e che si occupa di individuare quei fenomeni biologici, ecologici ed epidemiologici che favoriscono la comparsa delle malattie trasmesse da vettori.
Lʼobiettivo finale è di riuscire a sviluppare metodi e strumenti per migliorare la prevenzione, la sorveglianza e il controllo delle popolazioni dei vettori e quindi riuscire a limitare la diffusione di malattie che colpiscono lʼuomo e gli animali. [Annapaola Rizzoli]

La nostra ricerca : facts and figures
part_2 Progetti di Ricerca
part_3 Eventi CRI
part_4 Tesi svolte presso FEM
part_5 Premi 09/10
part_6 Presenza nei comitati editoriali
part_7 Pubblicazioni CRI
part_8 Organigramma
Report 09 / 10 71
Our research: facts and figures









43 / Italia
ITALIA
+ Accademia Nazionale dei Lincei, Roma
+ Agenzia Provinciale per la Protezione dellʼAmbiente (APPA), Trento
+ Azienda Provinciale per i Servizi Sanitari (APSS), Provincia Autonoma di Trento
+ Centro per la Biologia Computazionale e dei Sistemi (COSBI), Trento
+ Centro Interdipartimentale Mente e Cervello (CiMeC), Università di Trento

+ CIHEAM, Istituto Mediterraneo di Agronomia, Bari
+ Consiglio Nazionale delle Ricerche (CNR), Roma - Firenze
+ Consiglio per la Ricerca e la Sperimentazione in Agricoltura (CRA), Roma - Follonica - Trento
+ Dimensione Ricerca Ecologia Ambientale (D.R.E.Am. Italia), Pratovecchio
+ European Academy Bozen (EURAC), Bolzano
+ Fondazione Bruno Kessler, Trento

+ ICQ-RF-Ministero delle politiche agricole alimentari e forestali, Roma
+ Istituto per lo Studio degli Ecosistemi, Verbania - Pallanza
+ Istituto Superiore di Sanità (ISS), Roma
+ Istituto Zooprofilattico Sperimentale della Lombardia e dellʼEmilia Romagna “Bruno Ubertini” (IZSLER), Brescia
+ Istituto Zooprofilattico Sperimentale delle Tre Venezie (IZSP), Legnaro
+ Joint Research Centre, Ispra
+ Museo Tridentino di Scienze Naturali, Trento
+ Parco Nazionale dello Stelvio, Bornio - Glorenza - Peio
+ Servizio Foreste e Fauna della Provincia Autonoma di Trento
+ TerraData environmetrics, Siena
+ Università Cattolica del Sacro Cuore, Piacenza
+ Università degli Studi di Bari “Aldo Moro”
+ Università degli Studi di Bologna
+ Università degli Studi della Calabria
+ Università degli Studi di Ferrara
+ Università degli Studi di Firenze
+ Università Politecnica delle Marche
+ Università degli Studi di Milano Bicocca
+ Università degli Studi di Napoli (Federico II)
+ Università degli Studi di Roma “La Sapienza”
+ Università degli Studi di Padova
+ Università degli Studi di Parma
+ Università degli Studi di Pavia
+ Università degli Studi di Piacenza
+ Università degli Studi di Pisa
+ Università del Salento

+ Università degli Studi di Siena
+ Università degli Studi di Trento
+ Università degli Studi di Torino
+ Università degli Studi di Trieste
+ Università degli Studi di Udine
+ Università degli Studi di Urbino “Carlo Bo”
REGNO
UNITO

+ University of Bolton
+ Department of Geography, University College, London
+ Department of Zoology, University of Oxford
+ Faculty of Veterinary Science, Department of Veterinary Pathology, University of Liverpool
+ University of Lancaster
+ University of Leeds
+ University of Manchester
+ NERC Centre for Population Biology, Imperial College London
+ School of Biosciences, University of Cardiff
+ School of Geography, University of Nottingham
+ Scottish Crop Research Institute, Invergrowie
+ UK Commission for Rural Communities, Cheltenham


+ University of East Anglia, Norwich
+ University of Glasgow
+ University of St. Andrews
+ University of York
+ East Malling Research (EMR), East Malling
+ Civil and Environmental Engineering Departement, University College Cork
+ Agence nationale de sécurité sanitaire de lʼalimentation, de lʼenvironnement et du travail (ANSES), Maisons - Alfort Cedex
+ CEMAGREF, Grenoble
+ Centre de Biologie et de Gestion des Populations, Montpellier
+ CIFASIS, French Argentina International Center for Information and Systems Sciences (UPCAM), Marseille

+ Département dʼElevage et de Médecine Vétérinaire, Centre de Coopération Internationale en Recherche Agronomique pour le Développement, Montpellier


+ Direction des Etudes et de la Recherche (ONCFS), Le Perray - en - Yvelines
+ Eurofins Scientific, Nantes
+ Institute National de la Recherche Agronomique (INRA), Angers - Paris - Avignon - Montpellier - Toulose
+ Institut des Sciences de la Vigne et du Vin Bordeaux Aquitaine (ISVV), Villenave dʼOrnon

+ LʼEcole Nationale dʼIngénieurs des Techniques des Industries Agricoles et Alimentaires, ENITIAA, Nantes

+ Laboratory of Biometry and Evolutionary Biology (LBBE), University of C. Bernard, Lyon 1
+ Bavarian Forest National Park, Nürnberg
+ Wilhem Dierking Beerenobst, Gilten
+ Institut für Vergleichende Tropenmedizin und Parasitologie Ludwig-Maximilians-Universitaet, Münich
+ Julius Kühn-Institut (JKI), Dresden
+ Julius Kühn-Institut (JKI), Darmstadt
+ Leibniz-Institute for Zoo and Wildlife Research, Berlin
+ Max Planck Institute for Ornithology, Radolfzell
+ Technischen Universität München, Münich
+ AlPlanta - Institute for Plant Research RLP AgroScience, Neustadt


+ Instituto de Salud Carlos III, Madrid
+ Neiker Instituto Vasco de Investigation y Desarrolo Agrario, Arkaute
+ Museo Nacional de Ciencias Naturales, Departamento Biodiversidad y Biología Evolutiva, Madrid
+ University of Santiago de Compostela
+ University of Trás-os-Montes and Alto Douro
+ Laboratory of Plant Cell Biotechnology, University of Lisbon
+ Department of Biology/CESAM, University of Aveiro SPAGNA


+ Agencia Estatal Consejo Superior de Investigaciones Científicas, Madrid
+ Instituto de Ciencias de la Vid y del Vino (CSIC, University of La Rioja), Logroño
PORTOGALLO
3 / Norvegia
5 / Svezia

2 / Finlandia
1 / Lettonia
1 / Lituania
1 / Polonia
3 / Austria
4 / Ungheria
5 / Svizzera



SVEZIA
+ Swedish University of Agricultural Science (SLU), Umeå Alnarp
+ Swedish Institute for Communicable Disease Control, Solna

+ Univerisity of Lund
+ University of Uppsala
+ Wildlife Research Station, Swedish University of Agricultural Science (SLU), Grimsö

SVIZZERA NORVEGIA
+ Department of Biology, University of Oslo
+ Nofima Mat - Research on food, taste and food for health, Ås
+ Norsk Institutt for Naturforskning (NINA), Trondheim
+ Istituto Scienze della Terra, Scuola Universitaria Professionale della Svizzera Italiana (SUPSI), Canobbio
+ KORA, Bern
+ WSL Swiss Federal Inst. for Forest, Snow and Landscape Research, Birmensdorf
+ Integrative Biology Institute (ETH), Zürich
+ Research Institute of Organic Agriculture (FIBL), Frick
+ University of Debrecen
+ Department of Viral Diagnostics, “Johan Béla” National Centre for Epidemiology, Budapest
+ Hungarian Academia of Science, Budapest
+ University of Pécs
+ Department of Epidemiological Surveillance of Infectious Diseases, Public Health Agency, Riga
+ Finnish Forest Research Institute, Research Centre, Vantaa
+ Haartman Institute, Department of Virology, University of Helsinki
+ Medical University of Bialystok
1 / Estonia
2 / Paesi Bassi
6 / Belgio
REPUBBLICA SLOVACCA
+ Department of Medical Zoology, Slovak Academy of Sciences, Bratislava
LITUANIA
+ Centre for Communicable Diseases Prevention and Control, Vilnius
2 / Repubblica Ceca
1 / Repubblica Slovacca

5 / Slovenia
2 / Croazia
1 / Romania
Focus : on part_1

Il nostro Network Internazionale


+ Laboratory of Medical Entomology, National Institute of Research and Development for Microbiology and Immunology “Cantacuzino”, Bucharest
ROMANIA ESTONIA
+ National Health Development Institute, Department of Virology, Tallinn

REPUBBLICA CECA

+ Academy of Sciences of the Czech Republic, Praha
+ Department of Science and Research, Šumava National Park Admin, Vimperk
+ Institute of Vertebrate Biology (IVB), Brno
AUSTRIA
+ Institut für Ionenphysik und Angewandte Physik, University Leopold Franzens of Innsbruck
+ University of Natural Resources (BOKU), Wien
+ University of Innsbruck
+ Agriculture and Veterinary Information and Analysis, Zoersel
+ Faculty of Biology, Research Group of Evolutionary Biology, University of Antwerp
+ Research Institute for Nature and Forest (INBO), Brussel
+ University of Gembloux
+ University of Ghent
+ University of Liege
BELGIO PAESI BASSI
+ Plant Reserach International, Wageningen
+ RIKILT - Institute of Food Safety, Wageningen
CROAZIA
+ Department of Game Biology, University of Zagreb
+ Institute for Adriatic Crops and Karst Reclamation, Split
SLOVENIA
+ Agricultural institute of Slovenia, Ljubljana
+ Ecological Research and Industrial Cooperation (ERICo), Velenje
+ Institute of Microbiology, Laboratory for zoonoses, Medical Faculty of Ljubljana
+ National Institute of Biology, Ljubljana
+ University of Nova Gorica
+ Annis Water Research Institute (AWRI), Michigan
+ Center for Infectious Disease Dynamics, Penn State University, Pennsylvania
+ Cornell University, Ithaca (New York)
+ Department of Biological Sciences, Murray State University, Kentucky
+ Department of Geography, University of California, Los Angeles (California)
+ Department of Natural Resources, University of Minnesota, St. Paul (Minnesota)
+ Georgia Tech., Atlanta (Georgia)
+ Gulf Coast Geospatial Center, The University of Southern Mississippi
+ Harvard University, Cambridge (Massachusetts)
+ Idaho State University, Pocatello (Idaho)
+ Natural History Museum and Biodiversity Research Center, University of Kansas, Lawrence (Kansas)
+ North Carolina State University, Raleigh (North Carolina)
+ Open Source Geospatial Foundation, Portland (Oregon)
+ Ripon College, Ripon (Wisconsin)
+ Rutgers University, Newark (New Jersey)
+ State University of New York, College of Environmental Science and Forestry, New York
+ Telonics Inc., Mesa (Arizona)
+ TUFTs University, Boston (Massachusetts)
+ U.S. Geological Survey, Science Center, Fort Collins (Colorado)
+ University of California, Berkeley (California)
+ University of Montana, Missoula (Montana)
+ USGS, Anchorage (Alaska)
+ Virginia Bioinformatics Institute, Blacksburg ( Virginia)
+ Washington State University, Pullman (Washington)
+ Canadian Museum of Nature, Ottawa
+ Laval University, Sillery (Quebec)
+ Natural Resources Institute, University of Manitoba, Winnipeg (Manitoba)
+ University of Alberta, Calgary (Alberta)
+ University of Guelph (Ontario)
1 / Giappone Focus on part_1
2 / India
2 / Sud Africa
5 / Israele
1 / Australia
3 / Nuova Zelanda
Il nostro Network Internazionale
+ INEA, Santiago del Chile
+ Laboratorio ECOTONO, Universidad Nacional del Comahue, Bariloche
+ UNL-CONICET, University of Litoral, Santa Fé
ARGENTINA BRASILE
+ Universidade Federal de Santa Catarina, Florianópolis
+ Brazilian Agricultural Research Corporation , Jaguariùna
+ University of Stellenbosch
+ University of Witwatersrand, Johannesburg
+ Ashoka Trust for Research in Ecology and the Environment, Bangalore
+ SHODH: The Institute for Research and Development, Maharashtra
+ CSIRO Plant Industry & Food Futures Flagship, Adelaide
+ Department of Food Science, University of Otago
+ Plant & Food Research Institute, Palmerston North, Oakland
+ Department of Evolution, Systematics and Ecology, The Institute of Life Sciences, The Hebrew University of Jerusalem
+ Department of Geography, Faculty of Social Sciences, The Hebrew University of Jerusalem
+ Volcani Center, Bet-Dagan
+ Weizmann Institute of Science, Tel Aviv
+ University of Haifa
GIAPPONE
+ City University, Osaka

1 PROGETTO finanziato da / FERRERO TRADING LUX SA


1 PROGETTO finanziato da / ASSOCIAZIONE NAZIONALE PER IL MONITORAGGIO E IL CONTROLLO DELLʼAMBIENTE, ITALIA
1 PROGETTO finanziato da / LALLEMAND
1 PROGETTO finanziato da / R&D SYSTEM

1 PROGETTO finanziato da / CAVIT, ITALIA
1 PROGETTO finanziato da / INNOVITIS






1 PROGETTO finanziato da / TUTZER VIVAI, ITALIA
1 PROGETTO finanziato da / RAGAZZINI SRL, ITALIA
1 PROGETTO finanziato da / ZENATO SRL, ITALIA
1 PROGETTO finanziato da / VITIS RAUSCEDO SCA
1 PROGETTO finanziato da / CENTRO RICERCHE PRODUZIONE ANIMALI C.R.P. A. S.P.A, ITALIA
1 PROGETTO finanziato da / FONDAZIONI AGER
5 PROGETTI finanziati da / FONDAZIONE CARITRO, ITALIA
2 PROGETTI finanziati da / BELCHIM CROP PROTECTION S.A


2 PROGETTI finanziati da / CONSORZIO DEL VINO BRUNELLO DI MOLTALCINO, ITALIA

1 PROGETTO finanziato da / CRODA / BIOPHIL
1 PROGETTO finanziato da / CBC EUROPE


1 PROGETTO finanziato da / CONSORZIO TUTELA GRANA PADANO
1 PROGETTO finanziato da / UNIONE ITALIANA VINI, ITALIA
1 PROGETTO finanziato da / SOCIETÀ PER LA GESTIONE DELLE ACQUE NELLA PROVINCIA OVEST DI BRESCIA E DEL GARDA.
1 PROGETTO finanziato da / NATIONAL SCIENCE FOUNDATION, USA








3 PROGETTI finanziati da / UNIONE EUROPEA
23 PROGETTI finanziati da / COMMISSIONE EUROPEA
1 PROGETTO finanziato da / BACINO IMBRIFERO MONTANO DEL CHIESE
1 PROGETTO finanziato da / COMUNE DI TRENTO

1 PROGETTO finanziato da / REGIONE PIEMONTE
1 PROGETTO finanziato da / REGIONE LAZIO
2 PROGETTI finanziati da / BACINO IMBRIFERO MONTANO DELLʼ ADIGE
1 PROGETTO finanziato da / MINISTERO PER LO SVILUPPO ECONOMICO CONSORZIO TOSCANO
1 PROGETTO finanziato da / MINISTERO DELLA SALUTE
44 PROGETTI finanziati da / PROVINCIA AUTONOMA DI TRENTO
2 PROGETTI finanziati da / REGIONE SICILIA
3 PROGETTI finanziati da / MINISTERO DELLʼISTRUZIONE, DELLʼUNIVERSITÀ E DELLA RICERCA
7 PROGETTI finanziati da / MINISTERO DELLE POLITICHE AGRICOLE, ALIMENTARI E FORESTALI
WORKSHOP / Applicazioni della genomica

08/05/09
MEETING / “Population Genetics for Animal Conservation”. Incontro presentazione del libro edito da Cambridge University Press.
25-26/05/09
WORKSHOP / Ecofisiologia vegetale: “La fluorescenza della clorofilla: dalla teoria alla (buona) pratica”.

MAGGIO
27-29/05/09
WORKSHOP / Techniques and Methods in Eco-physiological Studies in Alpine Ecosystems.
29/05/09

WORKSHOP / Workshop for the promotion of a trans-alpine alliance on environment and forests research and innovation.






LUGLIO 10/07/09
WORKSHOP / Studies of Alpine communities in a time of change - Methods to identify resilient outcomes of high social, economic and ecological value.
MEETING / Terzo workshop annuale del progetto GrapeGen06.
09/10/09




HAPPENING / Tavola Rotonda BIOWEEK “La nuova biologia per la salute della persona e per la salute del pianeta”.

27/11/09
WORKSHOP / Insect communication: from brain mechanisms to field application.

MARZO 18/03/10


GMPF / Presentato il Programma Internazionale di Dottorato GMPF.
APRILE 21-25/04/10
ATTIVITÀ / Cominciano le attività della azione COST ES0903 EUROSPEC.

GIUGNO 07-11/06/10
WORKSHOP / Corso internazionale sui licheni.
LUGLIO 05-09/07/10
MEETING / III°convegno nazionale di viticoltura.
29/08/10
CONFERENZA STAMPA/ Presentazione del sequenziamento del Genoma della Mela.
01/10/10
ATTIVITÀ / Approvazione del CdA sulla riorganizzazione CRI.

18/10/10
ATTIVITÀ / Si chiude il primo bando per le borse del IPP FEM.
23/11/10
WORKSHOP / Biologica Molecolare e chimica ecologica: Comprendere i meccanismi dellʼolfatto degli insetti.


20/12/10
PRESENTAZIONE / Lo studio sullʼampelometria del Trentino.
26/12/10
CONFERENZA STAMPA / Presentazione del sequenziamento del Genoma della Fragola.


Battilana Juri
COORDINATORE FEM / Maria Stella Grando
Carpi Giovanna
COORDINATORE FEM / Annapaola Rizzoli
Dalponte Michele
COORDINATORE FEM / Damiano Gianelle
Emanuelli Francesco
COORDINATORE FEM / Maria Stella Grando
Ferreira Eduardo Antonio
COORDINATORE FEM / Fulvio Mattivi
Fortes Gris Eliana
COORDINATORE FEM / Fulvio Mattivi
Franciosi Elena
COORDINATORE FEM / Agostino Cavazza
Guzzon Raffaele
COORDINATORE FEM / Agostino Cavazza
DIPARTIMENTO

Università degli Studi di Padova, Italia Agro-biotecnologie
Università degli Studi di Torino, Italia Produzione Animale, Epidemiologia ed Ecologia
Università degli Studi di Trento, Italia Ingegneria dellʼInformazione
Università degli Studi di Milano, Italia Produzione Vegetale

Università di Santa Caterina, Brasile Nutrizione
Università di Santa Caterina, Brasile Nutrizione
Università degli Studi di Bologna, Italia Scienze limentari
Università degli Studi di Trento, Italia Ingegneria dei Materiali e delle Tecnologie Induztriali
Neteler Markus Leibniz University of Hannover, Germania Istituto di Fisica Geografica e Ecologia del Territorio
Paternoster Thomas
COORDINATORE FEM / Ilaria Pertot
Pedron Luca
COORDINATORE FEM / Nicola La Porta
Silveri Luana
COORDINATORE FEM / Bruno Maiolini
Zignin Andrea
COORDINATORE FEM / Bruno Maiolini
Swiss Federal Institute of Technology (ETH), Svizzera Istituto di Biologia Integratica


Università degli Studi di Firenze, Italia Biotecnologie Agrarie e Forestali
Università degli Studi di Parma, Italia Scienze Ambientali e Biologia Evoluzionistica
Università degli Studi di Parma, Italia Scienze Ambientali e Biologia Evoluzionistica
STUDENTE / COORDINATORE FEM UNIVERSIT
o Biasioli Univers U
COORDINATORE FEM / Ilaria Pertot, Michele Perazzolli
Mraihi Mohamed
COORDINATORE FEM / Ilaria Pertot, Marco Tasin
Padova, Italia
Università degli Studi di Bari, Italia
Università di Bari, Italia
Brazzale Daniele
COORDINATORE FEM / Claudio Moser, Stefania Pilati
Lazzeri Elisa


COORDINATORE FEM / Cristiano Vernesi
Leonardelli Loredana
COORDINATORE FEM / Claudio Moser, Silvia Vezzulli
Scuola Galileiana di Studi Superiori
Centre International de Hautes Etudes Agronomiques Méditerranéennes
Centre International de Hautes Etudes Agronomiques Méditerranéennes









Università degli Studi di Padova, Italia Studi Agrari
Università degli Studi di Ferrara, Italia Fisica Evoluzionistica
Università degli Studi di Bologna, Italia Medicina e Chirurgia

Anesin Giulia
COORDINATORE FEM / Federica Camin
Bozza Elisa
COORDINATORE FEM / Luigi Palmieri
Broseghini Alessandro
COORDINATORE FEM / Marco Stefanini
Cestari Giacomo
COORDINATORE FEM / Ilaria Pertot
Michele Perazzolli
Collini Margherita
COORDINATORE FEM / Cristiano Vernesi
Cont Massimiliano
COORDINATORE FEM / Riccardo Velasco, Elena Zini
Corazzola Alessandro
COORDINATORE FEM / Ilaria Pertot
Silvia Dagostin
Filosi Roberto
COORDINATORE FEM / Ilaria Pertot
Alberto Pellegrini
Fortarel Alberto
COORDINATORE FEM / Ilaria Pertot, Dario Angeli
Giovannini Oscar
COORDINATORE FEM / Ilaria Pertot, Silvia Dagostin
Kusstatscher Natashia
COORDINATORE FEM / Riccardo Velasco, Diego Micheletti
Maccari Jenny
COORDINATORE FEM / Ilaria Pertot, Alberto Pellegrini
Molteni Davide
COORDINATORE FEM / Francesca Cagnacci
Pardatscher Franz
COORDINATORE FEM / Ilaria Pertot
Peripoli Giorgio
COORDINATORE FEM / Nico Salmaso
Semenzato Paola
COORDINATORE FEM / Francesca Cagnacci
Università degli Studi di Modena, Italia Farmacia
Università degli Studi di Padova, Italia Agraria
Università degli Studi di Udine-Trento, Italia Agraria / Ingegneria
Università degli Studi di Udine, Italy Biologia e Protezione delle Piante
Università degli Studi di Padova, Italia Agraria / Scienze MM. FF. NN.
Università degli Studi di Verona, Italia Medicina e Chirurgia
Università degli Studi di Udine, Italia Biologia e Protezione delle Piante
Università degli Studi di Udine, Italia Biologia e Protezione delle Piante
Università degli Studi di Udine, Italia Biologia e Protezione delle Piante
Università degli Studi di Udine, Italia Biologia e Protezione delle Piante
Università degli Studi di Verona, Italia Medicina e Chirurgia
Università degli Studi di Udine, Italia Biologia e Protezione delle Piante
Università degli Studi di Trento, Italia Ingegneria delle Telecomunicazioni
Università degli Studi di Udine, Italia Biologia e Protezione delle Piante
Università degli Studi di Padova, Italia Biologia
Università degli Studi di Roma La Sapienza, Italia Scienze MM. FF. e NN.
Berteotti Silvia
COORDINATORE FEM / Cristiano Vernesi
Broseghini Alessandro
COORDINATORE FEM / Marco Stefanini
Dal Lago Chiara
COORDINATORE FEM / Maria Stella Grando
Graiff Matteo
COORDINATORE FEM / Gianfranco Anfora
Hofer Gregor
COORDINATORE FEM / Marco Stefanini, Duilio Porro
Höyng Fabian
COORDINATORE FEM / Marco Stefanini
Larger Simone
COORDINATORE FEM / Massimo Pindo
Locci Stefano
COORDINATORE FEM / Flavia Gasperi
Maistri Simone
COORDINATORE FEM / Juri Battilana
Melchiorri Matteo
COORDINATORE FEM / Marco Stefanini
Michelini Samanta
COORDINATORE FEM / Nicola La Porta
Nicolini Daniela
COORDINATORE FEM / Riccardo Velasco
Pacher Andrea
COORDINATORE FEM / Juri Battilana, Maria Stella Grando
Pojer Nicola
COORDINATORE FEM / Flavia Gasperi
Poli Michele
COORDINATORE FEM / Bruno Maiolini
Recchia Domenico
COORDINATORE FEM / Flavia Gasperi
Roccaforte Vincenzo
COORDINATORE FEM / Silvia Vezzulli, Riccardo Velasco
Rossi Stefano
COORDINATORE FEM / Ilaria Pertot, Dario Angeli
Simeoni Federico
COORDINATORE FEM / Fulvio Mattivi
Tovazzi Marco
COORDINATORE FEM / Ilaria Pertot, Alberto Pellegrini
Wolf Joachim
COORDINATORE FEM / Fulvio Mattivi
Zanotti Tania
COORDINATORE FEM / Ilaria Pertot, Dario Angeli
Zublasing Georg
COORDINATORE FEM / Ilaria Pertot
Zublasing Philipp
COORDINATORE FEM / Flavia Gasperi
Università degli Studi di Verona, Italia Scienze MM. FF. NN.
Università degli Studi di Udine-Trento, Italia Agraria / Ingegneria
Università degli Studi di Padova, Italia Agraria
Università degli Studi di Padova, Italia Agronomia ambientale e Produzioni vegetali
Università degli Studi di Udine-Trento, Italy Agraria / Ingegneria
University of Geisenheim, Germania Agraria / Ingegneria
Università degli Studi di Verona, Italia Medicina e Chirurgia
Università degli Studi di Trento, Italia Scienze Cognitive
Università degli Studi di Udine Trento, Italia Agraria / Ingegneria
Università degli Studi di Udine Trento, Italia Agraria / Ingegneria
Università degli Studi di Bologna, Italia Colture Arboree
Università degli Studi di Verona, Italia Medicina e Chirurgia
Università degli Studi di Ferrara, Italia Scienze MM. FF. e NN.
Università degli Studi di Trento, Italia Scienze Cognitive
Università degli Studi di Padova, Italia Agraria / Scienze MM. FF. NN.
Università degli Studi di Trento, Italia Scienze Cognitive
Università degli Studi di Verona, Italia Medicina e Chirurgia
Università degli Studi di Udine, Italia Biologia e Protezione delle Piante
Università degli Studi diUdine-Trento, Italia Agraria
Università degli Studi di Udine, Italia Biologia e Protezione delle Piante
University of Geisenheim, , Germania
Università degli Studi di Udine-Trento, Italia Agraria / Ingegneria
Università degli Studi di Udine, Italia Biologia e Protezione delle Piante
Università degli Studi di Udine, Italia Biologia e Protezione delle Piante
Università degli Studi di Udine-Trento, Italia Agraria / Ingegneria






Premio SOIO 2010 Migliore pubblicazione scientifica nel settore Società Ortoflorofrutticola Italiana Juri Battilana
Migliore presentazione orale per il 2009 Associazione Italiana di Oceanologia e Limnologia Barbara Centis
Miglior poster di ricerca Società italiana di scienze sensoriali


Premio “Marchetti” 2009 Migliore presentazione orale Società Italiana di Ecologia
Premio per lʼoriginalità e la validità scientifica della ricerca Associazione Italiana Tecnici del Latte (AITeL)
Premio SIVE “Ricerca Italiana per lo Sviluppo” Società Italiana Viticoltura ed Enologia

Karl Bayer 2010 Migliore tesi in viticoltura ed enologia
Karl Bayer Consortium
Maria Laura Corollaro
Domenico DʼAlelio
Alessandra Fabris
Raffaele Guzzon, Agostino Cavazza, Giovanni Carturan
Simone Maistri
“Mars ‒ Glaxo” Miglior poster 2009 Sezione Euroberry Conferenza Internazionale sui Polifenoli e sulla Salute Urska Vrhovsek
PUBBLICAZIONESITO WEB
American Journal of Enology and Viticulture
ISHS Acta Horticulturae
Journal of Food, Agriculture & Environment
IOBC-WPRS Bulletin
Journal of Limnology
Advances in Oceanography and Limnology
Mycology
Mitteilungen Klosterneuburg
Molecular Breeding
Plant Molecular Biology Reporter
Recent Patents on Food, Nutrition & Agriculture
South African Journal of Oenology and Viticulture
Tree Genetics and Genomes
VITIS ‒ Journal of Grapevine research
VQ - In vite qualitas, in vino excellentia
http://www. ajevonline.org
http://www.actahort.org
http://www.isfae.org/scientific journal.php
http://www.iobc-wprs.org/pub/index.html
http://www.iii.to.cnr.it
http://www.tandf.co.uk
http://www.tandf.co.uk/journals
http://bundesamt.weinobstklosterneu burg.at
http://www.springer.org
http://www.springer.org
:http://www.bentham.org/pfna/EBM.htm
http://www.sasev.org/journal
http://www.springer.org
http://www.bafz.de
http://www.tecnichenuove.com
MEMBRI
Riccardo Velasco
Lara Giongo
Lucia Martinelli
Ilaria Pertot
Nico Salmaso
Nico Salmaso
Nicola La Porta
Fulvio Mattivi, Urska Vrhovsek
Silvio Salvi
Riccardo Velasco
Fulvio Mattivi, Eugenio Aprea
Lucia Martinelli, Fulvio Mattivi
Riccardo Velasco
Fulvio Mattivi, Lucia Martinelli
Maria Stella Grando, Fulvio Mattivi, Marco Stefanini, Riccardo Velasco



AAmici V., Geri F., Csontos P., Neteler M., Rocchini D. (2010). Fuzzy and boolean forest membership: on the actual separability of land cover classes.
Applied Ecology and Environmental Research, 8, (1): 39-50. http://www.ecology.kee.hu/indvol08_1.htm
Anfora G., Tasin M., De Cristofaro A., Ioriatti C., Lucchi A. (2009).
Synthetic grape volatiles attract mated Lobesia botrana females in laboratory and field bioassays.
Journal of Chemical Ecology, 35, (9): 1054-1062.
DOI: 10.1007/s10886-009-9686-5
Anfora G., Frasnelli E., Maccagnani B., Rogers L.J., Vallortigara G. (2010). Behavioural and electrophysiological lateralization in a social (Apis mellifera) but not in a non-social (Osmia cornuta) species of bee.
Behavioural Brain Research, 206, (2): 236-239.
DOI: 10.1016/j.bbr.2009.09.023
Angeli D., Pellegrini E., Pertot I. (2009).
Occurrence of Erysiphe necator Chasmothecia and their natural parasitism by Ampelomyces quisqualis.
Phytopathology, 99, (6): 704-710.
DOI: 10.1094/PHYTO-99-6-0704
Aprea E., Biasioli F., Carlin S., Endrizzi I., Gasperi F. (2009).
Investigation of volatile compounds in two raspberry cultivars by two headspace techniques: solid phase microextraction/gas chromatography-mass spectrometry (SPME/GC-MS) and proton-transfer reaction-mass spectrometry (PTR-MS).
Journal of Agricultural and Food Chemistry, 57, (10): 4011-4018.
DOI: 10.1021/jf803998c
Aprea E., Carlin S., Giongo L., Grisenti M., Gasperi F. (2010).
Characterization of 14 raspberry cultivars by solid-phase microextraction and relationship with gray mold susceptibility.
Journal of Agricultural and Food Chemistry, 58, (2): 1100-1105.

DOI: 10.1021/jf902603f
BBagnoli F., Vendramin G.G., Buonamici A., Doulis A.G., Gonzalez-Martinez S.C., La Porta N., Magri D., Raddi P., Sebastiani F., Fineschi S. (2009). Is Cupressus sempervirens native in Italy? An answer from genetic and palaeobotanical data. Molecular Ecology, 18, (10): 2276-2286.
DOI: 10.1111/j.1365-294X.2009.04182.x
Baldo A., Norelli J.L., Farrell R.E., Bassett C.L., Aldwinckle H.S., Malnoy M. (2010). Identification of genes differentially expressed during interaction of resistant and susceptible apple cultivars (Malus X domestica) with Erwinia amylovora
BMC Plant Biology, 10, (1).
DOI: 10.1186/1471-2229-10-1
Balestrazzi A., Bonadei M., Calvio C., Mattivi F., Carbonera D. (2009).
Leaf-associated bacteria from transgenic white poplar producing resveratrol-like compounds: isolation, molecular characterization and evaluation of oxidative stress tolerance.
Canadian Journal of Microbiology, 55, (7): 829-840.
DOI: 10.1139/W09-038
Balestrazzi A., Bonadei M., Zelasco S., Giorcelli A., Gennaro M., Calligari P., Mattivi F., Quattrini E., Carbonera D. (2010).
Seasonal and tissue-specific transgene expression and resveratrol-3-glucoside (piceid) accumulation in genetically modified white poplars carrying the grapevine StSy gene.
Plant Cell, Tissue and Organ Culture
DOI: 10.1007/s11240-010-9830-5
Battilana J., Costantini L., Emanuelli F., Sevini F., Segala C., Moser S., Velasco R., Versini G., Grando M.S. (2009). The 1-deoxy-d -xylulose 5-phosphate synthase gene co-localizes with a major QTL affecting monoterpene content in grapevine.
Theoretical and Applied Genetics, 118, (4): 653-669.
DOI: 10.1007/s00122-008-0927-8

Beer C., Ciais P., Reichstein M., Baldocchi D., Law B.E. , Papale D., Soussana J.F., Ammann C., Buchmann N., Frank D., Gianelle D., Janssens I.A., Knohl A., Kostner B., Moors E., Roupsard O., Verbeeck H., Vesala T., Williams C.A., Wohlfahrt G. (2009).
Temporal and among-site variability of inherent water use efficiency at the ecosystem level.
Global Biogeochemical Cycles, 23: GB2018.
DOI: 10.1029/2008GB003233
Bennion H., Simpson G.L., Anderson N.J., Clarke G., Dong X., Hobaek A., Guilizzoni P., Marchetto A., Sayer C.D., Thies H., Tolotti M. (2010).
Defining ecological and chemical reference conditions and restoration targets for nine European lakes.
Journal of Paleolimnology
DOI: 10.1007/s10933-010-9418-4
Bertoldi D., Bontempo L., Larcher R., Nicolini G., Voerkelius S., Lorenz G.D., Ueckermann H., Froeschl H., Baxter M.J., Hoogewerff J., Brereton P. (2010).
Survey of the chemical composition of 571 European bottled mineral waters.
Journal of Food Composition and Analysis

DOI: 10.1016/j.jfca.2010.07.005
Biasioli F., Aprea E., Gasperi F., Märk T.D. (2009).
Measuring odour emission and biofilter efficiency in composting plants by Proton Transfer
Reaction-Mass Spectrometry.
Water Science & Technology, 59, (7): 1263-1269.
DOI: 10.2166/wst.2009.107
Bisognin C., Seemüller E., Citterio S., Velasco R., Grando M.S., Jarausch W. (2009). Use of SSR markers to assess sexual vs. apomictic origin and ploidy level of breeding progeny derived from crosses of apple proliferation-resistant Malus sieboldii and its hybrids with Malus x domestica cultivars.
Plant Breeding, 128, (5): 507-513.


DOI: 10.1111/j.1439-0523.2008.01614.x
Boido E., Medina F., Medina K., Farina L., Carrau F., Versini G., Dellacassa E. (2009). The effect of bacterial strain and aging on the secondary volatile metabolites produced during malolactic fermentation of Tannat red wine.
Journal of Agricultural and Food Chemistry, 57, (14): 6271-6278.

DOI: 10.1021/jf900941y
Bontempo L., Camin F., Larcher R., Nicolini G., Perini M., Rossmann A. (2009). Coast and year effect on H, O and C stable isotope ratios of Tyrrhenian and Adriatic Italian olive oils. Rapid Communications in Mass Spectrometry, 23, (7): 1043-1048.
DOI: 10.1002/rcm.3968
Bovolenta S., Corazzin M., Sacca E., Gasperi F., Biasioli F., Ventura W. (2009).
Performance and cheese quality of Brown cows grazing on mountain pasture fed two different levels of supplementation.
Livestock Science, 124, (1/3): 58-65.
DOI: 10.1016/j.livsci.2008.12.009
Bruno M.C., Maiolini B., Carolli M., Silveri L. (2009).
Impact of hydropeaking on hyporheic invertebrates in an Alpine stream (Trentino, Italy).
Annales de Limnologie - International Journal of Limnology, 45, (3): 157-170.
DOI: 10.1051/limn/2009018
Bruno M.C., Maiolini B., Carolli M., Silveri L. (2010).
Short time-scale impacts of hydropeaking on benthic invertebrates in an Alpine stream (Trentino, Italy). Limnologica, 40, (4): 281-290.
DOI: 10.1016/j.limno.2009.11.012
Budic-Leto I., Vrhovsek U., Gajdoš Kljusuric J., Lovric T. (2009). Anthocyanin pattern of skin extracts from the Babic and Plavac mali grapes and anthocyanin pattern of the produced wine.
Acta Alimentaria, 38, (1): 67-75.
DOI: 10.1556/AAlim.2008.0029
Burt G., Hauffe H.C., Searle J.B. (2009).
New metacentric population of the house mouse (Mus musculus domesticus) found in Valchiavenna, northern Italy.
Cytogenetic and Genome Research, 125, (4): 260-265.
DOI: 10.1159/000235931
Bussotti F., Pollastrini M., Cascio C., Desotgiu R., Gerosa G. , Marzuoli R., Nali C., Lorenzini G., Pellegrini
E., Carucci M.G., Salvatori E., Fusaro L., Piccotto M., Malaspina P., Manfredi A., Roccotello E., Toscano S., Gottardini E., Cristofori A., Fini A., Weber D., Baldassarre V., Barbanti L., Monti A., Strasser R.J. (2010). Conclusive remarks. Reliability and comparability of chlorophyll fluorescence data from several field teams.
Environmental and Experimental Botany
DOI: 10.1016/j.envexpbot.2010.10.023
Cagnacci F., Boitani L., Powell R.A., Boyce M.S. (2010).
CAnimal ecology meets GPS-based radiotelemetry: a perfect storm of opportunities and challenges.
Philosophical Transactions of the Royal Society B-Biological Sciences, 365, (1550): 2157-2162.
DOI: 10.1098/rstb.2010.0107
Camin F., Bontempo L., Ziller L., Piangiolino C., Morchio G. ( 2010).
Stable isotope ratios of carbon and hydrogen to distinguish olive oil from shark squalene-squalane.
Rapid Communications in Mass Spectrometry, 24, (12): 1810-1816.
DOI: 10.1002/rcm.4581
Camin F., Larcher R., Nicolini G., Bontempo L., Bertoldi D., Perini M., Schlicht C., Schellenberg A., Thomas F., Heinrich K., Voerkelius S., Horacek M., Ueckermann H., Froeschl H., Wimmer B., Heiss G., Baxter M., Rossmann A., Hoogewerff J. (2010).
Isotopic and elemental data for tracing the origin of European olive oils.
Journal of Agricultural and Food Chemistry, 58, (1): 570‒577.

DOI: 10.1021/jf902814s
Camin F., Larcher R., Perini M., Bontempo L., Bertoldi D., Gagliano G., Nicolini G., Versini G. (2010). Characterisation of authentic Italian extra-virgin olive oils by stable isotope ratios of C, O and H and mineral composition.
Food Chemistry, 118, (4): 901-909.


DOI: 10.1016/j.foodchem.2008.04.059
Cappellin L., Biasioli F., Fabris A., Schuhfried E., Soukoulis C., Märk T.D., Gasperi F. (2010). Improved mass accuracy in PTR-TOF-MS: another step towards better compound identification in PTR-MS.
International Journal of Mass Spectrometry, 290, (1): 60-63.
DOI: 10.1016/j.ijms.2009.11.007
Cappellin L., Probst M., Limtrakul J., Biasioli F., Schuhfried E., Soukoulis C., Mark T.D., Gasperi F. (2010). Proton transfer reaction rate coefficients between H3O+ and some sulphur compounds.
International Journal of Mass Spectrometry, 295, (1-2): 43-48.
DOI: 10.1016/j.ijms.2010.06.023
Carletti P., Vendramin E., Pizzeghello D., Concheri G., Zanella A., Nardi S., Squartini A. (2009). Soil humic compounds and microbial communities in six spruce forests as function of parent material, slope aspect and stand age.
Plant and Soil, 315, (1-2): 47-65.
DOI: 10.1007/s11104-008-9732-z
Carpi G., Bertolotti L., Pecchioli E., Cagnacci F., Rizzoli A. (2009). Anaplasmaphagocytophilum groEL gene heterogeneity in Ixodes ricinus larvae feeding on roe deer in Northeastern Italy.
Vector-Borne and Zoonotic Diseases, 9, (2): 179-184.
DOI: 10.1089/vbz.2008.0068
Carpi G., Bertolotti L., Rosati S., Rizzoli A. (2009).
Prevalence and genetic variability of tick-borne Encephalitis virus in host-seeking Ixodes ricinus in Northern Italy.
Journal of General Virology, 90, (12): 2877-2883.

DOI: 10.1099/vir.0.013367-0
Carpi G., Holmes E.C., Kitchen A. (2010). The evolutionary dynamics of bluetongue virus.
Journal of Molecular Evolution, 70, (6): 583-592.
DOI: 10.1007/s00239-010-9354-y
Carra A., Mica E., Gambino G., Pindo M., Moser C., Pè M.E., Schubert A. (2009). Cloning and characterization of small non-coding RNAs from grape.
The Plant Journal, 59, (5): 750-763.
DOI: 10.1111/j.1365-313X.2009.03906.x
Cavazza A., Poznanski E., Guzzon R. (2010). Must treatments and wild yeast growth before and during alcoholic fermentation.
Annals of Microbiology
DOI: 10.1007/s13213-010-0132-2
Centis B., Tolotti M., Salmaso N. (2010).


Structure of the diatom community of the river Adige (North-eastern Italy) along a hydrological gradient.
Hydrobiologia, 639, (1): 37-42.
DOI: 10.1007/s10750-009-0019-z
Chiarucci A., Bacaro G., Rocchini D., Ricotta C., Palmer M.W., Scheiner S.M. (2009). Spatially constrained rarefaction: incorporating the autocorrelated structure of biological communities into sample-based rarefaction.
Community Ecology, 10, (2): 209-214.
DOI: 10.1556/ComEc.10.2009.2.11
Chiti T., Papale D., Smith P., Dalmonech D., Matteucci G., Yeluripati J., Rodeghiero M., Valentini R. (2010). Predicting changes in soil organic carbon in mediterranean and alpine forests during the Kyoto Protocol committment periods using the CENTURY model.
Soil Use and Management, 26, (4): 475-484.
DOI: 10.1111/j.1475-2743.2010.00300.x
Costa F., Alba R., Schouten H., Soglio V., Gianfranceschi L., Serra S., Musacchi S., Sansavini S., Costa G., Fei Z.J., Giovannoni J. (2010). Use of homologous and heterologous gene expression profiling tools to characterize transcription dynamics during apple fruit maturation and ripening.
BMC Plant Biology, 10, (229).
DOI: 10.1186/1471-2229-10-229
Costa F., Peace C.P., Stella S., Serra S., Musacchi S., Bazzani M., Sansavini S., Van De Weg W.E. (2010). QTL dynamics for fruit firmness and softening around an ethylene-dependent polygalacturonase gene in apple (Malus x domestica Borkh.).
Journal of Experimental Botany, 61, (11): 3029-3039.
DOI: 10.1093/jxb/erq130
Cottarelli V., Bruno M.C., Berera R. (2010).
First record of Parastenocarididae from Thailand and description of a new genus (Copepoda: Harpacticoida).
Journal of Crustacean Biology, 30, (3): 478-494.
DOI: 10.1651/09-3201.1
Cova V., Paris R., Passerotti S., Zini E., Gessler C., Pertot I., Loi N., Musetti R., Komjanc M. (2010). Mapping and functional analysis of four apple receptor-like protein kinases related to LRPKm1 in HcrVf2-transgenic and wild-type apple plants.
Tree Genetics & Genomes, 6, (3): 389-403.
DOI: 10.1007/s11295-009-0257-2

Crestanello B., Pecchioli E., Vernesi C., Mona S., Martinkova N., Janiga M., Hauffe H.C., Bertorelle G. ( 2009).
The genetic impact of translocations and habitat fragmentation in chamois (Rupicapra) spp. Journal of Heredity, 100, (6): 691-708.
DOI: 10.1093/jhered/esp053
Cristofori A., Cristofolini F., Gottardini E. (2010).
Twenty years of aerobiological monitoring in Trentino (Italy): assessment and evaluation of airborne pollen variability.
Aerobiologia, 26, (3): 253-261.
DOI: 10.1007/s10453-010-9161-3
Cross J., Hall D.R., Shaw P., Anfora G. (2009). Exploitation of sex pheromone of apple leaf midge Dasineura mali Kieffer (Diptera: cecidomyiidae): part 2. Use of sex pheromone traps for pest monitoring. Crop Protection, 28, (2): 128-133.
DOI: 10.1016/j.cropro.2008.09.004
Dagostin S., Formolo T., Giovannini O., Pertot I., Schmitt A. (2010). Salvia officinalis extract can protect grapevine against Plasmopara viticola. Plant Disease, 94, (5): 575-580.
DDOI: 10.1094/PDIS-94-5-0575

Dal Cin V., Barbaro E., Danesin M., Murayama H., Velasco R., Ramina A. (2009). Fruitlet abscission: a cDNA-AFLP approach to study genes differentially expressed during shedding of immature fruits reveals the involvement of a putative auxin hydrogen symporter in apple (Malus domestica L. Borkh).
Gene, 442, (1/2): 26-36.
DOI: 10.1016/j.gene.2009.04.009
Dal Cin V., Velasco R., Ramina A. (2009).
Dominance induction of fruitlet shedding in Malus x domestica (L. Borkh): molecular changes associated with polar auxin transport.
BMC Plant Biology, 9, (139)
DOI: 10.1186/1471-2229-9-139
Dalla Costa L., Vaccari I., Mandolini M., Martinelli L. (2009). Elaboration of a reliable strategy based on real-time PCR to characterize genetically modified plantlets and to evaluate the efficiency of a marker gene removal in grape (Vitis spp.).
Journal of Agricultural and Food Chemistry, 57, (7): 2668‒2677.

DOI: 10.1021/jf802740m
Dalla Costa L., Mandolini M., Poletti V., Martinelli L. (2010). Comparing 17-B-estradiol supply strategies for applying the XVE-Cre/loxP ssystem in grape gene transfer (Vitis vinifera L.).
Vitis, 49, (4): 201-208.
http://www.jki.bund.de/de/startseite/veroeffentlichungen/vitis.html


Dalponte M., Bruzzone L., Vescovo L., Gianelle D. (2009). The role of spectral resolution and classifier complexity in the analysis of hyperspectral images of forest areas.
Remote Sensing of Environment, 113, (11): 2345-2355.
DOI: 10.1016/j.rse.2009.06.013
Degirmenci D., Kunter B., Coppola G., Velasco R. (2010). Analysis of polymorphism based on SSCP markers in gamma-irradiated (Co60) grape (Vitis vinifera ) varieties.
GMR Genetics and Molecular Research, 9, (4): 2357-2363.
DOI: 10.4238/vol9-4gmr864
De Michele R., Formentin E., Todesco M., Toppo S., Carimi F., Zottini M., Barizza E., Ferrarini A., Delledonne M., Fontana P., Lo Schiavo F. (2009).
Transcriptome analysis of Medicago truncatula leaf senescence: similarities and differences in metabolic and transcriptional regulations as compared with Arabidopsis, nodule senescence and nitric oxide signalling.
New Phytologist, 181, (3): 563-575.


DOI: 10.1111/j.1469-8137.2008.02684.x
DellʼAnna R., Lazzeri P., Frisanco M., Monti F., Malvezzi Campeggi F., Gottardini E., Bersani M. (2009). Pollen discrimination and classification by Fourier transform infrared (FT-IR) microspectroscopy and machine learning.
Analytical & Bioanalytical Chemistry, 394, (5): 1443-1452.
DOI: 10.1007/s00216-009-2794-9
Di Marino E., Montecchio L., Scattolin L., Abs C., Agerer R. (2009).
The ectomycorrhizal community structure in European beech forests differing in coppice shoot age and stand features.
Journal of Forestry, 107, (5): 250-259.
Eccel E., Rea R., Caffarra A., Crisci A. (2009).
Risk of spring frost to apple production under future climate scenarios: the role of phenological acclimation.
International Journal of Biometeorology, 53, (3): 273-286.
DOI: 10.1007/s00484-009-0213-8
Emanuelli F., Battilana J., Costantini L., Le Cunff L., Boursiquot J.M., This P., Grando M.S. (2010). A candidate gene association study on muscat flavor in grapevine (Vitis vinifera L.).
BMC Plant Biology, 10, (241).

DOI: 10.1186/1471-2229-10-241
Endrizzi I., Pirretti G., Caló D.G., Gasperi F. (2009). A consumer study of fresh juices containing berry fruits.
Journal of the Science of Food and Agriculture, 89, (7): 1227-1235.
DOI: 10.1002/jsfa.3580
Endrizzi I., Gasperi F., Calo D.G., Vigneau E. (2010). Two-step procedure for classifying consumers in a L-structured data context. Food Quality and Preference, 21, (3): 270-277.
DOI: 10.1016/j.foodqual.2009.06.004
Fabris A., Biasioli F., Granitto P.M., Aprea E., Cappellin L., Schuhfried E., Soukoulis C., Märk T.D., Gasperi F., Endrizzi I. (2010).
PTR-TOF-MS and data-mining methods for rapid characterisation of agro-industrial samples: influence of milk storage conditions on the volatile compounds profile of Trentingrana cheese.
Journal of Mass Spectrometry, 45, (9): 1065-1074.
DOI: 10.1002/jms.1797
Fairchild I.J., Loader N.J., Wynn P.M., Frisia S., Thomas P.A. , Lageard J.G.A., De Momi A., Hartland A., Borsato A., La Porta N., Susini J. (2009).
Sulfur fixation in wood mapped by synchrotron X-ray studies: implications for environmental archives.
Environmental Science & Technology, 43, (5): 1310-1315.
DOI: 10.1021/es8029297
Fasolato L., Novelli E., Salmaso L., Corain L., Camin F., Perini M., Antonetti P., Balzan S. (2010). Application of nonparametric multivariate analyses to the authentication of wild and farmed European sea bass ( Dicentrarchus labrax). Results of a survey on fish sampled in the retail trade.
Journal of Agricultural and Food Chemistry, 58, (20): 10979-10988.
DOI: 10.1021/jf1015126
Fedrizzi B., Magno F., Finato F., Versini G. (2010). Variation of some fermentative sulfur compounds in Italian “Millesime” classic sparkling wines during aging and storage on lees.
Journal of Agricultural and Food Chemistry, 58, (17): 9716-9722.
DOI: 10.1021/jf101478w
Ferrari N., Cattadori I., Rizzoli A., Hudson P.J. (2009). Heligmosomoides polygyrus reduces infestation of Ixodes ricinus in free-living yellow-necked mice, Apodemus flavicollis
Parasitology, 136, (3): 305-316.
DOI: 10.1017/S0031182008005404
Ferrari N., Rosà R., Lanfranchi P., Ruckstuhl K.E. (2010). Effect of sexual segregation on host-parasite interaction: model simulation for abomasal parasite dynamics in alpine ibex (Capra ibex).
International Journal for Parasitology, 40, (11): 1285-1293.
DOI: 10.1016/j.ijpara.2010.03.015
Ferrarini R., Casarotti E.M., Zanella G., Mattivi F. (2009). White grape extended skin contact winemaking technique.
American Journal of Enology and Viticulture, 60, (3): 399A.
http://www.ajevonline.org/cgi/reprint/60/3/386A
Ferrarini R., Nicolis E., Furlan E., Zanella G., Mattivi F. (2009). First crushing experiences in an inert environment.
American Journal of Enology and Viticulture, 60, (3): 399A.
http://www.ajevonline.org/cgi/reprint/60/3/386A
Flaim G., Rott E., Frassanito R., Guella G., Obertegger U. (2010). Eco-fingerprinting of the dinoflagellate Borghiella dodgei: experimental evidence of a specific environmental niche.
Hydrobiologia, 639, (1): 85-98.
DOI: 10.1007/s10750-009-0013-5
Focardi S., Montanaro P., Pecchioli E. (2009). Adaptive levy walks in foraging fallow deer.
PLoS ONE, 4, (8)
DOI: 10.1371/journal.pone.0006587
Fontana P., Cestaro A., Velasco R., Formentin E., Toppo S. (2009). Rapid annotation of anonymous sequences from genome projects using semantic similarities and a weighting scheme in gene ontology.
PLoS ONE, 4, (2): e4619.

DOI: 10.1371/journal.pone.0004619
Fontanesi L., Forestier L., Allain D., Scotti E., Beretti F., Deretz-Picoulet S., Pecchioli E., Vernesi C., Robinson T.J., Malaney J.L., Russo V., Oulmouden A. (2010).
Characterization of the rabbit agouti signaling protein (ASIP) gene: transcripts and phylogenetic analyses and identification of the causative mutation of the nonagouti black coat colour.
Genomics, 95, (3): 166-175.
DOI: 10.1016/j.ygeno.2009.11.003
Frair J.L., Fieberg J., Hebblewhite M., Cagnacci F., Decesare N.J., Pedrotti L. (2010).
Resolving issues of imprecise and habitat-biased locations in ecological analyses using GPS telemetry data.
Philosophical Transactions of the Royal Society B-Biological Sciences, 365, (1550): 2187-2200.
DOI: 10.1098/rstb.2010.0084
Franciosi E., Pecile A., Cavazza A., Poznanski E. (2009).
Microbiological monitoring of raw milk from selected farm in the Trentingrana region.
Italian Journal of Animal Science, 8, (suppl. 2): 408-410.
http://ijas.pagepress.org/index.php/ijas/article/view/ijas.2009.s2.408/457

Franciosi E., Settanni L., Cavazza A., Poznanski E. (2009). Biodiversity and technological potential of wild lactic acid bacteria from raw cowsʼ milk.
International Dairy Journal, 19, (1): 3-11.

DOI: 10.1016/j.idairyj.2008.07.008
Franciosi E., Settanni L., Cavazza A., Poznanski E. (2009). Presence of enterococci in raw cowʼs milk and “Puzzone di Moena” cheese.
Journal of Food Processing and Preservation, 33, (2): 204-217.
DOI: 10.1111/j.1745-4549.2008.00262.x
Franciosi E., Settanni L., Cologna N., Cavazza A., Poznanski E. (2010). Microbial analysis of raw cowsʼ milk used for cheese-making: influence of storage treatments on microbial composition and other technological traits.
World Journal of Microbiology and Biotechnology
DOI: 10.1007/s11274-010-0443-2
Frasnelli E., Anfora G., Trona F., Tessarolo F., Antolini R., Vallortigara G. (2009). Morfo-functional asymmetry of the olfactory receptors of the honeybee Apis mellifera L. European Biophysics Journal, 38, (1 (suppl.)): P-155.
DOI: 10.1016/j.bbr.2010.01.046
Frasnelli E., Anfora G., Trona F., Tessarolo F., Vallortigara G. (2010). Morpho-functional asymmetry of the olfactory receptors of the honeybee (Apis mellifera).
Behavioural Brain Research, 209, (2): 221-225 .
DOI: 10.1016/j.bbr.2010.01.046
Fronzoni G., Stener M., Decleva P., De Simone M., Coreno M., Franceschi P., Furlani C., Prince K.C. (2009). X-ray absorption spectroscopy of VOCl3, CrO2Cl2, and MnO3Cl: an experimental and theoretical study.
Journal of Physical Chemistry A, 113, (12): 2914-2925.

DOI: 10.1021/jp808720z
Gago P., Santiago J.L., Boso S., Alonso-Villaverde V., Grando M.S., Martinez M.C. (2009). Biodiversity and characterization of twenty-two Vitis vinifera L. cultivars in the Northwestern Iberian peninsula.
American Journal of Enology and Viticulture, 60, (3): 293-301.
http://www.ajevonline.org/cgi/reprint/60/3/293
Gamon J.A., Coburn C., Flanagan L.B., Huemmrich K.F., Kiddle C., Sanchez-Azofeifa G.A., Thayer D.R., Vescovo L., Gianelle D., Sims D.A., Rahman A.F., Pastorello G.Z. (2010).
SpacNet revisited: bridging flux and remote sensing communities. Canadian Journal of Remote Sensing, 36, (S2): 376-390.
Gasperi F., Aprea E., Biasioli F., Carlin S., Endrizzi I. , Pirretti G., Spilimbergo S. (2009). Effects of supercritical CO2 and N2O pasteurisation on the quality of fresh apple juice. Food Chemistry, 115, (1): 129-136.
DOI: 10.1016/j.foodchem.2008.11.078
Gasperotti M., Masuero D., Vrhovsek U., Guella G., Mattivi F. (2010). Profiling and accurate quantification of Rubus ellagitannins and ellagic acid conjugates using direct UPLC-Q-TOF HDMS and HPLC-DAD analysis.
Journal of Agricultural and Food Chemistry, 58, (8): 4602-4616.
DOI: 10.1021/jf904543w
Gazzani S., Li M., Maistri S., Scarponi E., Graziola M., Barbaro E., Wunder J., Furini A., Saedler H., Varotto C. (2009).
Evolution of MIR168 paralogs in Brassicaceae.
BMC Evolutionary Biology, 9, (62)
DOI: 10.1186/1471-2148-9-62
Gentile G., Vernesi C., Vicario S., Pecchioli E., Caccone A., Bertorelle G., Sbordoni V. (2009). Mitochondrial DNA variation in roe deer (Capreoluscapreolus) from Italy: evidence of admixture in one of the last C. c. italicus pure populations from central-southern Italy.
Italian Journal of Zoology, 76, (1): 16-27.
DOI: 10.1080/11250000802018725
Gentili R., Abeli T., Rossi G., Li M., Varotto C., Sgorbati S. (2010). Population structure and genetic diversity of the threatened quillwort Isoëtes malinverniana and implication for conservation.
Aquatic Botany, 93, (3): 147-152.
DOI: 10.1016/j.aquabot.2010.05.003

Geri F., Amici V., Rocchini D. (2010).
Human activity impact on the heterogeneity of a Mediterranean landscape. Applied Geography, 30, (3): 370-379.
DOI: 10.1016/j.apgeog.2009.10.006
Geri F., Rocchini D., Chiarucci A. (2010).
Landscape metrics and topographical determinants of large-scale forest dynamics in a Mediterranean landscape.
Landscape and Urban Planning, 95, (1-2): 46-53.
DOI: 10.1016/j.landurbplan.2009.12.001
Gianelle D., Vescovo L., Marcolla B., Manca G., Cescatti A. (2009). Ecosystem carbon fluxes and canopy spectral reflectance of a mountain meadow.
International Journal of Remote Sensing, 30, (2): 435-449.
DOI: 10.1080/01431160802314855
Gianelle D., Vescovo L., Mason F. (2009). Estimation of grassland biophysical parameters using hyperspectral reflectance for fire risk map prediction.
International Journal of Wildland fire, 18, (7): 815-824.
DOI: 10.1071/WF08005
Gianelle D., Oechel W.C., Miglietta F., Rodeghiero M., Sottocornola M. (2010).
Cataloguing soil carbon stocks. Science, 330, (6010): 1476-1477.
DOI: 10.1126/science.330.6010.1476-c
Gill C.I.G., McDougall G., Glidewell S., Stewart D., Shen Q., Tuohy K., Dobbin A., Boyd A., Brown E., Haldar S., Rowland I.R. (2010).
Profiling of phenols in human fecal water after raspberry supplementation. Journal of Agricultural and Food Chemistry, 58, (19): 10389‒10395.
DOI: 10.1021/jf1017143
Gilmanov T.G., Aires L., Barcza Z., Baron V.S., Belelli L. , Beringer J., Billesbach D., Bonal D., Bradford J., Ceschia E., Cook D., Corradi C., Frank A., Gianelle D., Gimeno C., Gruenwald T., Guo H., Hanan N., Haszpra L., Heilman J., Jacobs A., Jones M.B., Johnson D.A., Kiely G., Li S., Magliulo V., Moors E., Nagy Z., Nasyrov M., Owensby C., Pinter K., Pio C., Reichstein M., Sanz M.J., Scott R., Soussana J.F., Stoy P.C., Svejcar T., Tuba Z., Zhou G. (2010). Productivity, respiration and light-response parameters of world grassland and agroecosystems derived from flux-tower measurements.
Rangeland Ecology & Management , 63, (1): 16-39.
DOI: 10.2111/REM-D-09-00072.1
Goremykin V., Moser C. (2009).
Classification of the Arabidopsis ERF gene family based on bayesian inference. Molecular Biology, 43, (5): 729-734.
DOI: 10.1134/S0026893309050045
Goremykin V., Salamini F., Velasco R., Viola R. (2009). Mitochondrial DNA of Vitis vinifera and the issue of rampant horizontal gene transfer.

Molecular Biology and Evolution, 26, (1): 99-110.

DOI: 10.1093/molbev/msn226
Goremykin V., Viola R., Hellwig F.H. (2009). Removal of noisy characters from chloroplast genome-scale data suggests revision of phylogenetic placements of Amborella and Ceratophyllum Journal of Molecular Evolution, 68, (3): 197-204.
DOI: 10.1007/s00239-009-9206-9
Goremykin V., Nikiforova S.V., Bininda-Emonds O.R.P. (2010). Automated removal of noisy data in phylogenomic analyses.
Journal of Molecular Evolution , 71, (5-6): 319-331.
DOI: 10.1007/s00239-010-9398-z
Gottardini E., Cristofolini F., Cristofori A., Vannini A., Ferretti M. (2009). Sampling bias and sampling errors in pollen counting in aerobiological monitoring in Italy.
Journal of Environmental Monitoring, 11, (4): 751-755.
DOI: 10.1039/b818162b
Gottardini E., Cristofori A., Cristofolini F., Bussotti F., Ferretti M. (2010). Responsiveness of ViburnumlantanaL.to tropospheric ozone: field evidence under contrasting site conditions in Trentino, northern Italy.
Journal of Environmental Monitoring, 12, (12): 2237-2243.
DOI: 10.1039/c0em00299b
Gottardini E., Cristofori A., Cristofolini F., Ferretti M. (2010). Variability of ozone concentration in a montane environment, northern Italy. Atmospheric Environment, 44, (2): 147-152.
DOI: 10.1016/j.atmosenv.2009.10.017
Guimaraes S., Ghirotto S., Benazzo A., Milani L., Lari M., Pilli E., Pecchioli E., Mallegni F., Lippi B., Bertoldi F., Gelichi S., Casoli A., Belle E.M.S., Caramelli D., Barbujani G. (2009). Genealogical discontinuities among Etruscan, Medieval, and contemporary Tuscans.
Molecular Biology and Evolution, 26, (9): 2157-2166.
DOI: 10.1093/molbev/msp126
Guzzon R., Poznanski E., Conterno L., Vagnoli P., Krieger-Weber S., Cavazza A. (2009). Selection of a new highly resistant strain for malolactic fermentation under difficult conditions.
South African Journal of Enology and Viticolture, 30, (2): 133-141.



Hauffe H.C., Gimenez M.D., Garagna S., Searle J.B. (2010).
First wild XXY house mice.
Chromosome Research, 18, (5): 599-604.

DOI: 10.1007/s10577-010-9135-x
HHauffe H.C., Niklasson B., Olsson T., Bianchi A.1., Rizzoli A., Klitz W. (2010). Ljungan virus detected in bank voles (Myodes glareolus) and yellow-necked mice (Apodemus flavicollis) from Northern Italy.
Journal of Wildlife Diseases, 46, (1): 262-266.
Ioriatti C., Anfora G., Angeli G., Mazzoni V., Trona F. ( 2009). Effects of chlorantraniliprole on eggs and larvae of Lobesia botrana (Denis & Schiffermüller) (Lepidoptera: Tortricidae).
Pest Management Science, 65, (6): 717-722.
DOI: 10.1002/ps.1744
Ioriatti C., Anfora G., Civolani S., Schmidt S., Pasqualini E. (2009). Toxicity of emamectin benzoate to Cydiapomonella(L.) and Cydiamolesta(Busck) (Lepidoptera: Tortricidae): laboratory and field tests.
Pest Management Science, 65, (3): 306-312.
DOI: 10.1002/ps.1689
Jung M., Reichstein M., Ciais P., Seneviratne S.I., Sheffield J., Goulden M.L., Bonan G., Cescatti A., Chen J., De Jeu R., Dolman A.J., Eugster W., Gerten D., Gianelle D., Gobron N., Heinke J., Kimball J., Law B.E., Montagnani L., Mu Q., Mueller B., Oleson K., Papale D., Richardson A.D., Roupsard O., Running S., Tomelleri E., Viovy N., Weber U., Williams C., Wood E., Zaehle S., Zhang K. (2010). Recent decline in the global land evapotranspiration trend due to limited moisture supply.
Nature, 467, (7319): 951-954.
DOI: 10.1038/nature09396
Koehler A.K., Murphy K., Kiely G., Sottocornola M. (2009).
KSeasonal variation of DOC concentration and annual loss of DOC from an Atlantic blanket bog in south western Ireland.
Biogeochemistry, 95, (1): 231-242.
DOI: 10.1007/s10533-009-9333-9
Kie J.G., Matthiopoulos J., Fieberg J., Powell R.A., Cagnacci F., Mitchell M.S., Gaillard J.M., Moorcroft P.R. (2010).
The home-range concept: are traditional estimators still relevant with modern telemetry technology?
Philosophical Transactions of the Royal Society B-Biological Sciences, 365, (1550): 2221-2231.

DOI: 10.1098/rstb.2010.0093
Kuflik T., Prodorutti D., Frizzi A., Gafni Y., Simon S., Pertot I. (2009). Optimization of copper treatments in organic viticulture by using a web-based decision support system.
Computers and Electronics in Agriculture, 68, (1): 36-43.
DOI: 10.1016/j.compag.2009.04.008
Lavagnini I., Fedrizzi B., Versini G., Magno F. (2009).
LEffectiveness of isotopically labelled and non-isotopically labelled internal standards in the gas chromatography/mass spectrometry analysis of sulfur compounds in wines: use of a statistically based matrix comprehensive approach.
Rapid Communications in Mass Spectrometry, 23, (8): 1167-1172.
DOI: 10.1002/rcm.3964
Lazzari B., Caprera A., Cestaro A., Merelli I., Del Corvo M., Fontana P., Milanesi L., Velasco R., Stella A. (2009).
Ontology-oriented retrieval of putative microRNAs in Vitis vinifera via GapeMiRNA: a web database of de novo predicted grape microRNAs.
BMC Plant Biology, 9, (82)
DOI: 10.1186/1471-2229-9-82
Longa Oliveira C.M., Pertot I. (2009).
An intact soil-core microcosm method to evaluate the survival and vertical dispersal of Trichoderma atroviride Sc1.
Letters in Applied Microbiology, 49, (5): 609-614.

DOI: 10.1111/j.1472-765X.2009.02715.x
Longa Oliveira C.M., Savazzini F., Tosi S., Elad Y., Pertot I. (2009). Evaluating the survival and environmental fate of the biocontrol agent Trichoderma atroviride SC1 in vineyards in Northern Italy.
Journal of Applied Microbiology, 106, (5): 1549-1557.
DOI: 10.1111/j.1365-2672.2008.04117.x
Longhi S., Cristofori A., Gatto P., Cristofolini F., Grando M.S., Gottardini E. (2009). Biomolecular identification of allergenic pollen: a new perspective for aerobiological monitoring?
Annals of Allergy, Asthma and Immunology, 103, (6): 508-514.
DOI: 10.1016/S1081-1206(10)60268-2
Luong L.T., Perkins S.E., Grear D.A., Rizzoli A., Hudson P.J. (2010). The relative importance of host characteristics and co-infection in generating variation in Heligmosomoides polygyrus fecundity.
Parasitology, 137, (6): 1003-1012.
DOI: 10.1017/S0031182009991892
Lücker J., Martens S., Lund S.T. (2010).
Characterization of a Vitis vinifera cv. Cabernet Sauvignon 3ʼ, 5ʼ-O-methyltransferase showing strong preference for anthocyanins and glycosylated flavonols.
Phytochemistry, 71, (13): 1474-1484.

DOI: 10.1016/j.phytochem.2010.05.027
MMalagnini V., Pedrazzoli F., Gualandri V., Forno F., Zasso R., Pozzebon A., Ioriatti C. (2010).
A study of the effects of Candidatus Phytoplasma mali on the psyllid Cacopsylla melanoneura (Hemiptera: Psyllidae).
Journal of Invertebrate Pathology, 103, (1): 65-67.
DOI: 10.1016/j.jip.2009.11.005
Malagnini V., Pedrazzoli F., Gualandri V., Zasso R., Bozza E., Fiamingo F., Pozzebon A., Mori N., Ioriatti C. (2010). Detection of Candidatus phytoplasma mali in different populations of Cacopsyllamelanoneura in Italy.
Bulletin of Insectology, 63, (1): 59-63.
http://www.bulletinofinsectology.org/pdfarticles/vol63-2010-059-063malagnini.pdf
Malnoy M., Borejsza-Wysocka E.E., Norelli J.L., Flaishman M., Gidoni D., Aldwinckle H. (2010). Genetic transformation of apple (Malus x domestica) without use of a selectable marker gene.
Tree Genetics & Genomes, 6, (3): 423-433.





DOI: 10.1007/s11295-009-0260-7
Marchi G., Burruano S., Di Marco S., Osti F., Pertot I., Surico G. (2009). Spatial pattern analysis of esca in different geographical areas of Italy.
Phytopathologia Mediterranea, 48, (1, special issue): 175.



http://ejour-fup.unifi.it/index.php/pm/article/viewFile/2887/2573
Mariz C., Gianelle D., Bruzzone L., Vescovo L. (2009). Fusion of multi-spectral SPOT-5 images and very high resolution texture information extracted from digital orthophotos for automatic classification of complex Alpine areas.
International Journal of Remote Sensing, 30, (11): 2859-2873.
DOI: 10.1080/01431160802558600
Martens S., Preuss A., Matern U. (2010).
Multifunctional flavonoid dioxygenases: flavonol and anthocyanin biosynthesis in Arabidopsis thaliana.
Phytochemistry, 71, (10): 1040-1049.
DOI: 10.1016/j.phytochem.2010.04.016
Mattivi F., Vrhovsek U., Masuero D., Trainotti D. (2009). Differences in the amount and structure of extractable skin and seed tannins amongst red grape varieties.
Australian Journal of Grape and Wine Research, 15, (1): 27-35.
DOI: 10.1111/j.1755-0238.2008.00027.x
Mazzoni V., Ioriatti C., Trona F., Lucchi A., De Cristofaro A., Anfora G. (2009). Study on the role of olfaction in host plant detection of Scaphoideus titanus (Hemiptera: Cicadellidae) nymphs.
Journal of Economic Entomology, 102, (3): 974-980.
DOI: 10.1603/029.102.0316
Mazzoni V., Lucchi A., Cokl A., Presern J., Virant-Doberlet M. (2009). Disruption of the reproductive behaviour of Scaphoideustitanus by playback of vibrational signals. Entomologia Experimentalis et Applicata, 133, (2): 174-185.
DOI: 10.1111/j.1570-7458.2009.00911.x
Mazzoni V., Presern J., Lucchi A., Virant-Doberlet M. (2009).
Reproductive strategy of the Nearctic leafhopper ScaphoideustitanusBall (Hemiptera: Cicadellidae).

Bulletin of Entomological Research, 99, (4): 401-413.
DOI: 10.1017/S0007485308006408
Mazzoni V., Lucchi A., Ioriatti C., Virant-Doberlet M., Anfora G. (2010).
Mating behavior of Hyalesthes obsoletus (Hemiptera: Cixiidae).
Annals of the Entomological Society of America, 103, (5): 813-822.
DOI: 10.1603/AN09145
Molinari F., Anfora G., Schmidt S., Villa M., Ioriatti C., Pasqualini E., De Cristofaro A. (2010). Olfactory activity of ethyl (E,Z)-2,4-decadienoate on adult oriental fruit moths. The Canadian Entomologist, 142, (5): 481-488.
DOI: 10.4039/n10-016
Mona S., Catalano G., Lari M., Larson G., Boscato P., Casoli A., Sineo L., Di Patti C., Pecchioli E., Caramelli D., Bertorelle G. (2010).
Population dynamic of the extinct european aurochs: genetic evidence of a north-south differentiation pattern and no evidence of post-glacial expansion.
BMC Evolutionary Biology, 10, (83)
http://www.biomedcentral.com/1471-2148/10/83
Nagendra H., Rocchini D., Ghate R. (2010). Beyond parks as monoliths: Spatially differentiating park-people relationships in the Tadoba Andhari Tiger Reserve in India. Biological Conservation, 143: 2900-2908.
DOI: 10.1016/j.biocon.2010.04.050
NNagendra H., Rocchini D., Ghate R., Sharma B., Pareeth S. (2010) Assessing biodiversity in a dry tropical forest: comparing the utility of Landsat and Ikonos satellite images.
Remote Sensing, 2, (2): 478-496.
DOI: 10.3390/rs2020478
Nardini M., Forte M., Vrhovsek U., Mattivi F., Viola R., Scaccini C. (2009). White wine phenolic are absorbed and extensively metabolized in humans. Journal of Agricultural and Food Chemistry, 57, (7): 2711‒2718.

DOI: 10.1021/jf8034463
Neteler, M. (2010).
Estimating daily Land Surface Temperatures in mountainous environments by reconstructed MODIS LST data.
Remote Sensing, 2,(1): 333-351.
DOI: 10.3390/rs1020333
Obertegger U., Borsato A., Flaim G. (2010). Rotifer-crustacean interactions in a pseudokarstic lake: influence of hydrology.
OAquatic Ecology, 44, (1): 121-130.

DOI: 10.1007/s10452-009-9285-0
Obertegger U., Thaler B., Flaim G. (2010). Rotifer species richness along an altitudinal gradient in the Alps.
Global Ecology and Biogeography, 19, (6): 895-904.
DOI: 10.1111/j.1466-8238.2010.00556.x
Paris R., Cova V., Pagliarani G., Tartarini S., Komjanc M., Sansavini S. (2009 ). Expression profiling in HcrVf2-transformed apple plants in response to Venturia inaequalis.
PTree Genetics & Genomes, 5, (1): 81-91.





DOI: 10.1007/s11295-008-0177-6
Paternoster T., Vrhovsek U., Pertot I., Duffy B., Gessler C., Mattivi F. (2009). Determination and confirmation of nicotinic acid and its analogues and derivates in pear and apple blossoms using high-performance liquid chromatography-diode array-electrospray ionization mass spectrometry.

Journal of Agricultural and Food Chemistry, 57, (21): 10038-10043.

DOI: 10.1021/jf902342b
Patocchi A., Fernandez-Fernandez F., Evans K., Gobbin D., Rezzonico F., Boudichevskaja A., Dunemann F., Stankiewicz-Kosyl M., Mathis-Jeanneteau F., Durel C.E., Gianfranceschi L., Costa F., Toller C., Cova V., Mott D., Komjanc M., Barbaro E., Kodde L., Rikkerink E., Gessler C., Van De Weg W.E. (2009).
Development and test of 21 multiplex PCRs composed of SSRs spanning most of the apple genome.

Tree Genetics & Genomes, 5, (1): 211-223.
DOI: 10.1007/s11295-008-0176-7
Pedron L., Baldi P., Hietala A.M., La Porta N. (2009).
Genotype-specific regulation of cold-responsive genes in cypress (Cupressus sempervirens L.).
Gene , 437, (1-2): 45-53.
DOI: 10.1016/j.gene.2008.12.012
Pellegrini A.1., Prodorutti D., Frizzi A., Gessler C., Pertot I. (2010).
Development and evaluation of a warning model for the optimal use of copper in organic viticulture.
Journal of Plant Pathology, 92, (1): 43-55.
Penna A., Fraga S., Battocchi C., Casabianca S., Giacobbe M.G., Riobo P., Vernesi C. (2010). A phylogeographical study of the toxic benthic dinoflagellate genus ostreopsis Schmidt.
Journal of Biogeography, 37, (5): 830-841.
DOI: 10.1111/j.1365-2699.02265.x
Perazzolli M., Bampi F., Faccin S., Moser M., De Luca F., Ciccotti A.M., Velasco R., Gessler C., Pertot I., Moser C. (2010).
Armillaria mellea induces a set of defense genes in grapevine roots and one of them codifies a protein with antifungal activity.
Molecular Plant-Microbe Interactions, 23, (4): 485-496.
DOI: 10.1094/MPMI-23-4-0485
Perini M., Camin F., Bontempo L., Rossmann A., Piasentier E. (2009). Multielement (H, C, N, O, S) stable isotope characteristics of lamb meat from different Italian regions. Rapid Communications in Mass Spectrometry, 23, (16): 2573-2585.
DOI: 10.1002/rcm.4140
Perini M., Camin F., Corradini F., Obertegger U., Flaim G. (2009). Use of δ18O in the interpretation of hydrological dynamics in lakes.

Journal of Limnology, 68, (2): 174-182.
DOI: 10.3274/JL09-68-2-02
Perkins S.E., Cagnacci F., Stradiotto A., Arnoldi D., Hudson P.J. (2009). Comparison of social networks derived from ecological data: implications for inferring infectious disease dynamics.
Journal of Animal Ecology, 78, (5): 1015-1022.
DOI: 10.1111/j.1365-2656.2009.01557.x
Poni S., Bernizzoni F., Civardi S., Gatti M., Porro D., Camin F. (2009).
Performance and water-use efficiency (single-leaf vs. whole-canopy) of well-watered and halfstressed split-root Lambrusco grapevines grown in Po valley (Italy).
Agriculture Ecosystems & Environment, 129, (1-3): 97-106.
DOI: 10.1016/j.agee.2008.07.009
Prodorutti D., De Luca F., Michelon L., Pertot I. (2009).
Susceptibility to Armillaria mellea root rot in grapevine rootstocks commonly grafted onto Teroldego Rotaliano.
Phytopathologia Mediterranea, 48, (2): 285-290.
http://ejour-fup.unifi.it/index.php/pm/article/viewFile/2738/2843


Prodorutti D., Vanblaere T., Gobbin D., Pellegrini A.1., Gessler C., Pertot I. (2009). Genetic diversity of Armillaria spp. infecting highbush blueberry in Northern Italy (Trentino region).
Phytopathology, 99, (6): 651-658.
DOI: 10.1094/PHYTO-99-6-0651
Rapisarda P., Camin F., Fabroni S., Perini M., Torrisi B., Intrigliolo F. (2010). Influence of different organic fertilizers on quality parameters and the delta N-15, delta C-13, delta H-62, delta S-34, and delta O-18 values of orange fruit (Citrus sinensis L. Osbeck).
Journal of Agricultural and Food Chemistry, 58, (6): 3502-3506.
DOI: 10.1021/jf903952v
Ricotta C., Godefroid S., Rocchini D. (2010).
Invasiveness of alien plants in Brussels is related to their phylogenetic similarity to native species. Diversity and Distribution, 16, (4): 655-662.
DOI: 10.1111/j.1472-4642.2010.00676.x
Rizzoli A., Hauffe H.C., Tagliapietra V., Neteler M., Rosà R. (2009).
Forest structure and roe deer abundance predict tick-borne encephalitis risk in Italy. PLoS ONE, 4, (2): e4336.
DOI: 10.1371/journal.pone.0004336
Rocchini, D. (2010).
Ecological status and change by remote sensing - Editorial. Remote Sensing, 2: 2424-2425.
DOI: 10.3390/rs2102424
Rocchini D., Vannini A. (2010).
What is up? Testing spectral heterogeneity versus NDVI relationship using quantile regression.
International Journal of Remote Sensing, 31, (10): 2745-2756.
DOI: 10.1080/01431160903085651
Rocchini D., He K.S., Oldeland J., Wesuls D., Neteler M. (2010) Spectral variation versus species ß-diversity at different spatial scales: a test in African highland savannas.
Journal of Environmental Monitoring, 12, (4): 825-831.

DOI: 10.1039/b921835a
Rocchini D., Balkenhol N., Carter G., Foody G.M., Gillespie T.W., He K.S., Kark S., Levin N., Lucas K., Luoto M., Nagendra H., Oldeland J., Ricotta C., Southworth J., Neteler M. (2010). Remotely sensed spectral heterogeneity as a proxy of species diversity: recent advances and open challenges.
Ecological Informatics, 5, (5): 318-329.
DOI: 10.1016/j.ecoinf.2010.06.001
Rodeghiero M., Tonolli S., Vescovo L., Gianelle D., Cescatti A., Sottocornola M. (2010).
INFOCARB: a regional scale forest carbon inventory (Provincia Autonoma di Trento, southern italian Alps).
Forest Ecology and Management, 259, (6): 1093-1101.
DOI: 10.1016/j.foreco.2009.12.019
Roiz D., Vazquez A., Seco M.P.S., Tenorio A., Rizzoli A. (2009).
Detection of novel insect flavivirus sequences integrated in Aedes albopictus (Diptera: Culicidae) in Northern Italy.
Virology Journal, 6, (93)
DOI: 10.1186/1743-422X-6-93
Roiz D., Rosà R., Arnoldi D., Rizzoli A. (2010).
Effects of temperature and rainfall on the activity and dynamics of host-seeking Aedes albopictus females in Northern Italy.
Vector-Borne and Zoonotic Diseases, 10, (8): 811-816.
DOI: 10.1089/vbz.2009.0098
Rotter A., Camps C., Lohse M., Kappel C., Pilati S., Hren M., Stitt M., Coutos-Thévenot, Moser C., Usadel B., Delrot S., Gruden K. (2009).
Gene expression profiling in susceptibile interaction of grapevine with its fungal pathogen
Eutypa lata: extending MapMan ontology for grapevine.
BMC Plant Biology, 9, (104)
DOI: 10.1186/1471-2229-9-104
SSalmaso N. (2010).
Long-term phytoplankton community changes in a deep subalpine lake: responses to nutrient availability and climatic fluctuation.
Freshwater Biology, 55, (4): 825-846.

DOI: 10.1111/j.1365-2427.2009.02325.x
Salmaso N., Zignin A. (2010).
At the extreme of physical gradients: phytoplankton in highly flushed, large rivers.

Hydrobiologia, 639, (1): 21-36.
DOI: 10.1007/s10750-009-0018-0
Salvi S.1., Castelletti S., Tuberosa R. (2009).
An updated consensus map for flowering time QTLS in maize. Maydica, 54, (4): 501-512.
http://www.maiscoltura.it/maydica/articles/54_501.pdf
Savazzini F., Longa Oliveira C.M., Pertot I. (2009).
Impact of the biocontrol agent Trichoderma atroviride Sc1 on soil microbial communities of a vineyard in Northern Italy.
Soil Biology and Biochemistry, 41, (7): 1457-1465.
DOI: 10.1016/j.soilbio.2009.03.027
Scalabrin S., Troggio M., Moroldo M., Pindo M., Felice N., Coppola G., Prete G., Malacarne G., Marconi R., Faes G., Jurman I., Grando M.S., Jesse T., Segala C., Valle G., Policriti A., Fontana P., Morgante M., Velasco R. (2010).
Physical mapping in highly heterozygous genomes: a physical contig map of the Pinot Noir grapevine cultivar.

BMC Genomics, 11, (204).
http://www.biomedcentral.com/1471-2164/11/204
Scattolin L., Montecchio L. (2009).
Lophodermium piceae and Rhizosphaera kalkhoffii Norway spruce: correlations with host age and climatic features.
Phytopathologia Mediterranea, 48, (2): 226-239.
http://ejour-fup.unifi.it/index.php/pm/article/viewFile/2789/2838
Scheirlinck I., Van der Meulen R., Vrancken G., De Vuyst L., Settanni L., Vandamme P., Huys G. (2009).
Polyphasic taxonomic characterization of Lactobacillus rossiae isolates from Belgian and Italian sourdoughs reveals intraspecific heterogeneity.
Systematic and Applied Microbiology, 32, (2): 151-156.
DOI: 10.1016/j.syapm.2008.12.006
Schellenberg A., Chmielus S., Schlicht C., Camin F., Perini M., Bontempo L., Heinrich K., Kelly S.D., Rossmann A., Thomas F., Jamin E., Horacek M. (2010).
Multielement stable isotope ratios (H, C, N, S) of honey from different European regions.
Food Chemistry, 121, (3): 770-777.

DOI: 10.1016/j.foodchem.2009.12.082
Schuck M.R., Moreira Maia F., Guerra M.P., Voltolini J.A., Grando M.S., Lima da Silva A. (2009).
Molecular characterization of grapevine from Santa Catarina, Brazil, using microsatellite markers.
Pesquisa Agropecuària Brasileira, 44, (5): 487-495.
DOI: 10.1590/S0100-204X2009000500008
Schuck M.R., Moreira Maia F., Voltolini J.A., Guerra M.P., Grando M.S., Lima da Silva A. (2010).
Molecular identification of the grapevine “Goethe” from Urussanga (Sc) with microsatellite markers. Revista Brasileira de Fruticultura, 32, (3): 825-831.
DOI: 10.1590/S0100-29452010005000093
Settanni L., Franciosi E., Cavazza A., Cocconcelli P.S., Poznanski E. (2010). Extension of Tosela cheese shelf-life using non-starter lactic acid bacteria.
Food Microbiology
DOI: 10.1016/j.fm.2010.12.003
Shen Q., Chn Y.A., Tuohy K. (2010).
A comparative in vitro investigation into the effects of cooked meats on the human faecal microbiota.
Anaerobe, 16, (6): 572-577.

DOI: 10.1016/j.anaerobe.2010.09.007
Shulaev V., Sargent D.J., Crowhurst R.N., Mockler T.C., Folkerts O., Delcher A.L., Jaiswal P., Mockaitis K., Liston A., Mane S.P., Burns P., Davis T.M., Slovin J.P., Bassil N., Hellens R.P., Evans C., Harkins T., Kodira C., Desany B., Crasta O.R., Jensen R.V., Allan A.C., Michael T.P., Setubal J.C., Celton J.-M., Rees D.J.G., Williams K.P., Holt S.H., Ruiz Rojas J.J., Chatterjee M., Liu B., Silva H., Meisel L., Adato A., Filichkin S.A., Troggio M., Viola R., Ashman T.L., Wang H., Dharmawardhana P., Elser J., Raja R., Priest H.D., Bryant Jr D.W., Fox S.E., Givan S.A., Wilhelm L.J., Naithani S., Christoffels A., Salama D.Y., Carter J., Lopez Girona E., Zdepski A., Wang W., Kerstetter R.A., Schwab W., Korban S.S., Davik J., Monfort A., Denoyes-Rothan B. , Arus P., Mittler R., Flinn B., Aharoni A., Bennetzen J.L., Salzberg S.L., Dickerman A.W., Velasco R., Borodovsky M., Veilleux R.E., Folta K.M. (2010).
The genome of woodland strawberry (Fragaria vesca).
Nature Genetics

DOI: 10.1038/ng.740
Simone I., Cagnacci F., Provensal C., Polop J. (2010).
Environmental determinants of the small mammal assemblage in an agroecosystem of central Argentina: the role of Calomys musculinus
Mammalian Biology, 75, (6): 496-509.
DOI: 10.1016/j.mambio.2009.12.002
Sottocornola M., Kiely G. (2010). Energy fluxes and evaporation mechanism in an Atlantic blanket bog in southwestern Ireland. Water Resources Research, 46, (W11524).
DOI: 10.1029/2010WR009078
Sottocornola M., Kiely G. (2010). Hydro-meteorological controls on the CO2 exchange variation in an Irish blanket bog. Agricultural and Forest Meteorology, 150, (2): 287-297.
DOI: 10.1016/j.agrformet.2009.11.013
Soukoulis C., Aprea E., Biasioli F., Cappellin L., Schuhfried E., Märk T.D., Gasperi F. (2010). Proton transfer reaction time-of-flight mass spectrometry monitoring of the evolution of volatile compounds during lactic acid fermentation of milk. Rapid Communications in Mass Spectrometry, 24, (14): 2127-2134.
DOI: 10.1002/rcm.4617
Stradiotto A., Cagnacci F., Delahay R., Tioli S., Nieder L., Rizzoli A. (2009). Spatial organization of the yellow-necked mouse: effects of density and resource availability. Journal of Mammalogy, 90, (3): 704-714.
DOI: 10.1644/08-MAMM-A-120R1.1
TTagliapietra V., Rosà R., Hauffe H.C., Laakkonen J., Voutilainen L., Vapalahti O., Vaheri A., Henttonen H., Rizzoli A. (2009).
Spatial and temporal dynamics of lymphocytic choriomeningitis virus in wild rodents, Northern Italy. Emerging Infectious Diseases, 15, (7): 1019-1025. http://www.cdc.gov/eid/content/15/7/1019.htm
Tasin M., Bäckman A.C., Anfora G., Carlin S., Ioriatti C. , Witzgall P. (2010).
Attraction of female grapevine moth to common and specific olfactory cues from 2 host plants. Chemical Senses, 35, (1): 57-64.
DOI: 10.1093/chemse/bjp082
Teuling A.J., Seneviratne S.I., Stöckli R., Reichstein M., Moors E., Ciais P., Luyssaert S., Van del Hurk B., Ammann C., Bernhofer C., Dellwik E., Gianelle D., Gielen B., Grünwald T., Klumpp K., Montagnani L., Moureaux C., Sottocornola M., Wohlfahrt G. (2010). Contrasting response of European forest and grassland energy exchange to heatwaves.
Nature Geoscience, 3, (10): 722-727.

DOI: 10.1038/NGEO950
Tioli S., Cagnacci F., Stradiotto A., Rizzoli A. (2009).
Edge effect on density estimates of a radiotracked population of yellow-necked mice.
Journal of Wildlife Management, 73, (2): 184-190.
DOI: 10.2193/2007-324
Tolotti M., Boscaini A., Salmaso N. (2010). Comparative analysis of phytoplankton patterns in two modified lakes with contrasting hydrological features.
Aquatic Sciences, 72, (2): 213-226.
DOI: 10.1007/s00027-009-0124-0
Trona F., Anfora G., Baldessari M., Mazzoni V., Casagrande E., Ioriatti C., Angeli G. (2009). Mating disruption of codling moth with a continuous adhesive tape carrying high densities of pheromone dispensers.
Bulletin of Insectology, 62, (1): 7-13.
http://www.bulletinofinsectology.org/pdfarticles/vol62-2009-007-013trona.pdf
Trona F., Anfora G., Bengtsson M., Witzgall P., Ignell R. (2010). Coding and interaction of sex pheromone and plant volatile signals in the antennal lobe of the codling moth Cydia pomonella.
The Journal of Experimental Biology, 213: 4291-4303.

DOI: 10.1242/jeb.047365
Trona F., Casado D., Coracini M., Bengtsson M., Ioriatti C., Witzgall P. (2010). Flight tunnel response of codling moth Cydia pomonella to blends of codlemone, codlemone antagonists and pear ester.
Physiological Entomology, 35, (3): 249-254.
DOI: 10.1111/j.1365-3032.2010.00737.x
Tränkner C., Lehmann S., Hoenicka H., Hanke M.V., Fladung M., Lenhardt D., Dunemann F., Gau A., Schlangen K., Malnoy M., Flachowsky H. (2010).
Over-expression of an FT-homologous gene of apple induces early flowering in annual and perennial plants.
Planta, 232, (6): 1309-1324.
DOI: 10.1007/s00425-010-1254-2
Urbano F., Cagnacci F., Calenge C., Dettki H., Cameron A., Neteler M. (2010).
Wildlife tracking data management: a new vision.
Philosophical Transactions of the Royal Society B-Biological Sciences, 365, (1550): 2177-2185.
DOI: 10.1098/rstb.2010.0081
Vaccari I., Martinelli L. (2009).
Evaluation of the phosphomannose isomerase-based selection system for gene transfer in grape.
Vitis, 48, (3): 137-144.
http://www.vitis-vea.de/admin/volltext/w1 09 1299.pdf

Velasco R., Zharkikh A., Affourtit J., Dhingra A., Cestaro A. , Kalyanaraman A., Fontana P., Bhatnagar
S.K., Troggio M., Pruss D., Salvi S.1., Pindo M., Baldi P., Castelletti S., Cavaiuolo M., Coppola G., Costa
F., Cova V., Dal Ri A., Goremykin V., Komjanc M., Longhi S., Magnago P., Malacarne G., Malnoy M., Micheletti D., Moretto M., Perazzolli M., Si-Ammour A., Vezzulli S., Zini E., Eldredge G., Fitzgerald
L.M., Gutin N., Lanchbury J., Macalma T., Mitchell J.T., Reid J., Wardell B., Kodira C., Chen Z., Desany
B., Niazi F., Palmer M., Koepke T., Jiwan D., Schaeffer S., Krishnan V., Wu C., Chu V.T., King S.T., Vick
J., Tao Q., Mraz A., Stormo A., Stormo K., Bogden R., Ederle D., Stella A., Vecchietti A., Kater M.M., Masiero S., Lasserre P., Lespinasse Y., Allan A.C., Bus V., Chagne D., Crowhurst R.N., Gleave A.P., Lavezzo E., Fawcett J.A., Proost S., Rouze P., Sterck L., Toppo S., Lazzari B., Hellens R.P., Durel C.E., Gutin A., Bumgarner R.E., Gardiner S.E., Skolnick M., Egholm M., Van de Peer Y., Salamini F., Viola R. (2010).
The genome of the domesticated apple (Malus x domestica Borkh.).
Nature Genetics, 42, (10): 833-839.
DOI: 10.1038/ng.654
Yi C., Ricciuto D., Li R., Wilbeck J., Xu X., Nilsson M., Aires L., Albertson J.D., Ammann C., Altaf Arain M., De Araujo A.C., Aubinet M., Aurela M., Barcza Z., Barr A., Berbigier P., Beringer J., Bernhofer C., Black A.T., Bolstad P.V., Bosveld F.C., Broadmeadow M.S.J., Buchmann N., Burns S.P., Cellier P., Chen J., Chen J., Ciais P., Clement R., Cook B.D., Curtis P.S., Dail D.B., Dellwik E., Delpierre N., Desai A.R., Dore S., Dragoni D., Drake B.G., Dufrene E., Dunn A., Elbers J., Eugster W., Falk M., Feigenwinter C., Flanagan L.B., Foken T., Frank J., Fuhrer J., Gianelle D., Goldstein A.H., Goulden M., Granier A., Grünwald T., Gu L., Guo H., Hammerle A., Han S., Hanan N.P., Haszpra L., Heinesch B., Helfter C., Hendriks D., Hutley L.B., Ibrom A., Jacobs C., Johansson T., Jongen M., Katul G., Kiely G., Klumpp K., Knohl A., Kolb T., Kutsch W.L., Lafleur P., laurila T., Leuning R., Lindroth A., Liu H., Loubet B., Manca G., Marek M., Margolis H.A., Martin T.A., Massman W.J., Matamala R., Matteucci G., McCaughey H., Merbold L., Meyers T., Migliavacca M., Miglietta F., Misson L., Mölder M., Moncrieff J., Monson R.K., Montagnani L., Montes Helu M., Moors E., Moureaux C., Mukelabai M.M., Munger J.W., Myklebust M., Nagy Z., Noormets A., Oechel W., Oren R., Pallardy S.G., U K.T.P., Pereira J.S., Pilegaard K., Pintér K., Pio C., Pita G., Powell T.L., Rambal S., Randerson J.T., Von Randow C., Rebmann C., Rinne J., Rossi F., Roulet N., Ryel R.J., Sagefors J., Saigusa N., Sanz M.J., Scarascia Mugnozza G.T., Schmid H.P., Seufert G., Siqueira M., Soussana J.F., Starr G., Soutton M.A., Tenhunen J., Tuba Z., Tuovinen J.P., Valentini R., Vogel C.S., Wang J., Wang S., Wang W., Welp L.R., Wen X., Wharton S., Wilkinson M., Williams C.A., Wohlfahrt G., Yamamoto S., Yu G., Zampedri R., Zhao B., Zhao X. (2010).
Climate control of terrestrial carbon exchange across biomes and continents.
Environmental Research Letters, 5, (3): art. n. 034007.
DOI: 10.1088/1748-9326/5/3/034007
Yuan W., Liu S., Yu G., Bonnefond J.M., Chen J., Davis K., Desai A.R., Goldstein A.H., Gianelle D., Rossi F., Suyker A.E., Verma S.B. (2010).
Global estimates of evapotranspiration and gross primary production based on MODIS and global meteorology data.
Remote Sensing of Environment, 114, (7): 1416-1431.
DOI: 10.1016/j.rse.2010.01.022
Zamboni A., Gatto P., Cestaro A., Pilati S., Viola R., Mattivi F., Moser C., Velasco R. (2009).
Grapevine cell early activation of specific responses to DIMEB, a resveratrol elicitor.
BMC Genomics, 10, (363)






DOI: 10.1186/1471-2164-10-363

Zini E., Clamer M., Passerotti S., Vender C., Vendramin G.G., Komjanc M. (2009). Eight novel microsatellite DNA markers in Rhodiola rosea L. Conservation Genetics, 10, (5): 1397-1399.
DOI: 10.1007/s10592-008-9704-0
Zolezzi G., Bellin A., Bruno M.C., Maiolini B., Siviglia A. (2009). Assessing hydrological alterations at multiple temporal scales: Adige River, Italy.
Water Resources Research, 45, (W12421)
DOI: 10.1029/2008WR007266
Zulini L., Fischer C., Bertamini M. (2010). Chlorophyll fluorescence as a tool for evaluation of viability in freeze-stressed grapevine buds. Photosynthetica, 48, (2): 317-319.
http://www.springerlink.com/content/15vjj775406j182u/fulltext.pdf








Bavaresco L., Fregoni C., van Zeller de Macedo Basto Goncalves M.I., Vezzulli S. (2009). Physiology & molecular biology of grapevine stilbenes: an update.
In: Grapevine Molecular Physiology & Biotechnology (editor K.A. Roubelakis - Angelakis).
BDordrecht: Springer: 341-364.
http://dx.doi.org/10.1007/978-90-481-2305-6_12
Bertorelle G., Bruford M.W., Hauffe H.C., Rizzoli A., Vernesi C. (editors) (2009).
Population genetics for animal conservation.
Cambridge: Cambridge University Press (Conservation Biology 17): xi, (2): 395 p.




ISBN 978-0-521-68537-5.
Bertorelle G., Papetti C., Hauffe H.C., Boitani L. (2009). Monitoring and detecting translocations using genetic data.
In: Population Genetics for Animal Conservation (editors G. Bertorelle et al.).
Cambridge: Cambridge University Press. (Conservation Biology 17): 148-166.

Conterno L., Henick-Kling T. (2010). Brettanomyces/Dekkera off-flavours and other wine faults associated with microbial spoilage.

In: Managing wine quality (editor A.G. Reynolds).

Woodhead publishing limited: Cambridge. (Woodhead Publishing Series in Food Science, Technology and Nutrition 192): 346-387.
ISBN 978-1-84569-798-3
Costantini L., Moreira Maia F., Zyprian E., Martinez-Zapater J.M., Grando M.S. (2009). Molecular maps, QTL mapping & association mapping in grapevine.
In: Grapevine molecular physiology & biotechnology (editor K.A. Roubelakis - Angelakis).
Dordrecht: Springer: 535-563. http://dx.doi.org/10.1007/978-90-481-2305-6_20
Cristofolini F., Brunialti G., Giordani P., Ferretti M. (editors) (2010). Towards an international standard for lichen monitoring: theory and practice: presentations given at the harmonization field course: 7-11 June 2010.
San Michele allʼAdige (TN): Fondazione Edmund Mach: 95 p.

ISBN 978-88-7843-0320.
Delrot S., Medrano H., Or E., Bavaresco L., Grando M.S. (editors) (2010). Methodologies and results in grapevine research.

Dordrecht: Springer: xvii: 448 p.
ISBN 978-90-481-9282-3.
DOI: 10.1007/978-90-481-9283-0
Frisullo S., Carlucci A., Lops F., Michelon L., Pellegrini C., Pertot I., Quaglia M., Zazzerini A., Serra S., Mannoni M.A., Ligios V., Demontis A. (2010).
Forme di svernamento dei funghi dellʼesca, fonti dellʼinoculo, recettivitá delle ferite.

In: Il mal dellʼesca della vite: interventi di ricerca e sperimentazione per il contenimento della malattia: progetto MesVit. Firenze: Arsia: 104-121.
ISBN 978-88-8295-115-3
Gandolfi A., Ciutti F., Gandolfi G., Nonnis Marzano F. (editors) (2010).
Atti del XII congresso nazionale dellʼAssociazione italiana ittiologi acque dolci: 6-7 giugno 2008, San Michele allʼAdige (TN).
Trento: Museo tridentino di scienze naturali (Studi trentini di scienze naturali 87): 276 p.
Giongo L., Grisenti M., Saviane A., Mattivi F., Vrhovsek U., Camin F., Bontempo L., Perini M., Eccher M., Kroll K., Zuin N., Mazzalai M., Mladin P., Danek J. (2010). A berries varieties handbook: phenotyping for the fresh market use.
San Michele allʼAdige (TN): Fondazione Edmund Mach: 351 p.
ISBN 978-88-7843-030-3.
Grando M.S. (2010). Miglioramento genetico.
In: Lʼuva da tavola. Milano: Bayer Cropscience (Coltura & Cultura): 375-385. ISBN 9788896301098
Grando M.S., Lorenzi S., Moreira Maia F., Vouillamoz J. (2010). Marzemino: quale origine? Una lettura genetica.
In: Tornata Marzemino un nobile trentino: Accademia Italiana della Vite e del Vino. Rovereto (TN): Museo di arte moderna e contemporanea di Trento e Rovereto: 17-22.
Gretter A., Goio I., Gios G. (2010).
Beyond commons: new perspectives and role for common properties.
In: Localeconomiesandglobalcompetitiveness(editors B. Dallago, C. Guglielminetti). Basingstoke: Palgrave Macmillan: 175-189.
ISBN 9780230252721
Gretter A., Marelli B., Orsatti C., Scolozzi R. (2010).

Studiare le interdipendenze tra uomo e ambiente: prospettive multidisciplinari per il caso di studio della valle di Ledro (Trento).
In: Alpi e ricerca: proposte e progetti per i territori alpini (editors F. Corrado, V. Porcellana).
Milano: Angeli (Uomo, Ambiente, Sviluppo): 216-225.
ISBN 9788856835151
L M
Hauffe H. C., Sbordoni V. (2009).
Introduction.
HIn: Population Genetics for Animal Conservation (editors Bertorelle G., Bruford M. W., Rizzoli A., Hauffe H. C., Vernesi C.). Cambridge University Press: 1-21.
Hofierka J., Mitàsovà H., Neteler M. (2009). Geomorphometry in GRASS GIS.
In: Geomorphometry: concepts, software, applications (editors T. Hengl, I.H. Reuter). Amsterdam: Elsevier. (Developments in soil science 33): 387-410.
http://dx.doi.org/10.1016/S0166-2481(08)00017-2
Longa Oliveira C. M., Savazzini F., Pertot I. (2009). Monitoramento de Trichoderma atroviride SC1 em um vinhedo no nordeste da Italia: consideraçoes sobre impacto ambiental e controle biologico de Armillaria mellea, p. 173-186.
In: Biocontrole de Doenças de Plantas: Uso e Perspectivas (editors Bettiol W., Morandi, M.A.B.). Embrapa Meio Ambiente, Sao Paulo, Brasil: 341p.
Malnoy M., Aldwinckle H.S. (2009). Apple transformation and translational genomics.

In: Genetics and genomics of Rosaceae (editors K.M. Folta, S.E. Gardiner). New York, NY: Springer: 143-162.
http://dx.doi.org/10.1007/978-0-387-77491-6_7
Marchetto A., Rogora M., Boggero A., Musazzi S., Lami A., Lotter A., Tolotti M., Thies H., Psenner R., Massaferro J., Barbieri A. (2009).
Response of Alpine lakes to major environmental gradients, as detected through planktonic, benthic and sedimentary assemblages.
In: Patterns and factors of biota distribution in remote european mountain lakes (editors J. Catalan, C.J. Curtis, M. Kernan). Stuttgart: Schweizerbartʼsche Verlagsbuchhandlung. (Advances in Limnology 62): 419-440.
Marchi G., Burruano S., Di Marco S., Osti F., Pertot I., Surico G. (2010). Analisi statistica della distribuzione spaziale del mal dellʻesca della vite in alcuni vigneti spaziali.
In: Il mal dellʻesca della vite : interventi di ricerca e sperimentazione per il contenimento della malattia: progetto MesVit. Firenze: Arsia: 191-203.
ISBN 978-88-8295-115-3
Martinelli L. (2010). Recombinant DNA.
In: Encyclopedia of science and technology communication (editors S. Hornig Priest). Los Angeles: SAGE. 2: 623-626.
ISBN 978-1-4129-5920-9.
Martinelli L., Gribaudo I. (2009).
Strategies for effective somatic embryogenesis in grapevine: an appraisal.


In: Grapevine molecular physiology & biotechnology (editor K.A. Roubelakis - Angelakis). Dordrecht: Springer: 461-493.
http://dx.doi.org/10.1007/978-90-481-2305-6_17
Michelon L., Pellegrini C., Pertot I. (2010). Il mal dellʼesca della vite in Trentino.
In: Il mal dellʼesca della vite : interventi di ricerca e sperimentazione per il contenimento della malattia: progetto MesVit. Firenze: Arsia: 182-183.
NISBN 978-88-8295-115-3
Neteler M. (2010).
Open source Geospatial Foundation.
In: The Encyclopedia of geography (editor B. Warf). London: SAGE Publications. 4: 2088-2089.
ISBN 9781412956970
Neteler M. (2010).
Open source GIS.



In: The Encyclopedia of geography (editor B. Warf). London: SAGE Publications. 4: 2090-2091.
ISBN 9781412956970
Markus Neteler and Helena Mitasova (Translated by Tetsuji Uemura), (2009)
Open Source GIS: A GRASS GIS Approach.






Third Edition ‒ Japanese Version: 467.
ISBN-10: 4759101276, ISBN-13: 978-4759101270





Pertot I. (2009).
Principi attivi antiperonosporici.
In: Peronospora della vite (editor P. Balsari). Calosso (AT): Edizioni Vit.En.: 76-79.
Rodeghiero M., Heinemeyer A., Schrumpf M., Bellamy P. (2009). Determination of soil carbon stocks and changes.
In: Soilcarbondynamics:anintegratedmethodology (editors W. Kutsch, M. Bahn, A. Heinemeyer).
Oxford: Cambridge University Press: 49-75.
Salmaso N., Tolotti M. (2009).
Other phytoflagellates and groups of lesser importance.
In: Encyclopedia of inland waters (editor G.E. Likens). Oxford: Elsevier 1: 174-183.

P R S
Scienza A., Mariani L., Failla O., Brancadoro L., Toninato L., Cricco J., Bacchiega D., Zappata A., Monterisi L., Marangon A., Dalla Rosa A., Garlato A., Sartori G. , Porro D., Penner F., Larcher R., Nicolini G.G.F., Mattivi F. (2010).
La zonazione della DOC Terradeiforti: manuale dʼuso del territorio.
Legnaro (PD): Veneto Agricoltura: 151 p.
ISBN 978-88-6337-046-1.
Sosinski B., Shulaev V., Dhingra A., Kalyanaraman A., Bumgarner R., Rokhsar D., Verde I., Velasco R., Abbott A.G. (2009).
Rosaceous genome sequencing: perspectives and progress.
In: Genetics and genomics of Rosaceae (editors K.M. Folta, S.E. Gardiner). New York, NY: Springer: 601-615.
Stefanini M., Tomasi T. (2010).
Antichi vitigni del Trentino.
San Michele allʼAdige (TN): Fondazione Edmund Mach: 271 p.
ISBN 978-88-7843-032-7.
Straškràbovà V., Bertoni R., Blažo M., Callieri C., Forsström L., Fott J., Kernan M., Macek M., Stuchlik E., Tolotti M. (2009).
Structure of pelagic microbial assemblages in european mountain lakes during ice-free season.
In: Patterns and factors of biota distribution in remote european mountain lakes (editors J. Catalan, C.J. Curtis, M. Kernan). Stuttgart: Schweizerbartʼsche Verlagsbuchhandlung (Advances in Limnology 62): 19-53.
Tolotti M., Forsström L., Morabito G., Thaler B., Stoyneva M., Cantonati M., Šiško M., Lotter A. (2009). Biogeographical characterisation of phytoplankton assemblages in high altitude and high latitude European lakes.
In: Patterns and factors of biota distribution in remote european mountain lakes (editors J. Catalan, C.J. Curtis, M. Kernan). Stuttgart: Schweizerbartʼsche Verlagsbuchhandlung. (Advances in Limnology 62): 55-75.
Vernesi C., Bruford M.W. (2009).
Recent developments in molecular tools for conservation.
In: Population genetics for animal conservation (editors G. Bertorelle et al.). Cambridge: Cambridge University Press. (Conservation Biology 17): 321-344.
T
V














Viola Roberto
direttore
del CENTRO RICERCA E INNOVAZIONE segreteria
Esposito Elisabetta
Maffei Roberto
Unità amministrativa e Valorizzazione della Ricerca
AMMINISTRAZIONE / Agostini Romina | Barbacovi Daniele | Chini Sabrina | Conter Luigi Lona Silvana | Losa Annalisa | Marin Floriana | Paternoster Genny | Tait Laura | Tonazzolli
Giorgio | Trapin Eleonora
SUPPORTO / Boccardi Francesco | Cappelletti Emiliano | Coser Paola | Facchinelli
Michela | Greco Giulio | Maffei Stefano | Pedrotti Sonia | Turrina Loredana
AMMINISTRAZIONE / Bacca Manuela | Caset Marisa | Chincarini
Roberto | Gramazio Tiziana | Pedrotti Alice | Pezzè Luca | Saracino
Fiorella | Sebastiani Daniele
SUPPORTO / Cossa Alberto | Elisabeth Agostinho
Salamini Francesco / Direttore del Programma Internazionale di Dottorato GMPF (fino al 30 settembre 2009)
Viola Roberto / Direttore del Programma Internazionale di Dottorato GMPF (dal 1 ottobre 2009)
SEGRETERIA GMPF / Piaia Elisa | Perini Elisabetta | Wehrens-Kunne Odilia | Zecca Daniela
Rizzoli Annapaola / Responsabile Area Ambiente e Risorse naturali e Programma Cambiamenti Climatici: Impatti e Adattamenti
→ Salmaso Nico / Responsabile Programma Biocomplessità e Dinamiche degli Ecosistemi
→ Varotto Claudio / Responsabile Programma Biodiversità ed Ecologia Molecolare
→ Neteler Markus / Responsabile Piattaforma GIS e Remote Sensing
→ Eccel Emanuele / Responsabile Piattaforma Modellistica Climatologica
RICERCATORI / Cagnacci Francesca | Cerasino Leonardo | Cristofolini Fabiana | Flaim Giovanna | Gandolfi Andrea | Gianelle Damiano | Gottardini Elena | Hauffe Heidi | La Porta Nicola | Marcolla Barbara | Obertegger Ulrike | Pecchioli Elena | Rodeghiero Mirco | Rosà Roberto | Tolotti Monica | Zorer Roberto
TECNOLOGI / Boscaini Adriano | Eccel Emanuele | Frizzera Lorenzo | Rosso Fausta | Tagliapietra Valentina | Tonolli Sergio
TECNICI / Cavagna Mauro | Girardi Matteo | Leonardi Gino | Pinamonti Vigilio | Ress Lorena | Sansoni Claudio | Tarter Milva | Tomasi Mirco | Viola Maria Cristina | Zampedri Roberto | Zampedri Andrea
RICERCATORI / Bruno Maria Cristina | Maiolini Bruno | Vernesi Cristiano | Vescovo Loris
RICERCATORI A CONTRATTO / Bolzoni Luca | Carolli Mauro | Carpi Giovanna | Cau Piero | Cordano Emanuele | Crestanello Barbara | DʼAlelio
Domenico | Dalponte Michele | Detassis Carlo | Delucchi Luca | Fior Simone | Gazzani Silvia | Gratton Paolo | Konecny Adam | Li Mingai | Marelli
Beatrice | Martinez Cristina | Meraner Andreas | Ometto Lino | Orsatti Cristina | Rocchini Duccio | Roiz David | Scalfi Marta | Scolozzi Rocco | Silveri
Luana | Sottocornola Matteo
TECNOLOGI / Barbaro Enrico | Cristofori Antonella | Gretter Alessandro
TECNICI / Arnoldi Daniele | Bertoldi Alessio | Castellani Cristina | Cornetti Luca | Merlo Nicola | Predelli Mattia | Ronchetti Jessica Varolo Elisa | Zeni Simone
BORSISTI / Gori Yuri
DOTTORANDI/ Centis Barbara
staff permanente
RICERCATORI / Cestaro Alessandro | Fontana Paolo
RICERCATORI / Bianco Luca | Goremykin Vadim | Scholz Matthias Uwe | Wehrens Herman Ronald Maria Johan
TECNOLOGI / Cattani Andrea | Frizzi Andrea
TECNICI / Moretto Marco
DOTTORANDI/ Dong Yonghui | Potenza Emilio | Shahaf Nir | Shivani Shivani
Velasco Riccardo / Responsabile Area Genomica e Biologia Vegetale e Programma Genomica Strutturale e Funzionale
→ Grando Maria Stella / Responsabile Programma Genetica Molecolare Applicata
→ Pertot Ilaria / Responsabile Programma Interazioni tra Pianta e Ambiente
→ Martinelli Lucia / Responsabile Piattaforma Genomica Funzionale
→ Stefanini Marco / Responsabile Piattaforma Mantenimento del Germoplasma e Collezioni di materiali pre-breeding
→ Pindo Massimo / Responsabile Piattaforma Sequenziamento e Genotipizzazione ad Alta Resa
RICERCATORI / Baldi Paolo | Ciccotti Anna Maria | Komjanc Matteo | Malnoy Mickael | Moser Claudio | Perazzolli Michele | Si Ammour Azeddine | Troggio Michela | Vezzulli Silvia | Zulini Luca
TECNOLOGI / Giongo Lara | Magnago Pierluigi
TECNICI / Dallaserra Monica | Dorigatti Cinzia | Fontanari Marco | Poletti Valentino | Prada Germano | Tomasi Tiziano | Zatelli Alessandra
SUPPORTO / Battocletti Ivana | Bertolini Emanuele | Deromedi Marco | Lona Emma | Rossi Carlo
RICERCATORI / Anfora Gianfranco | Battilana Juri | Campisano Andrea | Costantini Laura | Dagostin Silvia | Longa Claudia Maria | Mazzoni Valerio | Palmieri Luisa | Pilati Stefania | Zini Elena
RICERCATORI A CONTRATTO / Asquini Elisa | Bengtsong Martin Jonas | Caffarra Amelia | Costa Fabrizio | Cova Valentina | De Paoli Emanuele | Giacomelli Lisa | Maene Marion | Malacarne Giulia | Maurhofer Monika | Palmieri Maria Cristina | Salvi Silvio | Tasin Marco | Todesco Sara | Tosi Lorenzo | Trona Federica | Vincenot Lucie
TECNOLOGI / Bisognin Claudia | Coppola Giuseppina | Dalla Costa Lorenza | Decarli Elisa | Maia Moreira Flavia | Martinatti Paolo
TECNICI / Bozza Elisa | Chini Isaac | Filippi Raffaele | Grisenti Marcella | Larger Simone | Leonardelli Elisabetta | Mandolini Marco | Micheli Susanna | Nicolini Daniela | Pancher Michael | Pellegrini Alberto | Pellegrini Chiara | Piazza Stefano | Sicher Carmela | Sordo Maddalena | Stefani Erica | Zambanini Jessica
SUPPORTO / Clementi Silvano | Dagostin Silvia | Giovannini Oscar | Leoni Veronica | Ress Denise | Valentini Franca
DOTTORANDI / Angeli Dario | Castelletti Sara | Cavaiuolo Marina | Coller Emanuela | Corneo Paola Elisa | Dal Ri Antonio | Granato Laura | Emanuelli Francesco | Eriksson Anna | Lashbrooke Justin | Leonardelli Lorena | Longhi Sara | Micheletti Diego
| Miolli Giulia Valentina | Nikiforova Svetlana | Paternoster Thomas | Righetti Laura | Rigosi Elisa | Rinaldi Monica Fernanda |
Roatti Benedetta | Wolters Pieter Jacobus
TIROCINANTI / Bailoni Massimo | Baldo Giordana | Beozzo Marco | Biasi Antonio | Brazzale Daniele | Casagranda Nicola | Cavalli Diego | Cestari Giacomo | Cont Massimiliano | Dapraʼ Federica | De Mattia Fabrizio | Domingues Garcia M. Del Carmen
| Ezzahi Bahcine | Gatto Pamela | Geir K. Knudsen | Giovannini Oscar | Guidon Renato | Hoyny Fabian | Kusstatscher Natashia
| Ibarra Lucia | Lasserre Pauline | Maccari Jenny | Maiellaro Isabella | Maistri Simone | Mraihi Mohamed | Pardatscher Franz
| Pedron Renato | Pedrotti Moreno | Perenzoni Andrea | Pinelli Luca | Roccaforte Vincenzo | Storari Michelangelo | Telch
Samuel | Vesentini Damiano | Zanotti Tania.
Mattivi Fulvio / Responsabile Area Qualità Alimentare e Nutrizione e Programma Qualità, Nutrizione e Tracciabilità
→ Cavazza Agostino / Responsabile Programma Tecnologie Alimentari Innovative
→ Gasperi Flavia / Responsabile Programma Qualità Sensoriale e Scelta del Consumatore
→ Vrhovsek Urska / Responsabile Piattaforma Tecnologica Profiling Metabolico
→ Camin Federica / Responsabile Piattaforma Tecnologica Analisi Isotopiche
RICERCATORI / Aprea Eugenio | Biasioli Franco | Bontempo Luana | Poznanski Elisa
TECNOLOGI / Carlin Silvia | Masuero Domenico | Sanchez Cova Carla | Simoni Marco
Tonon Agostino | Ziller Luca
SUPPORTO / Calovi Stefano
RICERCATORI / Martens Stefan | Palmieri Luisa | Theodoridis Georgios | Tuohy Kieran
RICERCATORI A CONTRATTO / Barros do Carvalho Elisabete | Caputi Lorenzo | Conterno Lorenza | Demattè Maria Luisa | Franceschi Pietro | Gkika Eleni | Panagiotis Arapitsas | Soukoulis Christos
TECNOLOGI / Endrizzi Isabella | Mattevi Monica | Van Leeuwen Katryna
TECNICI / Angeli Andrea | Betta Emanuela | Fabris Alessandra | Monfredini Luca | Pellegrini Daniele | Perzolli Stefano | Perenzoni Daniele | Petri Nora
DOTTORANDI / Cappellin Luca | Corollaro Maria Laura | Fortes Gris Eliana | Ferreira Eduardo Antonio | Franciosi Elena | Gasperotti Mattia | Hernandez-Jimenez Alberto
TIROCINANTI / Andreatta Elena | Anesin Giulia | Bottarel Andrea | Budic-Leto Irena | Cariolato Diego | Casiello Grazia | Corda Antonella | DʼUrso Maria Giuseppina | Ferrigno Antonella | Filippi Alessandro | Locci Stefano | Longobardi Francesco | Oliosi Luca | Pavana Silvia | Scartezzini Verena | Schuhfried Erna | Simeoni Federico | Steiner Bettina | Vanzo Andreja
Uomini 52% [128]
Dati sul personale
Donne 48% [118]
Italiani 85% [208] Stranieri 15% [38]
permanenti 38% [93]
a contratto 62% [153] Report 09 / 10
da 23 diversi paesi
119 Focus on part_8 Organigramma
REPORT 2009 / 2010
Centro Ricerca e Innovazione
Fondazione Edmund Mach
© 2011 Fondazione Edmund Mach, Via E. Mach 1, 38010 San Michele allʼAdige (TN) - Italia La riproduzione anche parziale dei presenti materiali è vietata senza autorizzazione scritta.
Report Editors
Floriana Marin | Alessandro Gretter | Cristina Castellani
Comitato di Redazione
Roberto Viola | Riccardo Velasco | Fulvio Mattivi | Annapaola Rizzoli | Ilaria Pertot | Heidi C. Hauffe
Graphic Design
Kinè s.c.s [M. Maroni | L. Stanga | supporto: E. Vinciguerra]
Photography
Massimo Brega - The Lighthouse (ad eccezione di pag. 66-67 © FLPA/The Lighthouse)
Cover
Cranach Lucas il Vecchio (1472-1553): Adamo ed Eva in Paradiso, 1533. Berlino, Gemaeldegalerie, Staatliche Museen zu Berlin.
Olio su tavola di faggio, 51.3 x 35.5 cm. Inv. 566.
Foto: Joerg P. Anders.© 2011. Foto Scala, Firenze/BPK, Bildagentur fuer Kunst, Kultur und Geschichte, Berlin
Stampa
Litotipografia Alcione